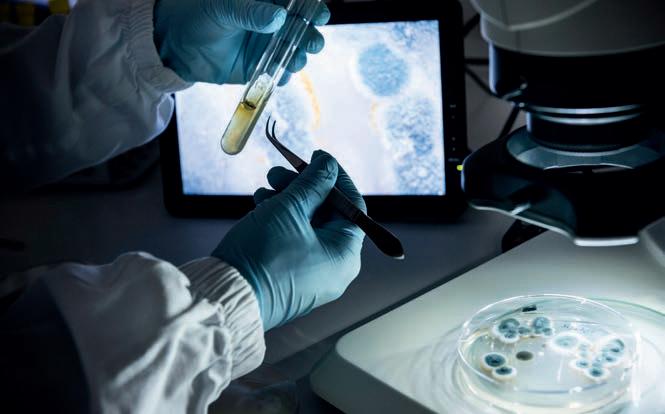

Relazione agraria & forestale 2023


![]()


in qualità di nuovo Assessore provinciale all’Agricoltura, Forestee Turismo, è per me un grande piacere presentarvi le Relazioni agrariee forestali 2023 della Provincia Autonoma di Bolzano. Questo documentooffre una panoramicacompleta sulla situazione attuale della nostra agricoltura e silvicoltura, due pilastri fondamentali che affondano lelororadici nella storia del nostro territorio e svolgono un ruolo imprescindibile per la nostra provincia.
L’agricoltura in Alto Adigeè molto più di un semplice settore economico. È una testimonianza viva della nostra storia e un elemento essenziale del nostro patrimonio culturale. I nostri agricoltori contribuiscono non solo a garantire l’approvvigionamento regionale di alimenti di alta qualità, ma anche a preservare il nostro paesaggio culturale unico, dai frutteti e vigneti nelle valli fino agli alpeggiin alta montagna Essisono i custodi del nostro spazio rurale, la cui cura e sviluppo sono di inestimabile valore per le generazioni future.
Le nostre foreste, che coprono circa la metà della superficie provinciale, svolgono una molteplicità di funzioni
Come foreste di protezione, ci proteggono da pericolinaturali come valangheederosione e tutelanole nostre infrastrutture. Inoltre, offrono un habitat prezioso per la fauna selvatica e fungono da area ricreativa per la popolazione. L’importanza delle foreste non può essere sottovalutata, sia per la protezione della natura che per la qualità della vita delle persone. Nel mio ruolo di Assessore provinciale all’Agricoltura, Forestee Turismo, vedo quotidianamente quanto questi tre settori siano strettamente interconnessi. L’agricoltura e la silvicoltura contribuiscono in modo significativo all’attrattività dell’Alto Adige come destinazione turistica. Allo stesso tempo, le imprese turistiche offrono nuovi mercati agli agricoltori e rafforzano l’economia circolare locale Attraverso la stretta collaborazione di questi settori, creiamo un’offerta turisticaautentica e sostenibile, che rende l’Alto Adige così unico.
Nonostantetutti questi aspetti positivi, ci troviamo di fronte a sfide con-

siderevoli La problematica dellupo è un tema centrale che preoccupa l’agricoltura di montagna L’abbassamento dello status di protezione dellupo a livello europeo potrebbe alleviare questa situazione, offrendo maggiore sicurezza agli agricoltori e al loro bestiame. Anche la diminuzione della produzione di latte cipreoccupa Sono necessarie migliori condizioni quadro per garantire il futuro dell’allevamento e della produzione di latte. Inoltre, la crescente burocrazia non solo rappresenta una sfida per le aziende agricole, ma anche per l’amministrazione provinciale stessa, che deve affrontare nuove normative statali ed europee. La Politica Agricola Comune, conle sue varie forme di erogazione dei contributi, gioca un ruolo fondamentale per l’agricoltura di montagna I ritardi nei pagamenti devono essere assolutamenteevitati in futuro per garantire agli agricoltori pianificazione e prospettive. Nel settore della silvicoltura, il mio obiettivo è contribuire alla creazione di una nuova consapevolezza sull’importanza delle nostre foreste. Eventi come la tempesta Vaia, gli schianti boschivi da vento e neve, l’infestazione da bostrico e il riscaldamento climatico in generale hanno danneggiato fortemente le foreste dell’Alto Adige. Sono quindi necessari grandi sforzi perripristinare le foreste danneggiate e garantire le loro molteplici funzioni per il futuro Ciò richiede non solo risorse tecniche e finanziarie, ma anche una profonda comprensione e un forte impegno da parte di tutta la popolazione. La riforestazione, la cura e la protezione delle nostre foreste devono essere obiettivi comuni. Penso in particolare ai giovani, che negli ultimi anni hanno chiesto con sempre
maggiore insistenza una protezione coerente della natura e dell’ambiente per sestessi e per le generazioni future.
Queste sono solo alcune delle sfide che dovremo affrontare nei prossimi anni. Negli ultimi decenni, grazie a una politica saggia e lungimirante, siamo riusciti a mantenere vivo lo spazio rurale Mentre in alcune regioni d’Europa si è verificato un vero e proprio spopolamento delle aree rurali, il territorio rurale altoatesinooffre ancora oggi una buona base di vita per la popolazione. Continuare a rafforzare lo spazio rurale è uno dei miei obiettivi principali per i prossimi anni. Sono fiducioso che insieme sapremo cogliere le opportunità di cambiamento positivo.
In conclusione, desidero ringraziare tutti gli agricoltori e allevatori impegnati della nostra provincia, i forestali, gli apicoltori, i cacciatori, i pescatori, le associazioni agricole e forestali, nonché tutti i nostri partner. Un grande ringraziamento va anche ai collaboratori dell’amministrazione provinciale e ai nostri istituti di ricerca. Continuiamo a lavorare con determinazione per uno sviluppo sostenibile dellanostra agricoltura e silvicoltura.
Vi auguro una lettura interessante delle pagine seguenti, che offrono una buona panoramica sull’agricoltura e la silvicoltura in Alto Adigee sulle sfide e opportunità che affrontiamo insieme.
Cordialmente, Luis Walcher
Assessore provinciale all’Agricoltura, Forestee Turismo

2.4.1Programma
2.4.2
2.5.3
2.5.4Istituto della Salute delle piante
2.5.5 Istituto di Chimica Agraria e Qualità Alimentare
2.5.6 Istituto di Agricoltura Montana e Tecnologie Alimentari
2.6 La Facoltà di Scienze agrarie, ambientali e alimentati
2.6.1 Risposta della vite alle ondate di calore estive
2.6.2 Prima valutazione della praticità del protocollo CLASSYFARM
2.6.3 Caratterizzazione genetica della psilla del biancospino in Europa
2.6.4 Differenze di sostenibilità traaziende agricole con e senzaalloggio per gli ospiti 159
2.6.5 La fermentazione al servizio del sistemaagro alimentare dell´Alto Adige161
2.6.6 Effetti della combinazione della macerazione fermentativa, del congelamento delle uvee della fermentazione malolattica su vini da Schiava 162
2.6.7 Cooperazione transfrontaliera per la valorizzazione di piante alpine fonte di composti bioattivi 165
2.6.8 Bostrico e fisiologia dell’abete rosso 166
2.7 Formazione professionale168
2.7.1 Scuola professionale per la frutti-, viti-, orti- e floricoltura Laimburg 168
2.7.2 Scuola professionale per l’economia domestica e agroalimentare Corcese per l’agricoltura e le foreste Fürsten-burg (con sede a Burgusio)
2.7.3
2.7.4
Scuola professionale per l’economia domestica e agroalimentare Teodone175
Scuola professionale per l’agri-coltura edeconomia domestica Salern
2.7.5 Scuola professionale per l’economia domestica e agroalimentare Tesimo
2.7.6 Scuola professionale per l’economia domestica e agroalimentare Egna
2.7.7
2.7.8 Scuola professionale provinciale per la fruttiviticoltura e il giardinaggio in lingua italiana – Laimburg
2.7.9 Istituto Tecnico Agrario di Ora
3.Cifre, dati e fattiPagina
3.1 Agricoltura196
3.1.1 Zootecnia196
3.1.2 Frutticoltura202
3.1.3 Viticoltura204
3.1.4 Orticoltura206
3.1.5 Servizio Fitosanitario Provinciale207
3.1.6 Meccanizzazione agricola 208
3.2 Foreste, malghe edeconomia montana210
3.2.1 Caccia e pesca210
3.2.2 Lavori in economia 211
3.3 Agenzia Demanio provinciale214
3.4 Scuole professionali agricole, forestali e per l’economia domestica e agroalimentare




Nell’ambito dell’Amministrazione Provinciale la Ripartizione Agricoltura viene intesa come un’organizzazione amministrativa e di servizio a favore dell’agricoltura orientataalle esigenze dei nostri clienti e partner. Il nostro proposito è quello di voler contribuire nel modo migliore adaccrescere la competitività nonché la sostenibilitàambientale e sociale del settore agricolo. La coltivazione del territorio nella sua complessiva diversità, la produzione di alimenti di alta qualità, la creazione di un reddito adeguato per gli agricoltori e il cambiamento strutturale del mondo agricolo verso la multifunzionalità sono i più importanti obiettivi. Contemporaneamente dovrebbe essere conservato ciò che fino ad oggi si è affermato.
Per questo motivo, oltre alle funzioni pubblico amministrative e di vigilanza, la sfera di competenze della ripartizione si estende anche all’erogazione di interventi di consulenza mirata e ad un’efficiente ed effettiva attuazione della politica agricola di sostegno. Competenze sociali e professionali sono i migliori presupposti perraggiungere concretamente tutti questi obiettivi. Le seguenti pagine della Relazione agraria forestale riportanole singole aree di attività, e in dettaglio i più importanti risultati e tanti numeririferiti all’anno passato.

2.1.1

Nel complesso, il 2023 è stato un anno abbastanza buono. Nei pascoli, il primo taglio è stato leggermente più scarso in termini di resa foraggera, ma l’abbondanza di pioggiaa giugno ha permesso di ottenere un buon raccolto. La qualità del fieno è stata complessivamente soddisfacente. L’autunno è andato bene, tanto che il bestiame di ritorno dagli alpeggi ha potuto essere tenuto al pascolo. Per quanto riguarda la commercializzazione del bestiame, i prezzi dei bovini da ingrasso e dei vitelli sono stati buoni anche nel 2023. L’anno scorso sono stati raggiunti buoni prezzi medi
anche per gli animali da riproduzione di tutte le razze. In termini di commercializzazione, si è registrata una diminuzione del numero di animali commercializzati. Il numero di 34.749 capi commercializzati rappresenta un calo di 4.404 capi Il prezzo medio dei bovini è aumentato dello 0,9%, raggiungendo i 1.093,49 euro, mentre il numero di bovini commercializzati è diminuito di 1.340 unità, per un totale di 9.440 capi. Anche il prezzo medio di vendita dei vitelli e dei cavalli è stato superiore a quello dell’anno precedente (vitelli +5,5%, cavalli +5,5%) Il prezzo medio di vendita è stato più alto anche per il bestiame di qualità e i piccoli animali (bestiame di qualità +6,2%, piccoli animali +12,7%).
Per quanto riguarda l’apicoltura, la resa è stata ancora una volta molto
buona in quasi tutte le zone del Paese. La primavera mite e l’estate calda hanno favorito lo sviluppo delle colonie, così cheerano disponibili molte api bottinatrici e i melari sisono riempiti rapidamente.
Nell’annata lattiero-casearia 2023, le 4.105 aziende altoatesine (162 aziende in meno rispetto all’anno precedente), hanno consegnato alle cooperative altoatesine una media di 30,02 milioni di kg al mese e un volume totale di 362.531.762 milioni di kg di latte Ciò rappresenta un calo del 5,85% rispetto allo stesso periodo dell’anno precedente Il prezzo medio dellatte è incoraggiante: dopo un aumento di quasi 8 centesimi di euro nel 2022, è aumentato di altri 10 centesimi di euro edè per il 2023 di 68,67 centesimi di euro per kg di latte nel 2023.




6.606



36.077

Consistenza delle razze bovine in Alto Adige 2023
Il seguente grafico illustra la consistenza delle diverse razze bovine allevate in Alto Adige.
Attività dellibro genealogico
La Federazione Provinciale Allevatori
Razza Brunaassiste gli allevatori delle razze Bruna, Jersey e Bruna Originale.
La Federazione Sudtirolese Allevatori
Razze Bovine assiste gli allevatori delle razze Grigio Alpina, Holstein, Pinzgauer, l Pezzata Rossa, Pustertaler Sprinzen, Angus, Highlands, Galloway e Blu Belga.

Commercializzazione del bestiame – Prezzi alle aste Il consorzio per la commercializzazione del Bestiame nel 2023 ha tenuto in totale 84 aste, di cui 41 per bestiame da macello (26 a Bolzano e 15 a San Lorenzo di Sebato) nonché 43 aste per vitelli. In totale sono stati venduti 34.749 capi, di cui 480 sul programma di qualità della carne in Alto Adige.
Come previsto, il numero di unità è diminuito sensibilmente rispetto all’anno precedente Ciò significa che in Alto Adige si allevano meno bovini Nonostante il calo delnumero di unità, i prezzi sono aumentatiin tutte le categorie.
«« Per informazioni dettagliate sui prezzi alle aste per bestiame da allevamento vedi fig. xx a pag. xx,nonché per bestiame a macello e per vitelli vedi tab. xx a pag. xx.
Inseminazione artificiale Nell’anno di riferimento sono state eseguite 54.402 prime inseminazioni Equivale ad una diminuzione di 2.022 unità rispetto all’anno precedente.
Il numero delle inseminazioni eseguite da fecondatori laici aziendali è in costante calo.
«« Per informazioni dettagliate sull’inseminazione artificiale vedi tab. xx a pag. xx.
Dati sulle inseminazioni – Confronto dell’anno scorso
20222023 differenza% cambiamento prime inseminazioni56.39454.402-2.022-4 seconde inseminazioni 26.218
-2 terze inseminazioni26.48527.201715 3 ineseminazioni
Monta naturale
Ai sensi del D.Lgs. n. 52 del 11. maggio 2018, nell’anno 2023 sono state approvate 58 nuove stazioni di monta pubblica.
«« Ulteriori dettagli sulla monta naturale vedi tab. 4 a pag. 197.
5.5313,773,34
9.7403,233,18
4.9074,133,16
Produzione lattiera
Produzione e trasformazione dellatte
Latte bovino
Nellalavorazionee commercializzazione dellatte sisono registrati i seguenti cambiamenti: la produzione del formaggio è cresciuta del 0,8 % a 22,9 milioni kg, mascarpone e ricotta sono è aumentata del 7,2 % a 12,58 milioni kg.Anchela produzione di yoghurt e skyr è cresciuta del 2,8 %. Le vendite di latte fresco sono calate del 3,1 % a 17,26 milioni di kg, di cui latte
Prezzo dellatte: sviluppo dal 2006 al 2023
fieno 13,57 milioni kg e 2,02 milioni kg latte fieno bio.
Latte caprino
Il conferimento di latte caprino è cresciuto del 0,9 % ed è arrivato a 1,44 milioni kg. Sono stati prodotti 45.221 kg di latte fresco, 55.624 kg di formaggio, 27.544 kg di yoghurt e 1.946 kg di burro. Controlli funzionali
Dei cavalli registrati nell’ albo genealogico appartengono 3.477 alla razza Haflinger o Norico Queste due razze di cavalli vengono assistiti dalla Federazione Provinciale Allevatori Cavalli Haflinger dell’Alto Adige. L’ufficio zootecniaamministra le stazioni di monta pubbliche e controlla se le analisi sanitarie prescritte sugli stalloni vengano eseguite annualmente.
Razza FattriciStalloni Cavalli castrati
Stalloni riproduttori in Alto Adige 2023

In Alto Adige circa 4.900 aziende si dedicano all’allevamento di ovini e/o caprini.
La Federazione zootecnica Alto Adige assiste 1.850 membri che sono organizzati in 41 associazioni locali di allevatori di ovini e 15 associazioni di allevatori di caprini.
«« Informazioni dettagliate sull’allevamento di ovini e capriniin Alto Adige nonché sulle aste di ovini e caprini vedi tab. xx e xx a pag. xx.
Aste ovini e caprini 2023
Sono state organizzate tutte e tre le aste previste Nelle tre aste sono stati venduti complessivamente 186 ovini e 271 caprini.
Macello e animali da macello
Nell’anno 2023 la Federazione Zootecnica dell’Alto Adige, che gestisce il macello di Bolzano conforme alle disposizioni UE, ha eseguito la ma-

In Alto Adige 90 aziende producono uova fresche per la venditaa rivenditori secondo le direttive UE del sistema all’aperto, della produzione biologica e del sistemaa terra.
L’allevamentodi galline ovaiole in gabbia è vietato in Alto Adige con lalegge provinciale sulla tutela degli animali. Il numero di galline ovaiole presenti in aziende varia tra i 500 ed i 6.000 capi. 80 aziende hanno un proprio centro d’imballaggio riconosciuto per la raccolta, classificazionee imballaggio delle uova, che permette la commercializzazione delle uova al dettaglio. Le uova prodotte vengono vendute quasi esclusivamente sul mercato altoatesino, la commercializzazione vieneeseguita in maggioranza diret-
cellazione di 15.996 capi delle specie bovine, suine,equini, ovinee capre. Nell’anno scorso è stata commercializzata la carne di 9.273 ovini e agnelli, nonché 3.727 caprette e capre. Acquirenti principali in Alto Adige sono le grandi catene di commercio alimentare.


tamente dal produttore al negoziante e in parte tramite cooperativa.
Anche per l’anno 2023 la richiesta di uova fresche da produzione alterna-
tiva nostrana è stata soddisfacente, sebbene l’inflazione e i suoi effetti si siano fatti sentire anche in questo settore.
Dopo diverse annate scarse di miele o addirittura pessime, le apicoltrici e gli apicoltori dell’Alto Adige ricorderanno il 2022 e il 2023 come annate di miele eccezionalmente buone.
Anche se le previsioni per il 2023 non erano le migliori e quindi si aspettava un’annata mielifera scarsa, alla fine fortunatamentetutto è andato diversamente.
A un inverno relativamente caldo e con poche precipitazioni è seguita una primavera eccezionalmente secca, sostituita da un clima estremamente umido e freddoda metà aprile a metà giugno A causa delle condizioni climatiche sfavorevoli alle colonie di api, era necessaria unaalimentazione co-
stante per non interrompere il lavoro delle api. Solo a metà giugno il tempo è finalmente cambiato. Da un giorno all’altro è iniziato il flusso di miele e gli alveari sisono riempiti per la gioia delle api e degli apicoltori.
A parte alcune eccezioni locali, la produzione di miele in Alto Adige nel 2023 è stata significativamente superiore alla mediaa lungo termine.
Negli ultimi anni si è riuscito a contenere la perdita del numero di apicoltori e alveari. Perciò anche nell’anno 2023 il numero si è mantenuto costante, anzi si può notare un leggero aumento
La diminuzione del passato non era sicuramente dovuta soltanto alla varroa

ma anche al mancato rinnovo generazionale al quale si è cercato di reagire con molte iniziative.
Con un vasto programma di informazione degli apicoltori e con la scuola per gli apicoltori “Südtiroler Imkerschule”, nata nel 2007, si è riusciti a formare una nuova generazione di apicoltori. L’interesse per i corsi supera le aspettative e può dare speranza in uno sviluppo del settore.
Riepilogo Associazione
Apicoltori dell’Alto Adige 2023 3.614
Bezirk assoc. Bolzano-Bassa Atesina18
Valli di Tures e Aurina 9 Val d’Ultimo 2
Bassa Val Venosta10
Alta Valle Isarco 6 Totale 111
Nell’anno 2023 sono stati concessi aiuti afavoredelsettorezootecniconell’ammontare totale di 8.824.890,84 €.
Contributi per Federazioni Zootecniche (LP dd. 14.12.1999, n. 10, art. 5)
Riepilogo dei contributi 2023
Federazione Provinciale Allevatori di Cavalli di Razza Haflinger
Allevatori Conigli dell’Alto Adige
Nazionale Allevatori Bovini di Razza Grigio Alpina
Contributi per l’apicoltura e per agevolazioni per meccanizzazione interna, nonché la trasformazione e la commercializzazione dei prodotti agricoli nel settore zootecnico 2023 (Legge provinciale del 14 dicembre 1998, n. 11)
Le varie misure compreso l’importo di finanziamento e i beneficiari sono visibili nelle seguentitabelle:
474.015,00
Contributi a latteriee caseifici sociali
Per i contributi nel settore lattiero caseario trova applicazionela legge Provinciale n. 10, art. 4 del 14 dicembre 1999.
Aiuti per compensare gli svantaggi logistici nella consegna di latte di qualità in zona di montagna (Legge provinciale n. 10/1999)
Aiuti per la coltivazione ecologica di cereali (Legge provinciale n. 11/1998)
Concessione di un aiuto per uccelli che nidificano a terra nella landa di Malles (Legge provinciale n. 11/1998)
Consorzio Altoatesino per la Commercializzazione del Bestiame „Kovieh“
Contributi concessi 2023
Contributi concessi 2023
Contributi concessi 2023
Contributi concessi 2023
Aiuti per il miglioramento della zootecnia Contributi concessi 2023

Assicurazione bestiame – Concessione di aiuti per la copertura assicurativa nel settore zootecnico
(L.P. n. 11 del 14.12.1998)
Beneficiari
• Imprenditori agricoli
• Consorzi di cui all’articolo 11 del D.Lgs. n. 102/2004
• Compagnie di assicurazionee di brokeraggio di assicurazione
• Associazioni agrarie di cui alla legge provinciale n. 9, del 27 aprile 1995.
Tipologie di perdite assicurabili
Copertura di perdite di bovini, equini, ovini e caprini dovute a malattia e ad infortunio, a seguito di epizoozie o
infestazioni parassitarie o di avversità atmosferiche assimilabili alle calamità naturali e altre condizioni atmosferiche avverse.
Tipologia e ammontare dell’aiuto
Contributo in conto capitale fino al 50 per cento delle spese ammissibili per il pagamento dei premi assicurativi. I premi assicurativi finanziabili si possono riferire ad un valore di stima massimo pari a euro 2.000,00 per i bovini ed equini, e a euro 400,00 per gli ovini e caprini.
Misure a sostegno dell’apicoltura ai sensi del regolamento (CE)
n. 1308/2013 - disposizioni speciali relative al settore dell’apicoltura
Il programma annuale 2023 della Provincia Autonoma di Bolzano ha interessato le seguenti misure a sostegno dell’apicoltura:
BeAiuti nel settore dell‘apicoltura - Reg. (UE) n. 2021/2115 Aiuto in Euro
Aggiornamento professionale di apicoltori e tecnici apistici
Acquisto presidi sanitari contro la Varroa
Acquisto di arnieed attrezzature per l’apicoltura
119.732,30
51.773,25
71.796,60
Misure di comunicazionee commercializzazione18.320,00
Totale
261.622,15
Nell’ambito delle attività di controllo (aiuto a favore del benessere animale, contributi per investimenti, contributi per federazioni, mutuaassicurazione del bestiame e il miglioramento della zootecnia) sono stati effettuati circa 100 sopralluoghi dall’Ufficio Zo ot ec ni a.
«« Ulterioriinformazioni, le normee la modulistica per le domande sono disponibili sul sito: www.provincia.bz.it/agricoltura e-mail: zootecnia@provincia.bz.it
Alla fine dell’anno il territorio della Provincia di Bolzano era in possesso del riconoscimento comunitario quale territorioindenne dadiverse malattie infettive dei bovini, degli ovini, dei caprini e dei suini. Si è trattato di malattie quali tubercolosi bovina, brucellosi bovina e leucosi bovina enzootica, rinotracheite infettiva bovina (IBR), brucellosi ovicaprina, Blue Tongue (infezione da BTV), malattia di Aujeszky dei suini.
Di seguito si elenca la rispettiva base legale:
• Regolamento di Esecuzione (UE) 2021/620 della Commissione del 15 aprile 2021 recante modalità di applicazione del regolamento (UE) 2016/429 del Parlamento europeo e del Consiglio per quanto riguarda l’approvazione dello status di indenne da malattia e dello status di zona di non vaccinazione di alcuni Stati membri o di loro zone o compartimentiin relazione adalcune malattie elencate e all’approvazione dei programmi di eradicazione per tali malattieelencate
Profilassi delle malattie infettive dei bovini, degli ovini e dei caprini
Le principali attività, svolte dal 1° gennaio al 31 dicembre, si possono riassumere come segue:
profilassi della spece animale
Brucellosi
campionamento di aziende tramite latte di massa
campionamento di singoli animali tramite: vaccinazioni prova sierologica cartilagine auricolare test intracutaneo
Brucellosi ovicaprino14.598
Brucella Ovis ariete 2.216 Leucosi bovina enzooticabovino4.088
Rinotracheite infettiva bovina/ Vulvovaginite pustolosa infettiva (IBR/IPV)
Diarrea Virale Bovina (BVD) Virus bovino
Diarrea Virale Bovina (BVD) Anticorpi bovino
Blue Tongue bovino 7352.626
Blue Tongue ovino14159
Blue Tongue caprino25241
Paratubercolosi bovino 517
Artrite-encefalite dei caprini (CAEV) caprino25.067
Scrapie genotipizzazioneovino 2.072
Scrapie genotipizzazionecaprino 539
Maedi Visnaovino204 Tubercolosibovino1.523
Carbonchio sintomaticobovino55
Virus di Schmallenberg Anticorpi bovino 345
Febbre Q Anticorpibovino345 «« Per maggiori informazioni sulle singole malattie infettive e sulle misure di prevenzionee metodidi analisi vedi fig. 2 – 8 a pagine 199 – 201
Malattie infettive dei suini
Influenzaaviaria
Ai fini della sorveglianza dell’influenza aviaria si applica la sorveglianza passiva ed attiva secondo le modalità previste dal piano di sorveglianza nazionale. Nella sorveglianza attiva i veterinari ufficiali prelevano campioni di sangue La sorveglianza passiva consiste nella segnalazione di casi anomali di moria di uccelli (soprattutto uccelli acquatici).
Il Piano di sorveglianza nazionale è stato avviato nel 2005. A partire dal 2015 la sorveglianza attiva è obbligatoria, grazie al ridotto rischio di insorgenza dell’infezione, nei soli allevamenti di svezzamento.
Malattie infettive dei pesci
Il programma della Provincia di Bolzano relativo al controllo delle malattie dei pesci più comuni, cioè dellasetticemia emorragica virale (VHS), della necrosi ematopoietica infettiva (IHN), nonché della necrosi pancreatica infettiva (IPN), è stato approvato dalla Comunità Europea con Decisione 2002/304/CE.
Disinfezioni eseguite su animali e strutture
Encefalopatie spongiformi trasmissibili
L’Istituto Zooprofilattico Sperimentale delle Venezieesegue i controlli per Encefalopatie spongiformi trasmissibili (TSE), tramite il cosiddetto test rapido, su bovini, ovini e caprini macellati, macellati d’urgenza o morti in stalla, appartenenti alle fasce di età previste dallalegge.
Sugli oviniin vita viene implementato in Provincia di Bolzano, in base alle disposizioninazionali, un programma per la genotipizzazione. Si puntaad aumentare la resistenza alla TSE ricorrendo alla riproduzione selettiva.
Rabbia
Il sistema di allerta della Provincia di Bolzano prevede che tutte le volpi,i tassi e le martore rinvenuti morti sul territorio provinciale devono essere consegnati presso i centri di raccolta. Le carcasse raccolte vengono inoltrate al Centrodireferenza nazionale per la rabbia che ha sede presso l’Istituto Zooprofilattico Sperimentale delle Venezie di Legnaro (PD) per essere esaminate relativamente alla rabbia. Inoltre devono essere immediatamente denunciati al veterinario ufficiale competentetuttii casi clinici sospetti e tutti i casi che facciano sospettare
la presenza della rabbia. Ciò vale per tutte le specie animali.
L’Alto Adige è considerato zona indenne dalla rabbia ai sensi del Regolamento di Esecuzione (UE) 2021/620 della Commissione del 15 aprile 2021 recante modalità di applicazione del regolamento (UE) 2016/429 del Parlamento europeo e del Consiglio per quanto riguarda l’approvazione dello status di indenne da malattia e dello status di zona di non vaccinazione di alcuni Stati membri o di loro zone o compartimenti in relazione adalcune malattieelencate e all’approvazione dei programmi di eradicazione per tali malattieelencate.
Aziende con riconoscimento comunitario nel settore dei prodotti o dei sottoprodotti di
animale:
«« Per informazioni dettagliate sul piano nazionale per la ricerca di residui (PNR) vedi tab. 8 a pag. 202.
«« Ulterioriinformazioni, le normee la modulistica per le domande su malattie infettive e prodotti alimentari di origine animale sono disponibili sul sito: https://landwirtschaft.provinz.bz.it e-mail: vet@provincia.bz.it vet@pec.prov.bz.it

Con 1.005.618 tonnellate, il raccolto di mele del 2023 ha raggiunto la soglia del milione di tonnellate per la prima volta dal 2016, dopoché negli anni precedenti era rimasto al di sotto di questo magico traguardo per sei volte consecutive. Oltretutto, il raccolto 2023 era stato significativamente superiore alla stima (circa 930.600 tonnellate). I motivi principali sono stati la quota di rinnovo più bassa rispetto agli anni precedenti e lelimitate perdite dovute a gelo, grandine e organismi nocivi.
Le cause principali delle riduzioni negli ultimi anni sono state una quota di rinnovo più elevata, la riduzione della superficie di produzione a favore della viticoltura e l’aumento delle superfici di coltivazione biologici, dove le rese sononaturalmente un po’ più basse La quota della merce d’industria si ammontaa circa 11%, per cui risultano 897.731 t merce da tavola La prima posizione ricopre sempre la Golden Delicious,seguita da Gala e la varietà Cripps Pink, che ricopre la prima volta il terzo posto.
Principalmente, l’Alto Adige ha un potenziale per avere raccolti di circa 1 milione di tonnellate, che significa il 10% del raccolto europeo. Però, come abbiamo visto negli ultimi anni, a medio e lungo termine diventerà sempre più difficile raggiungereeffettivamente questo marchio. Le ragioni principali sono tra l’altro la conversione di alcuni frutteti in viticoltura, la conversione di vecchie varietà (ad alto rendimento) in nuove varietà, i cambiamenti climatici e la crescente conversione in produzione biologica.
Le condizioni meteorologiche favorevolihanno portato una resa molto alta dei piccoli frutti con una buona qualità e un diametro grandedelle bacche. La superficie coltivata a fragola nel 2023 è rimasta uguale rispetto all’anno precedente Nel caso dei lamponi si è registrata una ulteriore leggera diminuzione. Le restanti superfici produttive delle colture a piccoli frutti sono rimaste stabili. L’attuale superficie complessiva di coltivazione a piccoli frutti ammontaa 116 ettari circa. Il raccolto complessivo di albicocche in Val Venosta, simile all’anno precedente,era pari a 280 t e nuovamente sotto la media degli anni precedenti La superficie totale di coltivazione delle albicocche nell’anno di riferimento, in leggera tendenza negativa rispetto
all’anno precedente, ha raggiunto circa 80 ettari.
La superficie coltivataa ciliegio di 123 ettaririmane quasiinvariata rispetto all’anno precedente. Le quantità raccolteerano nella media mentre la qualità dei frutti ha raggiunto un livello ottimale.

Suddivisione delle superfici
Rispetto all’anno 2022 si riscontra ancora una leggera diminuzione della superficie totale, un trend che si nota da alcuni anni Seguono i dettagli:
Consistenza delle varietà piùimportanti in Alto Adige (ettari)
1,10,0















































































RohoJonagoldStaymanWinesap Idared ElstarCivni-Rubensaltrevarietàmeletotalevarietàpere
degli anni 2022 e 2023 (t) nell’Unione Europea
UE + GB (28 stati me)
La quantità stimata dall’UE per il raccolto 2023 risulta leggermente inferiore a quello del 2022, che a sua volta era simile a quello del 2021. Tuttavia, è necessario distinguere fra mela e pera: il raccolto di mele diminuirà leggermente mentre quello di pere diminuirà drasticamente dopo il raccolto estremamente alto dell’anno precedente
La Polonia rimane leader nella produzioneeuropea di mele con ca. 3.995.000 tonnellate (-11% in confronto a 2022), seguita da Italia (2.104.000 t, +-0%), Francia (1.501.000 t, +8%),
Raccolti degli anni 2022 e 2023 in Alto Adige (t)
Raccolto in Alto Adige (t)
Fonte: Centro di Consulenza per la fruttivitcoltura dell’Alto Adige
Germania (952.000 t, -11%), Ungheria (550.000 t, +96%), Spagna (536.000t, +30%) e Romania (406.000 t, +-0%).
Riguardo alle varietà nella classifica della produzione europea la Golden ricopre la prima posizione con 2,17 milioni tonnellate (+12% rispetto l’anno precedente), seguono Gala con 1,53 mio t (+5%), il gruppo Jonagold con ca 1,03 mio t (-13%), Red Delicious con 0,62 mio t (-10%), Idared con ca 0,60 mio t (-6%), Shampion con 0,42 mio t (-7%), Granny Smith con 0,32 mio t (-22%), Fuji con 0,31 mio t (-8%) e Elstar con 0,29 mio t (-21%).
Fuori dall’UE, la Turchia diventa sempre più importante nell’settore del commercio della mela. Per la Turchia è prevista una produzione di circa 4,6 mio t, un raccolto relativamente alto. La Turchia sale al terzo posto nella classifica mondiale dei paesi produttori di mele, seguendo la Cina (37 milioni di tonnellate) e gli Stati Uniti (4,6 milioni di tonnellate).
Per la produzione europea di pere è previsto con circa 1,75 milioni tonnellate un raccolto più basso in confronto all’ultimo anno.
Nel mese di agosto 2023 è stato stimato per l’Alto Adige una raccolta di 930.583 t.
I frutticoltori biologici altoatesini nell’anno di riferimento hanno riscontrato un aumento dei quantitativi prodotti Il raccolto di 92.766t ha portato un aumento di ca 7.133 t. Il quantitativo biologico realmente prodotto è sicuramente ancora più alto, perché le mele delle aziende in conversionee quelle della raccolta dei filari di bordo non possono essere conferite come produzione biologica.
«« Per ulteriori dettagli sull’assortimento varietale del raccolto di mele 2023 in Alto Adige vedi tab. 10 a pag. 203.
«« Per ulterioriinformazioni su prezzi medi al produttore per il raccolto di varietà da tavola 2022 vedi tab. xx a pag. xx.

La superficie coltivata a fragola nel 2023 è rimasta uguale rispetto all’anno precedente Nel caso dei lamponi si è registrata una ulteriore leggera diminuzione del 10%. Le restanti
superfici produttive delle colture a piccoli frutti sono rimaste stabili. L’attuale superficie complessiva di coltivazione a piccoli frutti ammonta a 116 ettari circa.
Superficie suddivisa per generi di piccoli frutti














Lo svernamento 2022/2023 delle colture a piccoli frutti è stato in gran parte soddisfacente. Non sisono manifestate gelate intense in primavera. Negli ultimi anninon ci sono mai stati così pochi giorni di gelata in primavera come nel 2023.
Il 2023 è stato l’anno più caldo rispetto agli ultimi 9 anni. A favore delle coltu-



re a piccoli frutti si deve considerare che la temperaturaalta non si è manifestata solamente in alcune giornate con caldo torrido come nel 2022, ma era distribuita nell’arco dei mesi in modo piùuniforme. Anche le piogge ripetute hanno mitigato il caldo.
Questo andamento meteorologico ha portato a una resa molto alta con una
buona qualità e un diametro grande delle bacche.
Da notare è la comparsa del moscerino dei piccoli frutti (Drosophila suzukii) due settimane prima come di consueto. Con una buona igienelavorativa e con le possibili strategie di lotta da adottare si è potuto controllare relativamente bene la situazione.
Fragole: il raccolto con piante svernanti e della produzione programmata è stato al di sopra della media pluriennale; le piante svernanti hanno avuto una produzione di 250-350g/pianta circa di prima qualità e la produzione programmata ha registrato 200-250g/ pianta circa di prima qualità. Le varietà rifiorenti hanno avuto una produzione molto buona di 400-600g/pianta. Il ricavato è stato di nuovo molto buono, risultando solo poco sotto la media dell’anno precedente.
Lamponi: la produzione è risultata di nuovo sotto la media. Diversi problemi comportano il ristagnamento delle coltivazioni Nel complesso è stata raccolta solola metà della quantità prevista. Il ricavato è stato soddisfacenteedè risultato nella media degli anni passati.
Ribes: hanno raggiunto di nuovo nell’anno di commercio 2023 un prezzo buono che risulta nella media pluriennale Anche la resa è risultata nella media.
Mirtilli: la quantità diraccolto rientra nella media. I prezzi erano più alti rispetto all’anno precedente, ma probabilmente sistabilizzerannonel medio termine a causa dell’offerta crescente.
Commercializzazione
La richiesta sui mercati è stata di nuovo molto buona,anche a causa della domanda di piccoli frutti da parte delle famiglie. I prezzi ricavati nell’anno 2023 sono stati nuovamente molto buoni e anche nella media pluriennale
La maggior parte della produzione di piccoli frutti realizzata in Alto Adige viene commercializzatatramite la Cooperativa dei produttoridella Val Martello e tramite le aste di frutta dell’Egma di Vilpiano, prevalentemente nella zona settentrionale dell’Italia, ma anche a livello regionale conla venditaal dettaglio. Una grande azienda nella zona di Bressanone, con luoghi di produzione in Alta Val d’Isarco e in Pusteria, rifornisce prevalentemente supermercati italiani e in parte ancheesteri. Tante aziende vendono il proprio prodotto direttamente al consumatore tramite attività agrituristiche o



mercati contadini. Ormai quasi tutti i mercati contadini offrono durante l’estate piccoli frutti freschi.

Coltivazione di albicocche
In Val Venosta, la superficie degliimpianti di produzione, con commercializzazione centralizzata tramite Vi.P, è pari a 56 ettari Ulteriori superfici, soprattutto in forma di allevamento estensivo, vengono commercializzatetramite mercati contadini e vendita diretta al maso e di conseguenza la superficie totale adalbicocche nell’anno diriferimento, in leggera tendenza negativa rispetto all’anno precedente, ha raggiunto circa 80 ettari L’inizio del periodo vegetativo era caratterizzato da condizioni meteorologiche favorevoli e la fase di impollinatura si è presentata uniforme ai primi di marzo. Simile all’anno precedente e a eccezione di pochi impianti precoci in fondovalle, non sisono manifestati danni causati da gelatetardive. Il tempo favorevole ha influito positivamente sia per una buona e concentrata fioritura, che per l’allegagione, per tutte le varietà. Negliimpianti si è dovuto investire molto più tempo e lavoro nel diradamento a mano in confronto al 2022. Il periodo con poche precipitazioni fino a giugno
nonha avuto effetti negativi sul calibro dei frutti, che fino alla raccolta ha raggiunto livelli soddisfacenti e sopra la media.
Il raccolto complessivo in Val Venosta, simile all’anno precedente, era pari a 280 t e sotto la media degli anni precedenti.
Le condizioni di lavoro di raccolta sono state molto difficili in quanto le ripetute variazioni meteorologiche impedivano unaattività regolare. La percentuale delle albicocche biologi-
cheera di nuovo in calo in confronto alla produzione totale.
Fitopatologie
Nell’anno di riferimento sono stati osservati meno danni causati da batteriosi (Pseudomonas) eccetto per la varietà Goldrich, dove sisono manifestateelevate infestazioni della frutta.
Sulla stessa varietà sisono osservate numerose macchiee decolorazioni
fogliari, che fino ad oggi non sisono potute collegare a una diagnosi. Sulla varietà principale, la Vinschger Marille, durante la raccolta sisono potuti osservare gravi danni da piogga e vento, che hanno portato a una caduta precoce dei frutti e alla spaccatura prematura dei frutti restanti sull’albero Questo fatto ha rinforzato il rischio di attacco del Moscherino dei piccoli frutti (Drosophila suzukii) e lo sviluppo dellaMonilia. Le adeguate misure di contenimento hanno funzionato così che i danni potevano essere tenuti sotto controllo.
La superfice coltivata nella provincia rimane quasiinvariata a 123 ettari (-1 ettaro rispetto all’anno precedente).
Nell’anno di riferimento non sisono verificati danni per gelatetardive mentre l’allegagione per cause meteorologiche risultava scarsa.
Attività di controllo relativa all’organizzazione comune dei mercati nel settore ortofrutticolo come previsto dal Regolamento UE 1308/13 del 17 dicembre 2013
In base all’art. 152 del Regolamento UE 1308/13, in Alto Adige sono attive tre organizzazioni di produttori (OP), legalmente riconosciute: VOG, VIP e VOG Products
Le forti precipitazionihanno messo a dura prova i coltivatori di ciliegie. Con la strategia di difesa fitosanitaria consigliata contro le malattie crittogamiche si è potuto raggiungere un

alto grado di protezione. Piante non trattate, invece, risultavano particolarmente colpite. Il moscerino dei piccoli frutti è stato tenuto sotto controllo tramite il monitoraggio, la chiusura puntuale delle reti di protezionee un ottimale strategia di difesa fitosanitaria.
Le quantità raccolteerano nella media mentre la qualità dei frutti ha raggiunto un livelloottimale.
I prezzi raggiunti nella commercializzazione diretta erano di un livello soddisfacente.
Coltivazione di susine
La coltivazione di susine, invece, è stata caratterizzata da impianti tradizionalinella Valle d’Isarco e nella zona del comprensorio dello Sciliar. Si stimano all’incirca 9 ettari di coltivazioni professionali di susine che, per la prima volta da anni, è in leggero aumento (+1ha).

In Alto Adige, all’incirca l’82% delle cooperative e 83% dei produttori operanti nel settore ortofrutticolo sono riuniti nelle organizzazioni di produttori ed hanno a disposizione il 94% della superficie coltivata.
In data 15.02.2023 è stato consegnato da parte delle tre organizzazioni di produttori il rendiconto del programma operativo approvato ed at-

Sono stati ammessi a contributo anche altri progetti come per esempio progetti informatici, progetti per il miglioramento qualitativo dei prodotti, progetti per la ricerca di mercato, investimenti per il risparmio energetico e costi per il personale per il mantenimento e miglioramento della qualità. È stato approvato un premio fino a 720,00 euro/ettaro ai singoli produttori per laloro partecipazione al programma di produzione integrata rispettivamente per la produzione biologica: è stataapprovata una superficie netta pari a 12.900 ettari per la produzione integrata e 1.800 ettari per la produzione biologica, equivalente a circa il 100% dell’intera superficie netta coltivabile delle organizzazioni di produttori VIP e VOG.
Si sono potuti ammettere a contributo i costi per l’acquisto dei dispenser dei singoli produttori delle cooperative associate per laloro partecipazione al progetto della confusione sessuale. Inoltre,è stata esaminata e revisionata ai sensi delle disposizioni vigenti la funzionalità delle tre organizzazioni di produttori È stata verificata la conformitàalle richieste generali della CE circa l’organizzazione comune dei mercati (statuti, regole ed altro) Il risultato può considerarsi positivo.
In autunno è stato controllato a campione il valore della produzione com-
tuato durante l’anno 2022. In totale sono stati rendicontati 54.529.440,00 euro. I controlli della rendicontazione sono stati effettuati per la prima volta dall’organismo pagatore competente.
A settembre è stato consegnato da parte delle tre organizzazioni di produttori la domanda di approvazione della modifica in corso d’opera 2023
del programma operativo approvato. In totale sono stati approvati 55.318.774,00 euro. Il contributo spettante, pari ad un massimo del 50% delle spese riconosciute, ammontaa 27.659.387,00 euro
Obiettivo principale dell’incentivazione sono statii seguenti investimenti:
mercializzata (VPC) nel 2021/22 presso le sedidelle OP: ne è stato ammesso per 680 milioni di euro edè condizione fondamentale per il programma operativo 2024.
Contributiin conto capitale per l‘incentivazione delle imprese di elaborazione e di commercializzazione di prodotti agricoli
In base alla Legge Provinciale 11/98 è stato concesso a 27 aziende private un contributo in conto capitale del
30-40% per gli edifici e del 20-30% per macchineed impianti per un valore totale di 323.090,00 euro
Le spese ammissibili ammontavano ad 972.200,00 euro.
«« Ulterioriinformazioni, le normee la modulistica per le domande sono disponibili sul sito: www.provincia.bz.it/agricoltura/ e-Mail: frutti-viticoltura@provicia.bz.it obstweinbau.fruttiviticoltura@pec.prov.bz.it


2.1.3 Viticoltura
Evoluzione varietale e delle superfici vitate
La superficie vitata dell’Alto Adige dal 2000 ad oggi è aumentata di 900 ettari e secondo lo schedario viticolo, al 30 dicembre 2023 la superficie adibita a vigneto ammontaa 5.801 ettari
Se si considera che gli appezzamenti nel primo anno di vegetazione non producono uva e quelli nel secondo anno di vegetazione producono la metà in confronto a viti pienamente sviluppate, risultano 5.540 ettari di superficie vitata in produzione Nel corso del 2023 sono statiimpiantati complessivamente 167 ettari, di
cui 101 ettari ex novo, cioè su superfici finora non coltivate a vigneto. In confronto all’anno 2022, corrisponde a un aumento di 26 ettari Per gliimpianti complessivi invece si registra un aumento di solo un ettaro. Nel 2023, le estirpazioni eseguite a causa delle riconversioni colturali o per attività edilizie ammontano a circa 21 ettari e hanno quindi avuto una riduzione di 6 ettaro.
Di seguito viene riportata la scelta varietale per i nuoviimpianti di
viti effettuati nel 2023 estrapolati dai valori effettivi degliinserimenti
Schiava Merlot
Sylvaner verde
Solaris
Riesling Renano
Souvignier Gris B.
Kerner
Nel settore di punta dellenuove piantagioni si trovano le due rinomate varietà di Pinot, Chardonnay e Pinot Nero, con una superficie di 50,4 ettari (30,1%), seguite da Sauvignon blanc, Pinot Grigio, Traminer aromatico, Pinot Bianco e Lagrein, ognuna delle quali presenta una superficie di nuova piantagione di oltre 10 ettari, responsabili complessivamente di 75 ettari (44,7%) dei nuoviimpianti Rispetto al 2022, sono state piantate significativamente meno superfici di Lagrein (-9,1 ettari) e Pinot Bianco (-4,4 ettari), mentre la scelta di Souvignier Gris è aumentata
Secondo le dichiarazioni di vendemmia e di produzione vino, la resa nel 2023 ha raggiunto 511.000 q.li di uva prodotta susuperficie vitata nella provincia di Bolzano. Ciò comporta un aumento in confronto all’annata 2022 di 3.103 q.li di uva, ovvero dello 0,6 %. La produzione di vino da uve provenienti dalla Provincia di Bolzano ammonta intotale a 362.054 ettolitri di vino. La maggior parteè prodotta da cantine in provincia che raggiun-
Carbernet S.
nella banca dati dello schedario viticolo:
di 4,2 ettari rispetto all’anno precedente.
La superficie piantata a vitigni bianchi ammonta oraal 65,15% dell’area vitivinicola, con le varietà Pinot Grigio, Chardonnay, Traminer Aromatico e Pinot Bianco in testa, ognuna con oltre 600 ettari
L’incremento delle sopra citate varietà è avvenuto a scapito principalmente della varietà Schiava, che ha registrato una diminuzione di superficie in confronto al 2022 di 35 ettari. La sua estensione territoriale ammontaa 469 ettari, che corrispondono ad una quota di
8,1% della superficie vitata altoatesina ed è all’ottava posizione, superata dal Sauvignon Blanc. Anche Muller-Thurgau e Kerner hanno subito perdite di superficie, con una diminuzione di 11 e 8 ettari rispetto all’anno precedente. Nel quadro complessivo delle varietà, le varietà di vino a bacca bianca Pinot Grigio con 700 ettari, Chardonnay con 649 ettari, Traminer Aromatico con 635 ettari e Pinot Biancocon 610 ettari sonole più rappresentate in termini di superficie, seguite dalle varietà di vino rosso Pinot Nero con 579 ettari e Lagrein con 537 ettari.
gono un quantitativo complessivo di 328.943 ettolitri, mentre cantine nella Provincia di Trento hanno prodotto 33.111 ettolitri dalla vinificazione di uve altoatesine, ovvero il 9,15 %. I valoririportati sono riferiti al vino finito, senza fecce.
In confronto al valore complessivo dei dati dichiarati nell’ambito delle dichiarazioni di produzione vino dell’annata 2022 di 362.810 ettolitri, si registra una differenza di meno 756 ettolitri (-0,2 %). Considerando il valore medio degli ultimi 10 anni, che ammonta a 326.898 ettolitri, la produzione complessiva di vino del 2023 è collocata al di sopra
della media per circa 35.156 ettolitri (+10,8 %) Del vino prodotto in Alto Adige il 93 % è a DOC.
In Alto Adige, nel 2023 la resa media per ettaro ha raggiunto un valore di 93,69 q.li/ettaro, considerando la superficie produttiva dichiarata di 5.454 ettari Con questo la resa per ettaro è inferiore a quella dell’annata 2022 di soli 0,96 q.li/ettaro
«« Per maggioriinformazioni sulla produzione del vino degli anni 2000 – 2023 vedi fig. 9 a pag. 204.






































































































































































Secondo il censimento agricoltura del 2020, la superficie orticola altoatesina conta 1.455 ettari, di cui 550 circa vengono dedicati alla sola coltivazione di patate da consumo. Le patate sono un importante prodotto di nicchia in Alto Adige, masoprattutto la coltivazione di tuberi-seme in Val Pusteria ha una grande importanza economica. Ulteriori principali colture sono i cavolfiori, gli asparagi, le rape rosse, il radicchio e il cavolo bianco. Solo poche aziende sono specializzate esclusivamente nel settore orticolo, mentre per tutte le altreesso rappresenta una fonte di reddito secondaria Nel commercio diretto rivestono un ruolo importante la coltura protetta di pomodori, cetrioli, peperoni, melanzane e altre colture orticole mediterranee.
Attualmente la superficie orticola altoatesina, il cui prodotto è commercializzato dalle più importanti cooperative, conta quasi 290 ettari.



In Val Venosta
il raccolto degli ortaggi nel 2023 ha portato ad una produzione complessiva di oltre 3.250 tonnellate. La superficie coltivata complessiva è di quasi 102 ettari, di cui 81 sono coltivati a cavolfiore con una produzione di 2.863 tonnellate
Le condizioni meteo sono state tutt’altro che ideali per l’orticoltura: per le piogge in primavera, primaancora del raggiungimento della crescita definitiva dell’insalata, si è manifestato del marciume nelle coltivazioni. Nel periodo seguente di caldo-secco in alcune zone sono comparsi in modo massiccio alcuni parassiti come la tignola dei cavoli (Plutella xylostella) e lo scarabeo della patata (Leptinotarsa decemlineata).
La tarda estate e l’autunno caldo e piovoso hanno provocato delle perdite di raccolto del cavolfiore a causa dell’alternaria. Nelle rape rossesi è dovuto constatare un aumento della ramularia e la cercosporiosi e nel sedanola septoriosi fogliare.
In Val Pusteria
la primavera è stata caratterizzata da freddo e umido, che aveva come conseguenza un lento sviluppo della patata e un forte aumentodi erbe infestanti nella colturaa rape rosse

L’andamento climatico è stato poi caratterizzato da periodi di caldo torrido e siccità Durante la raccolta si è constatato un aumento della Rizottoniosi della patata (Rhizoctonia solani). La resa delle patate e degli ortaggi da campo (radicchio e capuccio) è stata nella media pluriennale. A causa delle erbe infestanti la resa delle rape rosse è stataal di sotto della media. 2.1.4

Nel 2023 gliispettori del Servizio fitosanitario hanno rilasciato, in seguito ai controlli previsti dalla normativa di riferimento, complessivamente 6122 certificati fitosanitari per l’export di vegetali e prodotti vegetali verso 55 Paesi terzi Circa il 95% dei certificati sono stati emessi per l’export di mele I restanti certificati sono stati rilasciati per l’export di materiale vivaistico e legname, nonché prodotti in legno. La quantità totale di mele esportata ammontaa 107.521 tonnellate che corrisponde a un calo complessivo del 34% rispetto all’anno precedente. Nell’anno 2023 i 5 mercati di destinazione più rilevanti per le mele dell’Alto Adige sono stati Arabia Saudita, India, Norvegia, Brasilee Emirati Arabi Uniti, con complessivamente 73.653 tonnellate, rappresentando il 69% delle esportazioni.
16.146 tonnellate sono stateesportate verso paesi dell‘America Latina che corrispondono al 15% delle esportazioni verso Paesi terzi; le esportazioni

Dal 2017 viene svolto il monitoraggio della cimice asiatica a livello provincialee questo è continuato anche nel 2023 In stretta collaborazione tra il Centro di sperimentazione Laimburg, il Centro di consulenza per la fruttiviticoltura dell’Alto Adige, il Centro di consulenza per l’agricoltura montana BRING e il Servizio fitosanitario
sono state installate, e controllate settimanalmente, su tutto il territorio altoatesino 37 trappole a feromoni. In seguito a quest’attività sono state catturate oltre 4.700 cimici adulte e ulteriori 3.750 giovani, detti “neanidi”. Se si considerano solo i dati relativi alle catture, senza tenere conto dei danni, si nota solamente una leggera fluttuazione della popolazione complessiva rispetto ai due anni precedenti. In particolare, il numero dicimici adulte catturate è sottoposto
verso il Brasile sono quasi raddoppiate rispetto all’anno precedente. Sono invece diminuite notevolmente le esportazioni verso l‘Egitto (meno 80%) e verso l’India (meno 44%).
«« Per maggioriinformazioni sull’export di mele verso Paesi terzi vedi tab. 13 a pag. 207.

a una fluttuazione poco rilevante nel triennio 2021-2023.
I danni ai frutti causati dalla cimice asiatica sono stati complessivamente limitati. Secondo le stime dei tecnici del Centro di consulenza per la fruttiviticoltura dell’Alto Adige, solo in casi isolati sono stati riscontrati danni a doppia cifra. Nel complesso la percentuale si attestaa meno del 1%.
Per la prevenzione contro l’introduzionee la diffusione di organismi nocivi da quarantena, lalegislazione dell’Unione Europea richiede indagini annuali. Nell’ambito del programma di monitoraggio devono essere dettagliatamente programmate le attività previste che devono poi essere comunicate al Servizio fitosanitario centrale e al Ministerodell’Agricoltura. Il piano per il 2023 è stato rispettato in tutte le sue parti.
Nel complessosono stati sorvegliati 82 organismi nocivi da quarantena. Di questi, 4 (Colpo di fuoco batterico, Flavescenza dorata, nematodi cisticoli della patata “Globodera pallida e Globodera rostochiensis”) sono già presenti sul territorio della Provincia di Bolzanoo limitati adalcune zone Per questi patogeni esistono delle prescrizioni specifiche a livello provinciale.
I controlli richiesti sono stati effettuati su tutto il territorio provinciale. In questo modo sono state ispezionate circa 130 specie di piante in diverse aziende e contesti ambientali (p.e. garden center, vigneti, verde urbano). Il più grosso impegno è rappresentato dalle ispezioni visive (4.900) Oltre a ciò, sono stateeffettuate circa 1.950 ispe-
Con complessivamente 29 casi si può considerare il 2023 come uno degli anni più tranquilli dalla prima comparsa del Colpo di fuoco batterico (Erwinia amylovora) in Alto Adige. Soprattutto erano interessate piante di melo in produzione. Un maggiore numero di casi è stato riscontrato solo nel Comune di Appiano dove a causa della forte infestazione si è dovuto estirpare un intero impianto di melo in produzione.
«« Per ulteriori dettagli su comuni con casi accertati di Colpo di fuoco batterico vedi tab. 14 a pag. 207.

zioni nell’ambito del controllo delle 136 trappole attrattive e 629 campionamenti per analisi di laboratorio. Per la prima volta il Centro di consulenza della fruttiviticoltura dell’Alto Adige ha supportato il servizio fitosanitario durante il monitoraggio ufficiale. A seguito dei controlli è stato riscontrato un nuovo moscerino regolamentato come organismo nocivo prioritario da quarantena a livello europeo. Si tratta di un singolo maschio adulto della mosca orientale della frutta, Bactrocera dorsalis, il qualeè stato catturato nel Burgraviato in una trappola a feromoni specifica per questa specie. La conferma ufficialeè stata data tramite analisi di laboratorio. Si presume che non si tratti della scoperta di un nuovo focolaio, ma dell’introduzione accidentale avvenutatramite l’acquisto di merce infestata. Questa ipotesi può essere avvalorata dall’immediata

vicinanza delluogo di ritrovamento a un’azienda che agisce sul mercato internazionale nel settore di elaborazione di frutta e verdura. L’azienda è stata tempestivamente informata del ritrovamento. Sono quindi state installate diverse trappole a feromoni nei locali e nelle immediate vicinanze dell’azienda, che sono poi state controllate regolarmente fino a novembree fortunatamente non sono stati rilevati altriindividui della specie problematica. Secondo diverse pubblicazioni scientifiche, l’organismo nocivo non può svernare nel clima dell’Alto Adige. Tuttavia, per l’anno 2024, è prevista l’installazione di diverse trappole a feromoni nell’area interessata.

Le due più importanti malattie dei giallumi della vite, causate da fitoplasmi, sonola malattia del Legno nero (Candidatus Phytoplasma solani) e la Flavescenza dorata (Grapevine flavescence dorèe phytoplasma). A causa della sua virulenza e della sua diffusioneepidemica, la Flavescenza dorata è classificata come malattia da quarantenanell’Unione Europea edè quindi soggetto a segnalazione ed estirpazione obbligatoria. I casi sospetti devono quindi essere segnalati al Servizio fitosanitarioo al Centro di Consulenza per la Frutti-Viticoltura dell’Alto Adige.
L’agente patogeno che causa la malattia dellegno nero è trasmesso da Hyalesthes obsoletus (cicalina del Legno nero), mentre l’agente patogeno che causa la Flavescenza dorata è trasmesso principalmente da Scaphoideus titanus (cicalinaamericana della vite).
Entrambe le malattie sono diffuse in molte regioni viticole europeee possono causare ingenti danni economici a causa delle perdite di resa che ne derivano. Poiché i sintomi delle malattie da ingiallimento della vite non possono essere distinti visivamente l’uno dall’altro, sononecessarie analisi di laboratorio per identificare l’agente patogeno.
Nel 2023, nell’ambito del programma di monitoraggio delle malattie dei giallumi della vite, sono stati prelevati 795 campioni di foglie da viti sintomatiche per essere analizzati in laboratorio dal Servizio fitosanitario in collaborazione conla Consulta per la frutticoltura e la viticoltura dell’Alto Adige. In 613 casi (77%) è stato individuato il patogeno che causa la malattia dellegno nero e in 107 casi (13%) il patogeno che causa l’ingiallimento dorato. Rispetto all’anno precedente, si è registrato un nuovo aumento dei casi di giallume dorato Nuovi casisono stati rilevati nei comuni di Lagundo, Andriano, Ora, Bolzano, Appiano, Velturno, Caldaro, Cortaccia, Magrè, Merano, Montagna, Nalles, Naturno, Egna, Renon, San Pancrazio in Val d’Ultimo, Terlano, Termeno e Villandro.

Le aree delimitate della Flavescenza dorata sono ridefinite annualmente con decreto del Servizio fitosanitario in base all’incidenza dell’infezione. L’area delimitata è costituita dalla zona infestata e dalla zona cuscinetto La zona infestata è costituita dal vigneto in cui è stato rilevato l’agente patogeno della Flavescenza dorata mediante analisi di laboratorio. La zona infestata può comprendere diversi vigneti limitrofi. Una zona cuscinetto è adiacente alla zona infestata, con un raggio di almeno 500 metri.
Nelle aree delimitate, i proprietari dei vigneti o chi neha la disponibilitàa qualsiasi titolo sono tenuti a effettuare controlli regolari. Se le piante nella zona infestata mostrano sintomi dei giallumi della vite, devono essere immediatamente estirpate insieme
al portainnesto, anche senza precedenti analisi di laboratorio.
Devono essere effettuati adeguati trattamenti fitosanitari per contenere le popolazioni del principale vettore della Flavescenza dorata. Il Servizio fitosanitario stabilisce annualmente, con apposito decreto, le modalità di attuazione dei trattamenti sopra citati.
Se più del 20% delle viti di un vigneto presenta sintomi dei giallumi della vite, è possibile ordinare l’estirpazione dell’intero vigneto dopo aver valutato il rischio fitosanitario.
A causa dell’elevato rischio fitosanitario, tuttii vigneti abbandonati nel territorio della Provincia dell’Alto Adige devono essere estirpati dai rispettivi proprietari o da chi neha la disponibilità a qualsiasi titolo.
Nel 2023, il Servizio fitosanitario ha effettuato un gran numero di ispezioni fitosanitarie nelle zone infestatee nei vigneti abbandonati. Inoltre, sono stati effettuati controlli a campione sull’attuazione delle misure di controllo obbligatorie contro il vettore principale Scaphoideus titanus (cicalina americana della vite). In diversi casi, le norme fitosanitarie sono state disattese, per un totale di 49 sanzioni amministrative.
Il Servizio fitosanitario, in collaborazione con il Centro di ricerca Laim-
Nel 2023 in Alto Adige sono stati prodotti portainnesti e marze su complessivamente 15,5 ha di superficie Le aziende con sede legale in Alto Adige producono, in provincia, soprattutto marze, in quanto la maggior parte dei portainnesti viene prodotta al di fuori dei nostri confini. Oltre ai controlli visivi durante il periodo vegetativo nei campi di piante madre, in autunno sono stati effettuati dei campio-
burg e il Centro per la Frutti-Viticolturadell’Alto Adige, ha effettuato ispezioni sul campo in diverse zone viticole dell’Alto Adigeda giugno a novembre. In tutte le zone viticole della nostra provincia sono stati affissi trappole cromotropiche in un totale di 60 località per monitorare la presenza del principale vettore della Flavescenza dorata, Scaphoideus titanus (cicalina americana della vite). Un totale di 1.745 esemplari di Scaphoideus titanussono stati catturati sulle trappole cromotropiche. Le trappole
sono state analizzate per ottenere informazioni sulla densità di popolazionee sui modelli di volo di questa cicalina. Come nell’anno precedente, anche nel 2023 è stato registrato un calo della popolazione.
Approfondimento particolare:
lo scarabeo giapponese –un organismo nocivo da quarantena con alto potenziale di danno
Lo scarabeo giapponese (Popillia japonica), anche chiamato popillia è un coleottero alieno che può essere molto pericoloso per l’ambiente e l’agricoltura. La specie non è attualmente presente in Alto Adige. Gli adulti si
namenti di sarmenti di potatura per la verifica della presenza di virosi. Su nessuna delle partite campionate è stata accertata la presenza di virus. Va invece riportato che in 3 casi è stato riscontrato l’agente patogeno della Flavescenza dorata e di conseguenza i campi di piante madre sono stati esclusi dalla certificazione. Nel 2023 sono state prodotte barbatelle di alta qualità con un buon grado di lignificazione, anche se ci sono state delle difficoltà causate dalle condizioni climatiche particolari. La somma delle barbatelle prodotte in
Alto Adige ammonta a 296.314, in leggero aumento rispetto all’annata precedente. In questo contesto c’è da dire che una parte considerevole delle barbatelle prodotte dalle ditte vivaistiche altoatesine viene coltivata al di fuori del territorio provinciale, soprattutto nel Veneto Tra le varietà di vite maggiormente innestate si trovano in ordine decrescente Chardonnay, Sauvignon, Pinot Nero, Pinot Grigio, Lagrein, Traminer Aromatico e Pinot Bianco.
2.1.5
nutrono di foglie, fiori e frutti di diversespecie di piante. La caratteristica tipica degli scarabeiè che le larve si sviluppano nel terreno e si nutrono delle radici di varie piante. A causa della presenza annuale massiccia di coleotteri adulti, singoli alberi, filari e interi frutteti e campi possono essere divorati da questo insetto In Alto Adige, ogni anno, vengono segnalati al servizio fitosanitario insetti sospetti che assomigliano a questa specie. Finora, tuttavia, dal momento che le segnalazioni non trovano fondamento, non sono mai stati presi provvedimentiin merito.
Negli ultimi anni - ma soprattutto nel 2023 - sono stati segnalati singoli ritrovamenti e nuove infestazioni della popilliaal di fuori delle aree di distribuzione conosciute nell’Italia nord-occidentale. Nel 2023 infatti, sono stati rilevati per la prima volta singoli adulti dell’organismo nocivo prioritario in Trentino, in provincia di
Sondrio, in Veneto e nei Grigioni (CH) Inoltre, una popolazione significativa di oltre 100 coleotteri è stata trovata sulla costaadriatica, in Friuli-Venezia Giulia. Sembra solo una questione di tempo affinché la specie venga rilevata per la prima voltaanche in Alto Adige Questa circostanza è stata sfruttata come opportunità per descrivere dettagliatamente l’insetto e le condizioni generali in questo paragrafo. Il monitoraggio ufficiale della popillia vieneeffettuato in Alto Adige dal 2017 tramite trappole a feromoni, ispezioni visive e campionamenti. All’epoca sono stati sorvegliati 6 siti con trappole e sono state documentate 52 ispezioni visive in campo. Da allora questo monitoraggio è stato ampliato; nel 2023 ad esempio, tra maggio e inizio novembre, sono stateeffettuate circa 260 ispezioni visive su oltre 50 specie di piante e sono stati monitorati 16 siti con trappole. Il Servizio fitosanitario provincialeè stato recente-
mente supportato nel monitoraggio ufficiale dal Centro di consulenza per la fruttiviticoltura dell’Alto Adige, in mododa poter aumentare notevolmente la portata delle indagini. Le ispezioni vengono effettuate in tutto l’Alto Adige ma si concentrano prevalentemente sulle aree di maggiorrischio; queste si trovano in prossimità delle infrastrutture principali, lungo il fiume Adige da Salorno al Burgraviato e nella Valle Isarco fino a Varna. La popillia è uno scarabeo imparentato con il maggiolino comune, la cetonia dorata e il maggiolino degli orti e può essere facilmente confuso con questi coleotteri autoctoni. Gli adulti sono lunghi circa 1 cm, hanno delleelitre corte di colorrame e un corpo verde metallico. I 5 ciuffi bianchi su entrambi i lati dell’addome e i due ciuffi bianchi più grandi nella parte posteriore dell’addome sono i segni distintivi che maggiormente lo differenziano dalle altre specie Le larve appaiono come tipiche larve degli scarabeie possono essere distinte dalle altre specie solo in laboratorio. Si nutrono delle radici di varie graminacee. Le piante ospiti più importanti dei coleotteri adulti sono: le drupacee, le pomacee, le viti, lelatifoglie in generale, il mais, i piccoli frutti, vari ortaggi e cereali. I coleotteriraggiungono nuove aree principalmente come hitchhiker per mezzo di merci commerciali o nascosti in mezzi di trasporto come treni, aerei, automobili

e camion. In generale i coleotteri non volano per più di8 chilometri.
In caso di sospetto, è importante reagire correttamente: l’insetto deve essere catturato o almeno essere fotografato. Il ritrovamento deve
Negli ultimi anni sono stati riscontrati danni alle coltivazioni di patate causati dallelarve degli Elateridi che scavano gallerie, all‘interno dei tuberi, danneggiando il prodotto.
Il Servizio fitosanitario ha effettuato, nell’anno 2023, un monitoraggio con specifiche trappole a feromoni per monitorare la presenza di Elateridi. In totale, nelle 16 trappole a feromoni sono stati catturati 2.217 esemplari, di cui 1.059 della specie Agriotes obscurus.
Nei campi monitorati nel 2023, nell’anno successivovengono piantate patate e rilevati i danni causati dallelarve degli Elateridi con lo scopo di acquisire maggiori conoscenze sull’insetto e sui danni causati da esso.
Produzione di tuberi-seme di patate
I tuberi-seme di patate sono soggetti a severe disposizioninormative, solo così viene garantita la loro qualità per quanto riguarda l’origine, la germinazione, la purezza e la sanità. Prima della raccolta dei tuberi-seme ciascun campo viene controllato almeno una volta dall’Ente responsabile per la certificazione CREA-DC sotto
essere immediatamente segnalato al Servizio fitosanitario, dove gliispettori fitosanitari si occuperanno e analizzeranno il caso.
il profilo fitosanitario, in particolare per i virus e gamba nera
Inoltre, vengono prelevati tuberi-seme da ciascun campo poco prima della raccolta e analizzati in laboratorio per la presenza di virus.
Il Servizio fitosanitario esegue ispezioni visive in campo e in magazzino e preleva tuberi di patate per le analisi di laboratorio per il marciume anulare della patata (Clavibacter michiganensis subsp. sepedonicus), il marciume bruno della patata (Ralstonia solanacearum) e la rogna nera della patata (Synchytrium endobioticum).
I tuberi-seme possono essere coltivati esclusivamente su terreni non contaminati da nematodi cisticoli (Globodera pallida e Globodera ro-
stochiensis). Questo attestato deve essere fornito tramite analisi di laboratorio.
Nell’anno 2023 la Cooperativa Sementi della Val Pusteria ha dichiarato una superficie totale di 106 ettari dedicati alla produzione di patate da seme In base alla composizione del suolo vengono coltivate diverse varietà di tuberi-seme; le più coltivate sono Juwel, Desiree, Spunta e Kennebec.
Contributi in conto capitale per l‘incentivazione delle imprese di elaborazione e di commercializzazione di prodotti agricoli
In base alla Legge Provinciale 11/98 è stato concesso ad un’impresa un contributo in conto capitale del 50% per l’acquisto di semente di alta qualità per la produzione di patate da seme di 65.000,00 euro


Al 31/12/2023 nel Registro Ufficiale degli Operatori Professionali (RUOP) erano iscritte 295 aziende con sede legale in Alto Adige. Il numero delle nuove iscrizioni si è stabilizzato per il secondo anno consecutivo dopo l’introduzione della nuova normativa fitosanitaria europea alla fine del 2019. Si può presumere che nel
frattempo sisiano registrate anche delle imprese che svolgono solo saltuariamente attività che richiedono la registrazione. Nel 2023 sono state registrate nel RUOP 19 nuove imprese. I motivi della prima registrazione sono stati: l’avvio di una nuova attività (1 caso), il rilevamento dell’azienda (4 casi) e il cambio di attività (12 casi), di domicilio legale (1 caso) e di forma societaria (1 caso). Le registrazioni sono state richieste per attività nel settore dell’import/export e per la produzione e/o il commercio di piante da impianto o materiale di propagazione. Inoltre, cinque aziende sono state
autorizzate a emettere il passaporto delle piante Contemporaneamente alle nuove registrazioni, ci sono state anche nove cancellazioni dal RUOP. In cinque casi, l’azienda è stata trasferita o il tipo di azienda è cambiato. Tre aziende sono state cancellate dal registro a causa della cessazione dell’attività.
Riguardo al Passaporto delle Piante, tra novembre e dicembre 2023 sono state controllate 22 aziende; durante questi controlli non sono state riscontrate irregolarità.
In Alto Adige l’agricoltura biologica continua a mantenere un ruolo importante nell’agricoltura provinciale. Negli ultimi anni le superfici coltivate secondo i dettami del metodo biologicocosì come il numero delle aziende sono costantemente aumentate. Solamente nel triennio 2012-2014 si è verificata una diminuzione delle superfici
adibite a foraggicoltura cheè però riconducibile alla nuova digitalizzazione di queste colture.
Nel 2020 e 2021 si è registrato un forte incremento della superficie dedicata alla viticoltura mentre quella dedicata alla frutticoltura ha subito un brusco rallentamento L’incremento di superfici destinate a pomaceee a vite nel
2022 è stato piuttosto modesto e nel 2023 quelle destinate a pomacee hanno subito un calo.
La superficie di terreni biologici nel 2023 ha registrato un incremento del 367% raggiungendo globalmente
58.648 ettari bio. Esso ha interessato soprattutto le superfici a pascolo: si è passati infatti da 4.001 ettari a 49.534 ettari. Tale crescita è riconducibile al sostegno previsto dagliimpegni quinquennali della nuova misura del piano di sviluppo rurale dedicata all’agri-
coltura biologica che prevede per la prima volta pagamenti destinati alle superfici a pascolo alpino.
Superfici adibite a colture frutticole biologiche per comuni al 31.12.2023
Superfici adibite a prati e pascoli biologici per comune al 31.12.2023
2.1.6
Flächenanteile der Kulturarten im Jahr 2023 in Südtirol und Prozentanteile der biologisch bewirtschafteten Flächen.
ha* 38,5%
17.689 ha 14,1% Kernobstbau 116 ha 15,5%
Beerenobstbau 60.976 ha* 9,2%
4.116 ha* 10,4%
Ackerland Ackerfutterbau
& Alm 212 ha 9,8%
Steinobstbau 5.801 ha 9,8%
* Quelle: Landesverzeichnis der landwirtschaftlichen Betriebe (APIA)
norma-
Gli operatori biologici vengono inseriti nell’Elenco degli Operatori Biologici Italiani dalla Ripartizione Agricoltura che gestisce e aggiorna costantemente l’Elenco Esso è suddiviso in tre sezioni e precisamente:
1. produttori
2. preparatori
3. importatori
1. Elenco dei produttori agricoli
In questa sezione viene fatta un’ulteriore suddivisione delle aziende in base al percorso che l’impresa deve effettuare per veder certificata la propria produzione come biologica. Le aziende vengono quindi classificate in:
• aziende agricole biologiche
• aziende agricole biologiche miste (aziende che coltivano contemporaneamente superfici a biologico e convenzionali).
Numero di aziende
Produttori 1.535
Produttori/Preparatori 336
Preparatori 73
Preparatori/Importatori 15
2. Elenco dei preparatori
I preparatori sono gli operatori che nell’esercizio della propriaattività d’impresa esercitano operazioni di trasformazione, di conservazione, di confezionamento, d’etichettatura e di commercializzazione di prodotti biologici vegetali e animali.
3. Elenco delle aziende con importazioni
Gli operatoriiscritti a questa sezione importano prodotti biologici da paesi terzi. Nell’elenco sono iscritte 15 aziende.
Organismi di controllo responsabili della certificazione di produzione biologica operantiin Alto Adige
L’Alto Adige attualmente vede operanti 21 Organismi di Controllo riconosciuti e autorizzati al controllo dell’attività biologica degli operatori. L’efficacia e l’efficienza del controllo svolta da tali Organismi viene valutata dall’Ufficio Meccanizzazione agricola e produzione biologica come autorità provinciale competente Nel 2023 è stata controllata l’attività degli Organismi di Controllo presso gli operatori. L’attività di vigilanza ha interessato inoltre la sede operativa degli Organismi di Controllo.
«« Ulteriori informazioni, le normee la modulistica per le domande sono disponibili sul sito: www.provincia.bz.it/agricoltura/ E-Mail: notificabio@provincia.bz.it biomeldung.notificabio@pec.prov.bz.it
Aziende
Aziende
Aziende che operano nel settore biologico in Alto Adige suddivise per tipo di attività (dati del 2023)
Tipo di aziendaAnzahl
Produzione e commercializzazione di frutta e ortaggi86
Produzione di succhi di frutta e vegetali 34
Produzione e commercializzazione di carnee prodotti a base di carne 35
Produzione di prodotti lattiero-caseari20
Produzione di prodotti da macinatura di cereali e di pasta12
Produzione di pane e di prodotti da pasticceria41
Commercializzazione di prodotti alimentari 109
Negozi con prodotti alimentari esclusivamente biologici4
Trasformazione di tè o caffè 20
Produzione e commercializzazione di vino, vino spumante 46
Produzione di bevande alcoliche6
Ristorazione 13 Produzione e commercializzazione di sementi / piantine 8 Varie 15



I beni di uso civico (beni gravati da diritti di uso civico) di proprietà di frazioni o comuni sono per la maggior parte costituiti da boschi, pascoli e malghe.
I diritti di uso civico consistono prevalentemente in diritti di pascolo e legnatico.
Sono titolari del diritto di uso civico i cittadini residenti nella relativa frazione o nel relativo comune. Caratteristica dei beni di uso civico sono l’inalienabilità e l’inusucapibilità. Solo in casi eccezionali (regolamento di confine, area accessoria, ecc.) e per superfici minime sono possibili

Il maso chiusoCommissioni locali e commissione provinciale per i masi chiusi
Nella Provincia di Bolzano sono costituite 136 commissioni locali per i masi chiusi che sono nominate ai sensi dellalegge provinciale sui masi chiusi (L.P. 17/2001) dalla Giunta provinciale su proposta del consiglio direttivo dell’associazione degli agricoltori per il periodo di 5 anni. Essesono composte da un presidente e due membri. L’autorizzazione della commissione locale per i masi chiusi deve essere richiesta per tutte le modifiche della consistenza del maso chiuso nonché per la costituzione e lo svincolo di un maso chiuso La costituzione e lo svincolo di masi chiusi e la scorporazione di costruzioni di qualsiasi genere (comprese cubature, diritti di costruzione o parti di fabbricati) de-
alienazioni di beni di uso civico previo parere positivo dell’assessore provinciale all’agricoltura, sempre premesso che con l’alienazione non venga lesosostanzialmente l’esercizio dei diritti di uso civico In tali casi nell’anno 2023 sono stati emessi 182 pareri.
Le associazioni agrarie sono comunioni private di interesse pubblico, anche esse prevalentemente costituite da boschi, pascoli e malghe. Pressoché 700 associazioni agrarie sono iscritte nell’elenco ufficiale. Le alienazioni di terreni, i trasferimenti e suddivisioni di quote di comproprietà nonchè altri provvedimenti devono essere approvati dall’Ufficio Proprietà coltivatrice In tali casi nell’anno 2023 sono stateemesse 70 approvazioni.
Sia nell’ambito dei beni di uso civico che in quello delle associazioni agrarie nel Libro fondiario vengono eseguite rettifiche e integrazioni
Inoltre in questi settori si effettua un’intensa attività di consulenza
vono essere autorizzate anche dalla Ripartizione agricoltura. Nell’anno 2023 sono stateesaminate 206 autorizzazioni delle commissioni locali per i masi chiusi In totale sono state autorizzate 9 costituzioni di masi chiusi (3 con e 6 senza sede aziendale)e 14 masi chiusi sono stati svincolati.
La commissione provinciale per i masi chiusi è nominata dalla Giunta Provinciale per il periodo di 5 anni edè composta dal presidente e da ulteriori 4 membri. Presidente della commissioneè l’assessore pro tempore all’agricoltura, mentre i membri sono un magistrato, un esperto in agricoltura, un agricoltoree una rappresentante dell’associazione agricoltori e coltivatori diretti sudtirolesi.
Nell’anno 2023 la commissioneprovinciale ha trattato 9 ricorsi.

Costituzioni di masi chiusisenza sede aziendale
Costituzione di masi chiusi con sede aziendal
Svincoli di masi chiusi
La denominazione di“maso avito” può esserericonosciuta ad un maso chiuso cheè stato tramandato da almeno 200 anni all’interno della stessa famiglia e che viene coltivato e abitato dal proprietario stesso. Per la verifica storica è stato incaricato l’archivio provinciale di Bolzano. L’attribuzione avviene tramite decreto dell’assessore all’agricoltura
Dall’entrata in vigore dellalegge provinciale n. 10 del 26 aprile 1982 fino all’anno 2023 sono state presentate all’ufficio competente 1.612 domande, di cui 8 nell’anno stesso. In totale sono stateevase positivamente 1.213 istanze, di cui 7 nell’anno 2023. stemma

Secondo quanto disposto dallalegge sull’affitto di fondi rustici n. 203/82, in caso di vertenze relative al rapporto di locazione è necessario esperire in primo luogo un tentativo di accordo extragiudiziale. A tale scopo è istituita presso la Ripartizione Provinciale Agricoltura una commissione di conciliazione presso l’ufficio proprietà coltivatrice Tale norma di risoluzione delleliti è prevista a livello statale,ed in Provincia di Bolzano viene applicata con successo.
La procedura di conciliazione, attraverso il colloquio direttotra le parti e con l’assistenza specializzata fornita da esperti nella specifica materia, ha lo scopo di raggiungere un accordo, evitando così l’avvio di una vertenza giudiziaria.
Insediamento di giovani agricoltori
Promuovere l’insediamento dei giovani agricoltori è uno degli interventi del Piano Strategico Nazionale della PAC 2023-2027. Questo programma è finanziato congiuntamente dall’Unione Europea, dallo Stato Italiano e dalla Provincia Autonoma di Bolzano – Alto Adige. Il finanziamento è destinato a facilitare l’avvio dell’attività agricola da parte dei giovani agricoltori e a promuovere il ricambio generazionale. A seconda dei punti di svantaggio che un’impresa presenta, l’incentivo ammonta a un importo compreso tra 7.500,00 e 33.000,00 euro
professionale quale persona fisica, anche ove socio e/o amministratore di societàagricole, deve iscriversi nella gestione previdenzialeed assistenziale per l’agricoltura.
Nell’anno 2023 sono state presentate 34 domande per il riconoscimento della qualifica di “imprenditore agricolo professionale” o “società agricola”. 19 domande sono stateevase con esito positivo, 1 domanda è stata respinta e 3 domande sono state ritirate.
«« Ulterioriinformazioni, le normee la modulistica per le domande sono disponibili sul sito: www.provincia.bz.it/agricoltura/ E-Mail: proprieta.coltivatrice@provincia.bz.it lweigentum.agriproprieta@pec.prov.bz.it
Convenzione
La legge provinciale sulla caccia del 17.07.1987, n. 14, dispone che l’ammontare dei danni causati dalla fauna selvatica viene determinato ed indennizzato secondo i termini e le modalità di una convenzione stipulata tra i rappresentanti delle riserve di caccia ed i rappresentanti dei proprietari dei fondi. In caso di mancato raggiungimento di un accordo amichevole tra la parte danneggiata e la parte obbligataal risarcimento, l’Amministrazione provinciale incarica un perito per l’effettuazione della stima del danno Avverso tale stima può essere proposto ricorso alla Commissione provinciale per la determinazione dei danni da selvaggina Il Presidente della commissioneè il direttore dell’ufficio proprietà coltivatrice affiancato da un rappresentante dei cacciatori e dei proprietari dei terreni.
Sono ammessi i giovani agricoltori con idonea qualifica professionale che hanno iniziato la loro attività da non più di un anno al momento della presentazione della domanda (apertura della posizione IVA in agricoltura).
Gli acquirenti di masi chiusi possono richiedere la sovvenzione. Le altre aziende devono disporre di una superficie minima di 1 ha di colture permanenti o di 2 ha di seminativo o prato permanente
Al momentodella presentazione della domanda, i giovani agricoltori devono presentare un piano aziendale che specifichi le iniziative relative a investimenti, consulenze e formazionenei due anni successivi alla concessione del sostegno L’UE attribuisce particolare importanza ai temi dell’efficienza economica, della sostenibilità, delle tecnologie dell’informazione e della comunicazione. Nel 2023 sono stati concessi 4.071.000 euro a 187 giovani agricoltori.
Le agevolazioni fiscali e altri benefici in agricoltura vengono concessi a „imprenditori agricoli professionali“ e a“societáagricole“ in possesso dei requisiti stabiliti dal decreto legislativo 29/03/2004, n. 99, e successive modifiche. L’imprenditore agricolo
Per le aziende che successivamente alla prima classificazione abbiano migliorato qualitativamente l’azienda, il legislatore prevede la possibilità di richiedere una nuova classificazione.
In totale dal 2005 fino al 31.12.2023 sono state classificate 3.040 aziende agrituristiche nel seguente modo:




Il decreto del presidente della provincia del 27 agosto 1996, n. 32 e.s.m. regolal’affitto di appartamenti per ferie e camere per ospiti e le modalità di classificazione delle aziende agricole (attribuzione fiori) che svolgono l’attività agrituristica ai sensi della legge provinciale n. 7, del 19 settembre 2008 e.s.m..





Nell’anno di riferimento sono stati concessi contributi per investimenti per un importo di 1.500.000 euro a 33 aziende.

nel settore agricolo
Interventi a favore dell’agricoltura
Nell’anno 2023 sono state presentate ai sensi dellalegge provinciale del 14 dicembre 1998, n. 11 e.s.m., 334 nuove domande per la concessione di contributi I progetti presentati dalle aziende agricole riguardano in prima linea case d’abitazione, stalle, fienili, ricoveri per macchineed attrezzi e strade poderali.
Programma di Sviluppo Rurale 2014 – 2022 della Provincia di Bolzano Regolamento (UE) n. 1305/2013
La sottomisura 4.1 “Sostegno agli investimenti nelle aziende agricole” prevede la promozione esclusiva degliinvestimenti nelle aziende zootecniche a prevalente produzione di latte. Il programma di sviluppo è nella sua fase finale. La misura è stata chiusa nel

2022 e pertanto non è stato possibile presentare nuove domande di aiuto.
Nel 2023 si è proceduto conla liquidazione dei contributi precedentemente concessi.
Sono state liquidate 17 domande per “fondi TOP-UP” per un importo di 2.646.658,53 euro, 9 domande per “fondi COF” per un importo di 1.389.739,50 euro e 17 domande per“fondi EURI” per un importo di 3.184.465,25 euro.
Piano strategico nazionale
della PAC 2023-2027
L’intervento SRD01 “Investimenti in strutture produttive per aumentare la competitività delle aziende agricole” promuove il miglioramento delle condizioni di allevamento del bestiame per la produzione di latte e carne nelle zone montanee mira adaumentare la competitività delle aziende agricole e ad incrementare la lororedditività, migliorando al contempo leloro prestazioni climatiche ambientali. L’intervento ha un budget di 11.413.618,60 euro di spesa pubblica (cofinanziato).
Nel anno 2023 sono state presentate 22 domande di aiuto.
Consorzi
Nell’anno 2023 sono stati concessi contributi per gliinvestimenti ai consorzi di bonifica per un totale di 2.192.840,00 euro per gli esercizi finanziari 2023 e 2024 e a consorzi di
miglioramento fondiario per un totale di 2.153.920,00 euro per gli esercizi finanziari 2023, 2024 e 2025.
Contributi ai consorzi di bonifica
L’articolo 31, comma 5 dellalegge provinciale 28 settembre 2009, n. 5 e.s.m., prevede la concessione d’aiuti per la manutenzione ordinaria e l’esercizio delle opere di bonifica di interesse provinciale. Sono stati concessi contributi per la manutenzione ordinaria e l’esercizio delle opere di bonifica di interesse provinciale nonché contributi ai consorzi di bonifica per le spese di gestione per un importo di 1.362.294,87 euro.
Durante l’anno di riferimento sono state presentate 10 domande.

Consorzi di bonifica e di miglioramento fondiario
L’Ufficio Edilizia Rurale svolge la vigilanza sui consorzi di bonifica e di miglioramento fondiario. Nell’ambito di questi compiti l’ufficio nel 2023 ha provveduto al controllo dei bilanci dei consorzi di bonifica dell’Alto Adige e della Federazione provinciale dei consorzi di bonifica, di irrigazione e di miglioramento fondiario. Inoltre ha autorizzato le modifiche delle loro proprietà immobiliari.
Nell’anno 2023 sono stati ampliati o ridelimitati 5 consorzi e per 2 consorzi di miglioramento fondiario è stato approvato il nuovo statuto. Attualmente nella Provincia di Bolzano esistono 289 consorzi di miglioramento fondiario, cinque consorzi di bonifica e un consorzio di bonifica di II grado.
Inoltreè stato emesso 1 decreto del direttore d’ufficio per la revoca parziale del vincolo di indivisibilità ventennale nell’ambito di ricomposizioni fondiariee piani di rettificazione.
Sono state inoltre convocate due sedute del comitato tecnico per la bonifica.
«« Ulterioriinformazioni, le normee la modulistica per le domande sono disponibili sul sito: www.provincia.bz.it/agricoltura/ e-mail: edilizia.rurale@provincia.bz.it lwbauwesen.agriedilizia@pec.prov.bz.it

2.1.8
Rientrano nelle competenze dell’Ufficio meccanizzazione agricola e produzione biologicaanche la tenuta e l’aggiornamento continuo dello schedario delle macchine agricole, la consulenza, l’immatricolazione ed i passaggi di proprietà e l’assegnazione del carburante agevolato. Inoltre, l’ufficio concede contributi a fondo perduto per l’acquisto di macchine agricole e le relative attrezzature, con particolare riguardo a quelle de-

Incentivazioni per l’acquisto di macchine agricole e carburante
L’Ufficio meccanizzazione agricola e produzione biologica è stato anche nel 2023 un interlocutore per le agevolazioni per l’acquisto di macchine agricole e l’assegnazione di carburante agevolato.
Contributi a fondo perduto
A partire dal 01/01/2023 fino al 31/03/2023 è stato nuovamente possibile presentare le domande di aiuto per l’acquisto di macchineed attrezzature agricole per l’anno 2023. In questi 3 mesisono state presentate 833 domande per un totale di 969 progetti, di cui 598 riguardanti la meccanizzazione esterna e 371 la meccanizzazione interna. Sono state approvate 768domande con una spesaammissibile di 22.736.050,00 Euro, concedendo contributi pari a 6.216.655,00 Euro, destinatiin particolar modo all’acquisto di motofalciatrici, spingifieno e falciatrici a due assi per il settore della meccanizzazione esterna, mentre
stinate ad un impiego extraaziendale nell’ambito di un’associazione utenti macchine agricole.
Nel 2023 sono state immatricolate 481 trattrici nuove, 274 rimorchi nuovi, 15 macchine agricole semoventi nuove e 192 trainate Per 286 macchine agricole è stata fatta richiesta di demolizione o esportazione e sono stati emessi 2839 duplicati di carte di circolazione, inclusii passaggi di proprietà. Le reimmatricolazioni di macchinari sono state 27, mentre sono state fatte 496 richieste per l’emissione di targhe ripetitrici. I richiedenti si sono recati anche presso le agenzie automobilistiche che hanno redatto ulteriori 147 targhe per trattrici agricole, 25 per rimorchi e 11 per macchine agricole semoventi, così che nell’anno 2023 sono state rilasciate in totale 643 targhe per trattrici.
«« Informazioni dettagliate sul parco macchine agricole in Alto Adige, acquisto di trattrici nuove, nonché la media dei CV delle trattrici vedi tab. 15, 16 e fig. 10 da pag. 208 a pag. 209.
per il settore della meccanizzazione interna l’incentivazioneha supportato soprattutto l’acquisto di gru per il fienile, impianti per l’asporto delletame e macchinari per l’areazione del fieno.
Carburantee combustibile agevolato
Nel 2023 sono stati assegnati a 11.737 aziende agricole complessivamente 29.943.415 litri di gasolio e 404.575 litri di benzina.
«« Ulterioriinformazioni, le normee la modulistica per le domande sono disponibili sul sito: www.provincia.bz.it/agricoltura/ E-Mail: llamagr.bio@provincia.bz.it lamagr.bio@pec.prov.bz.it
informativo agro-forestale (SIAF) e gestione dell’Anagrafe provinciale delle imprese agricole
Il Sistema informativo agro-forestale (SIAF) è lo strumento informativo per la gestione dell’Anagrafe provinciale delle aziende agricole.
L’Anagrafe provinciale contiene tutte le imprese agricole con sede sul territorio della Provincia Autonoma di Bolzano – Alto Adige, oppure lavorano terreni agricolinella provincia. Le informazioni raccolte nell’anagrafe sonola base per i pagamenti di aiuti comunitari, statali e provinciali, oltre
Incentivazione per il trasferimento di conoscenze ed azioni di informazione nonché per servizi di consulenza in agricoltura Nell’anno 2023 sono stati concessi ai sensi della L.P. 14/12/1998 n. 11 adasso-
ad essere un punto di riferimento nei rapportitra l’amministrazione pubblica e le imprese agricole. Inoltre, i dati contenuti sono messi a disposizione delle amministrazioni statali, dell’Organismo pagatore della Provincia, i comuni, oltre a varie organizzazioni attive nel settore agricolo (associazioni di categoria e di consulenza, organizzazioni di produttori, ecc.). Tutti i dati gestiti nell’Anagrafe provinciale delle imprese agricole che sono rilevanti per il fascicolo aziendale vengono continuamente sincronizzati nel sistema informativo agricolo nazionale (SIAN).
L’ anagrafe contiene tra l’altro le seguenti informazioni:
- dati anagrafici delle imprese agricole - -dimensione totale delle superfici, dimensione dei terreni coltivati, titolo giuridico dei terreni coltivati, dati catastali, ed inoltre i seguenti dati di dettaglio:
• delle superfici coltivate a melo
• delle superfici vitivinicole
• delle categorie di premi per la tutela del paesaggio
- punti di svantaggioe
- consistenza bestiame e carico bestiame
- giorni alpeggio e carico alpeggio
- superfici foraggere calcolate
ciazioni ed organizzazioni agricole, per leloro attività di scambio di conoscenze ed azioni di informazione nonché per i servizi di consulenza, contributi per un importo pari a € 4.251.500,00.
Incentivi per il ripristino e l’indennizzo didanni causati da avversitàatmosferiche
Al 31/12/2023 l’anagrafe contava 28.566 aziende con coltivazione di terreni agricoli o forestali oppure allevamento di bestiame. Nel corso dell’anno 2023 sono state variate i dati di 16.960 imprese (variazioni di superfici, di titoli di conduzione, variazioni in base a nuova ortofoto, ecc.)
Tentativi di conciliazioni ai sensi della legge sui masi chiusi
Chiintende proporre in giudizio una domanda relativa al diritto vitalnatural durante a un adeguato mantenimento secondo le condizioni di vita locali e la capacità produttiva del maso chiuso,
«« Ulterioriinformazioni, le normee la modulistica per le domande sono disponibili sul sito: www.provincia.bz.it/agricoltura E-Mail: apia.lafis@provincia.bz.it lafis.apia@pec.prov.bz.it
Nell’anno 2023 sono state compensate con un sostegno finanziario diversesituazioni d’emergenza derivanti da frane o inondazioni.
«« Ulterioriinformazioni, le normee la modulistica per le domande sono disponibili sul sito: www.provincia.bz.it/agricoltura/ E-Mail: lamagr.bio@provincia.bz.it lamagr.bio@pec.prov.bz.it
calamità n° domande contributi concessi in euro calamitá naturali 99 1.188.705,00
alla successione suppletoria, all’integrazione della quota riservataai legittimari o alla divisioneereditaria, nei casi in cui il maso chiuso costituisca parte dell’asse ereditario, oppure proporre in giudizio una domanda di usucapione del diritto di proprietà di un maso chiuso o parte di esso oppure concernente la determi-
nazione dell’assuntore o dell’assuntrice del maso chiuso e la determinazione del prezzo di assunzione è obbligato a esperire un tentativo di conciliazione presso la Ripartizione Agricoltura. Nell’anno 2023 sono state presentate 23 domande per l’esperimento di un tentativo di conciliazione.

Metà della superficie provinciale in Alto Adigeè coperta dal bosco – di cui ca. il 58% è bosco montano con funzione protettiva diretta che svolge un’azione a tutela del suolo dall’erosione e delle zone abitate da slavine, caduta massi e colate detritiche. Solamente un bosco di protezione sano, ecologicamente stabile può svolgere efficacemente le sue funzioni, al contrario invecchiamento, mancata rinnovazione e pressione da selvaggina (ungulati) ne compromettono le prestazioni. Anche lo stato e lo sviluppo degli alpeggi riveste in Provincia di Bolzano grande valenza ecologica e culturale. Questi paesaggi culturali unici rappresentano elementi di inestimabile valore naturale e ricreativo per la società del giorno d’oggi. La fruizione delle malghe deve tuttavia tener conto delle esigenze ecologiche e della limitata stabilità di queste sensibili zone alpine.
Ai Servizi Forestali, ovvero alla Ripartizione provinciale Servizo forestale sono demandate esclusivamente competenze e funzioni di carattere istituzionale. In quanto autorità responsabile del settore foreste, caccia e pesca, i Servizi Forestali sono attivi su oltre il 90% del territorio provinciale.
L’ Agenzia demanio provinciale al contrario è responsabile per gli aspetti operativo-gestionali delle superfici montanee boscate di proprietà provinciale, che copre ca. il 10% della superficie dell’Alto Adige.

La Ripartizione Servizio forestale provvede ad una durevole ed equilibrata gestione e conservazione degli habitat naturali, in particolare di boschi, pascoli, malghe e delle acque. L’assistenza qualificata e professionale contribuisce a minimizzare i conflitti di interesse, così da garantire la tutela e la conservazione di questi habitat. Il contatto diretto con la popolazione e la sorveglianza di tutto il “territorio naturale” – aree rurali, boschi, pascoli e pascoli alberati, verde alpino, ghiacciai e rupi – consentono di prevenire la commissione di numerosi reati.
I nostri boschi e le malghe, creati da una decennale gestione sostenibilee naturalisticaassieme ai massicci montuosi costituisconooggi un elemento di valorizzazione straordinaria del paesaggio culturale altoatesino. Rilevanzaancora maggiore spetta peró alla funzione protettiva del paesaggio boschivo e alpicolo - intatto e stabile; colui garantisce la sicurezza del nostro spazio vitale in montagna. Gli avvenimenti catastrofici dell’ ultimo anno hanno rilevato con massima chiarezza la sensibilità e fragilità dell`ambiente alpino.

L'Alto Adigeè una regione montana; lo testimonia il fatto che ben il 40 % della superficie è collocata al di sopra dei 2.000 m s.l.m. Nel rispetto dellalegge forestale, che prevede la tutela dei terreni di qualsiasi natura e destinazione d’uso, più del 90 % della superficie provinciale è sottopostaa vincolo idrogeologico-forestale. Questo vincolo si pone come obiettivo la conservazione della stabilità delsuolo e il regolare deflusso delle acque per garantire la tutela di aree particolarmente suscettibili, ma va anche oltre sostenendo una gestione attenta dei boschi, dei prati e dei pascoli di mon-
tagna, il loro miglioramento, la conservazione degli ecosistemi e della fauna e della flora che li popolano. Tutto ciò viene perseguito per garantire un elevato livello di tutela per la natura e il paesaggio altoatesini. Gli abitati, la rete stradale e le colture intensive non sono invece sottoposti a questo vincolo.
Secondo i risultati ufficiali del terzo Inventario Nazionale Forestale (INFC 2015 – Inventario Nazionale delle Forestee dei serbatoi forestali di Carbonio) l’Alto Adige è coperto per 339.270 ha da bosco e per 36.081 ha da „altre terre boscate” (terreni boscati che
non rientrano nei parametri della categoria precedente).
Secondo l’Inventario Forestale Nazionale la definizione di bosco é quella di una superficie coperta da specie arboree, di estensione superiore ai 5.000 m², larghezza massima maggiore di 20 m, altezza media delle piante maggiore di 5 m e un grado di copertura delle chiome superiore al 10 %.
Per altre terre boscate si intendono, invece, le superfici coperte da specie arboree con estensione superiore a 5.000 m², larghezza massima superiore a 20 m, con altezza media delle piante compresa fra 2 e 5 m e grado di
copertura delle chiome superiore al 10 % (gli arbusteti di alta quota, come le mughete) oppure, in alternativa, con altezza superiore a 5 m e grado di co-
pertura delle chiome compreso fra il 5 e il 10 % (i cosiddetti “boschi radi”). Per la classificazione della superficie boscata in base alla tipologia di pro-
Superficie boscata secondo le tipologie di proprietà
prietà e di specie presenti, si fa riferimento alla banca dati della Ripartizione Provinciale Foreste:
Proprietà singola
Enti pubblici Comproprietà






Composizione percentuale delle specie presenti































In un territorio montano come quello della provincia di Bolzano, l’azione protettiva svolta dai boschi è di fondamentale importanza per qualsiasi attività umana. Se si considera l’azione di protezione del bosco in riferimento ai fenomeni valanghivi, di caduta massi e di regimazione delle acque, si può affermare che ben il 58 % della superficie boscata (197.000 ha circa) ricade in aree con una prevalente funzione protettiva Di questi, il 24% dei boschi è collocato direttamente a monte di infrastrutture (es. strade e ferrovie) ed insediamenti, svolgendo quella che viene definita funzione eteroprotettiva.
Il bosco dell’Alto Adige in cifre
bosco
339.270 ha provvigione
116.443.137m3 * 343,2m3/ha* incremento per anno
2.000.689m3 *5,9m3/ha* legno morto
8.494.151m3 25,0m3/ha ripresa per anno
809.88m3 **
m3 = metri cubi
* i valori sono riferiti a >= 4,5 cm diametro a petto d’uomo (1,30 m)
** i valori sono riferiti a >= 17,5 cm diametro a petto d’uomo (1,30 m)
Fonte dei dati: MIPAAF/CRA-ISAFA Inventario Nazionale Forestalee dei serbatoi di carbonio [INFC 2015], dalla banca dati forestale provinciale 2022 (Forest.Management@provinz.bz.it).
Ulteriori dati sul bosco in Alto Adigeè sul sito www.provincia.bz.it/foreste.

In Alto Adigeesistono ca. 1.700 alpeggi attivi. Ben oltre 2/3 sono alpeggi privati,il 20% sono proprietà di interessenzee in comproprietà, altri 8% fanno parte di enti pubblici, quali Comuni e Amministrazioni S.B.U.C. Una piccola parteè di proprietà del demanio, di enti ecclesiastici ed altri. Le proprietà in provincia divergono storicamente presentando in Val Venostaa ponente di Naturno poche, malghe molto grandi, solitamente di
proprietà di Comuni o Amministrazioni S.B.U.C. e invece ad oriente di Naturno, compresa la Val Senales, quasi tutta la superficie e anche la maggioranza numerica delle malghe è in proprietà di privati o è in comproprietà Ad esempio, nel Comune di Malles e in quello di Sarentino vengono alpeggiati all’incirca la stessa quantità di UBA (2.400 UBA a Malles e 2.200 UBA a Sarentino nel 2023), a Malles gli animali vengono gestitiin 19 diversi alpeggi, mentre in Val Sarentino sono distribuiti su non meno di 135 alpeggi. Nell’anno scorsosu ben 1.400 alpeggi ogni anno sono stati monticati bovini, ovini o caprini. Sugli alpeggi più piccoli solo pochi capi, nelle malghe più grandi oltre 100 UBA, in 20 malghe altoatesine vengono monticate più di 200 UBA.
Contrariamente al leggero aumento del numero di bovini alpeggiati, lo scorso anno il numero di alpeggi con bovini è diminuito notevolmente Mentre diminuiva il numero delle malghe con pochissimi animali, nelle grandi malghe si contavano più animali al pascolo degli anni scorsi.
63 % delle malghe altoatesine, complessivamente 845 unità, contano meno di 20 UBA. In queste piccole, ma paesaggisticamente caratteristiche malghe troviamo ca. il 16% di tutti gli animali alpeggiati.
Il numero delle malghe da latte negli ultimi due anni sono calate notevolmente. In 62 malghe altoatesine nel 2023 vengono monticate almeno 5 vacche da latte in lattazione, in 41 malghe piú di 15. Nel anno 2021 erano ancorarispettivamente 70 e 45 alpeggi.
2023 nel territorio provinciale, il numero di bovini alpeggiati è aumentato in modo significativo e ha raggiunto il livello più alto degli ultimi cinque anni L’anno scorso circa 44.200 bovinihanno trascorso più di 30 giorni in uno degli alpeggio altoatesini. Rispetto all'anno precedente sono stati monticati circa 1.850 bovini in più, la maggior parte dei quali manze e manzetti di età inferiori ai 2 anni. Ciò è dovuto probabilmente al premio per il benessere degli animali recentemente introdotto.
Il numero totale di pecore alpeggiate è diminuito di circa 1.050 capi lo scorso anno Rispetto all'anno precedente, è stato alpeggiato un numero significativamente maggiore di giovani animali anziché di pecore adulte. Il numero di capree cavalli alpeggiati a livello provinciale è aumentato ancora leggermente.
Nell’anno 2023 sono state registrate 87.300 movimentazioni di bestiame in malga.
Inoltre sono da conteggiare ca 1.950 cavalli ed asini e nomerosi altri animali d’allevamento.
Confrontando i dati geografici delle diverse specie alpeggiate si possono ricavare le seguenti considerazioni: per quanto riguarda i bovini, soprattutto i bovini in asciutta non ci sono grosse differenze geografiche. Diversamente è la monticazione degli ovini, che infatti vengono alpeggiati maggiormente nei settori occidentali dell’Alto Adige.
Nei caprini questa concentrazione è ancor più evidente: quasi la metà dei caprini sono alpeggiati nel distretto di Merano e precisamente in Val Passiria e nel Gruppo di Tessa Anche in Val Venosta e in alta Val d’Isarco vengono monticate molte capre. Diversamente, nella parte orientale dell’Alto Adige, nei distretti di Bressanone, Brunico e Monguelfo vengono alpeggiati solo pochi caprini.

Il

Le grandi malghe sul Renon, sull’Alpe di Villandro, in Val Sarentino e nel Comune di Curon in Val Venosta sono i luoghi preferiti per il soggiorno estivo dei cavalli.
Considerato l’alto numero di progetti finanziati nel settore alpestre si dedu-
ce la grande importanza dell’alpeggio in Alto Adige. Annualmente in media vengono erogati contributi pubblici per lavori inerenti agli alpeggi di ca. 2.000.000 euro. Negli anni tra il 2019 e la fine del 2022 non è più stato possibile presentare domande di contribu-
to all’Ufficio Economia Montana. Nel 2023 sono stati presentati complessivamente 64 nuovi progetti per l’alpicoltura, le stime dei costi ammontano a ~€ 10.846.000.

Negli anni a venire la protezione dai grandi carnivori delle greggi di ovi-caprini e delle mandrie di bovini avrà un’importanza sempre maggiore La protezione delle mandriee greggi però è molto dispendiosa e necessita di molta preparazione. La protezione da grandi carnivori necessita imprescindibilmente di un pascolo organizzato e controllato. Le
greggi di pecore necessitano, per essere protette dallupo, della presenza costante di un pastore, che con l’aiuto dei cani da pastorizia riesca a portare in appositi recinti gli ovini nelle ore notturne. In alternativa il perimetro del pascolo deve essere delimitato con apposito recinto elettrificato. Solo in poche malghe le greggi ovine vengono continuamente sorvegliate dei pastori e possibilmente delimitate in un apposito recinto nelle ore notturne. Attualmente in Alto Adige scarseggiano pastori con cani da pastorizia addestrati, anche le baite per pastori
in molti luoghi sono in pessimoi stato o addirittura mancano.
Nell’anno 2023 sono state inoltrate 22 nuove domande di contributo per la costruzione di recinti di protezione. Con questo materiale vengono eretti in posizioni favorevoli dei recinti per la stabulazione notturna delle greggi Dall’anno 2020 la percentuale di contributo per la messa in opera di recinzioni di protezioni è passata dal 70 al 100%. Il prezzo standard per l’acquisto, il trasporto e il posizionamento del recinto di protezione è rimasta invariata a 8,00 € a metro lineare.

In provincia di Bolzano gli alberi possono essere tagliati o prelevati dal bosco solamente dopo essere stati precedentemente assegnati dal personale forestale mediante la cosiddetta “martellata”. Le piante destinate al taglio vengono sceltetenendo conto della possibilità del bosco di rinnovarsi naturalmente e cercandodi conferire ai popolamenti forestali anche stabilità e resistenza.
L’assegno delle piante rappresenta per il forestale un’importante occasione di consulenza con il proprietario boschivo In occasione di ogni martellata si redige un verbale d’assegno, nel quale si documentano fra l’altro dati e prescrizioni per conferire l’autorizzazionee la successiva utilizzazione. Quando viene fatta la martellata normale il proprietario può, assieme all’autorità forestale competente, accordarsi sul legname da prelevare.

Nel caso di eventi calamitosi (vento, neve, bostrico), invece, il proprietario boschivo perde questa capacità edè costretto a concentrare le utilizzazioni solo sulle piante colpite. Nonostante ciò, il legname danneggiato prelevato dal bosco dev’essere quantificato, classificato e registrato per poter aggiornare le banca dati provinciale sulle
provvigioni, così da predisporre una migliore pianificazione e una gestione forestale accorta. Tuttii verbali d’assegno vengono archiviati periodicamente nella banca dati della Ripartizione Foreste, dando così la possibilità di elaborare delle statistiche che tengano traccia dell’andamento inter-annuale delle utilizzazioni.
2.000.000
Nel corso del 2023 sono stati effettuati complessivamente 12.233 assegni (martellate) di taglio. La quantità di legname assegnata mediante “martellata” è stata pari a 1.713.514
m³ Le specie maggiormente utilizzate sono state l’abete rosso (93,8%), il pino silvestre (1,6%) e il larice (2,6%).
Le latifoglie sono state interessate da assegni di taglio per una quota
pari al 0,6% rispetto alla massa complessiva.
«« In tab. 18 a pag. 211 sono visualizzate le utilizzazioni 2022 per ispettorati forestali e le specie arboree assegnate nell’anno 2023.
Dopo l’evento calamitoso Vaia, avvenuto nell’ottobre del 2018, a prevalere sono nettamente le utilizzazioni di legname susuperfici colpite da cala-
mità. Dal 2018 in provincia di Bolzano sono stati utilizzati ca. 8,2 milioni di metri cubi lordi di legname; di questi, ca. 6,7 milioni di metri cubi si ri-
feriscono al legname danneggiato, mentre i restanti 1,5 milioni di metri cubi alle utilizzazioni normali. Queste ultime sono quelle rientranti nelle ca-
*Banca dati forestale provinciale, aggiornato al 31.12.2023
*Banca dati forestale provinciale, aggiornato al 31.12.2023
tegorie martellata normale, tracciati per le strade, tagli colturali, cambi di coltura,altri.
Nella statistica per tipologia di taglio gli effetti degli eventi calamitosi risultano evidenti nelle rispettive colonne
(schianti da neve, schianti da vento, attacchi parassitari).
Tipologie d’esbosco nel 2023

28,5% Teleferica <300m





45% Verricello
15,7% Teleferica >300m



8,5% Trattore






2,0% Altro
2,0 %





3 %
0,3% Harvester/ Forwarder

<<< Per maggiori informazioni si rimanda allahomepage della ripartizione foreste: Assegni al taglio | Bosco, legno, malghe | Provinciaautonoma di Bolzano - Alto Adige

In Alto Adige sono tradizionalmente impiegate varie forme di esbosco, in relazione alla morfologia molto variabile del territorio ed in relazione all’accessibilità delle aree forestali. Le tipologie d’esbosco maggiormente diffusesonol’esbosco con verricello, teleferica e con trattore.
a) Piani di gestione silvo-pastorali
La redazione di piani di gestione silvo-pastorali è regolata dall´art. 13 della L.P. del 21 ottobre 1996, nr 21 (legge forestale). L'articolo 20 di questa legge prevede per la redazionee la revisione dei piani di gestione contributi fino ad un massimo del 50% dell'importo di spesa riconosciuta.
Nell'anno 2023 sono stati revisionati 27 piani di gestione, di cui 17 sono stati ammessi a finanziamento per un ammontare complessivo di contributi pari a 78.405,67 Euro
b) Piano di sviluppo rurale 2014-2020 – Sottomisura 8.5.1: Investimenti per aumentare la resilienza di ecosistemi boschivi – investimenti selvicolturali.
Con questa misura vengono incentivati interventi di miglioramento boschivo susuperfici di minimo 1 ha Nel 2023 sono stati liquidati 53 diradamenti con un aumentare contributivo di ~120.000,00 Euro.
A queste vanno aggiunte 18 misure per diradamenti con un valore compessivo di ~28.000,00 Euro, che sono state finanziate da fondi provinciali
c) Programma di sviluppo rurale 20142020: misura 8.3.B2: Sostegno alla prevenzione dei danni arrecati alle foreste da incendi, calamità naturali ed eventi catastrofici – aiuti per la rimozione rispettosa dellegname di piante morte, deperite o danneggiate. In boschi in condizioni stazionali estremee in casi accessibilità boschiva insufficiente, i costi di rimozione del legname superiori sono supportati dall’aiuto maggiore Si tratti dunque di un aiuto graduale per la rimozione rispettosa dal terreno di legname di piante morte, deperite o danneggiate. Nell’anno 2023 sono state finanziate 1.918 richieste di contributo con un

2.97910.750.000,00
6.889*31.830.000,00* 2021-2311.47346.305.000,00
* di cui 4.971 misure con un valore di ~23.740.000,00 da fondi
valore complessivo di ~8.090.000,00 Euro.
A queste vanno aggiunte 4.971 misure per la rimozione di legname danneggiato con un valore compessivo di ~23.740.000,00 Euro, che sono state finanziate da fondi provinciali.
d) Programma di sviluppo rurale 2014-2020: misura 8.6 – Sostegno agli investimenti in tecnologie silvicole e nella trasformazione, mobilitazione e commercializzazione dei prodotti

delle foreste. Nel corso del 2023 sono state ammesse a finanziamento 180 domande di aiuto a proprietari boschivi e microimprese per l’acquisto di macchinari per l’esbosco. Il contributo ammesso a finanziamento di queste pratiche ammontaa ~1.114.000,00 euro(40% dell’importo ammesso).
Negli ultimi 6 anni (2018-2023) sono state accolte complessivamente 1.357 domande di contributi per l’acquisto di macchinari forestali e concessi contributi per 9.131.000,00 Euro.

2.2.3
Da più di 40 annilo stato di salute del bosco viene osservato e monitorato con cura dal Servizio forestale provinciale. In tale ambito si rilevano tutti i sintomi evidenti e i danni che compaiononei popolamenti forestali. Accanto a tali rilievi vengono condotte prove chimiche su campioni fogliari e di terreno per identificare eventuali inquinamenti dovuti a sostanze nocive Si è potuto verificare come la comparsa di molti danni boschivi trae la sua origine nell’andamento climatico sfavorevole; inverni poveri o molto ricchi di neve, gelatetardive, primavere troppo piovose, estati calde e siccitose o molto piovose, danni da vento e da grandine. Questi fenomeni mostrano spesso i loro effetti anche a distanza di anni, predisponendo le piante debilitate all’attacco da parte di alcuni patogeni, come il bostrico,
la ruggine vescicolosa dell’abete, la processionaria del pino e altriinsetti o funghi. Per questo motivo è utile un cenno preliminare sull’andamento climaticocomplessivo dell’anno.
Il meteo nel 2023, una panoramica
Il 2023 è da considerare uno degli anni più caldi dall’inizio dei rilievi termometrici (1850). La temperatura mediaannua a Bolzano è stata di 14,3 °C, ovvero 1,2 °C al di sopra della media di lungo periodo. La temperatura massima si è raggiuntaa Bolzano il 23 agosto (37,4 °C), la minima il 9 febbraio a Sesto Pusteria (-20,5 °C), laddove l’inverno in generale è stato tutt’altro che rigido L’inizio d’anno è stato relativamente asciutto, ma la primavera è stata costellata da frequenti e generose precipitazioni, che hanno portato la piovosità totale il 20-30% al di sopra della media di lungo periodo. Particolarmente salienti i dati della stazione meteo di Bressanone, che ha registrato 1.100 mm di precipitazione annua, il valore più alto dal 1878 e il doppio della piovosità del 2022. Questa elevata piovosità ha significative ricadute sulla dinamica di popolazione degliinsetti forestali.
Danni biotici
Bostrico tipografo (Ips typographus) La sua gradazione, intesa come incremento demografico esponenziale, ha
avuto inizio nel 2020, prima a carico di legname a terra, perlopiù schiantato dallaneve nel 2019, poi, a partire dal 2021, anche sulle piante in piedi. Il 2022 è stato un anno di particolare successo riproduttivo per il bostrico, che ha potuto contare su un’estate calda e siccitosa, condizioni climatiche che allo stesso tempo hanno posto l’abete rosso in una condizione di forte stress. In questo modo il bostrico ha potuto insediarsi in modo massiccio anche alle maggiori altitudini, che fino a quel momento erano state risparmiate.
Grazie alle generose precipitazioni e allenumerose fluttuazioni della temperatura, l’intensità dell’attacco è diminuita, questo grazie alle condizioni sfavorevoli all’attività riproduttiva del bostrico e all’accresciuta vitalitá della pianta ospite indotta dall’elevata disponibilitá d’acqua. La superficie bostricatatotale è del 20% inferiore a quella del 2022.
Particolarmente colpite la Val Badia e l’Alta Val Pusteria, dove la funzione protettiva dei boschi è localmente compromessa.
Grazie alle generose precipitazioni e allenumerose fluttuazioni della temperatura nel 2023, l’intensità dell’attacco è diminuita, questo grazie alle condizioni sfavorevoli all’attività riproduttiva del bostrico e all’accresciuta vitalitá della pianta ospite indotta dall’elevata disponibilitá d’acqua. La superficie bostricatatotale

è del 20% inferiore a quella del 2022 Particolarmente colpite la Val Badia e l’Alta Val Pusteria, dove la funzione protettiva dei boschi è localmente compromessa.
Per poter seguire bene la dinamica di popolazione di questo insetto si è realizzata all’indomani della tempesta “Vaia” una rete di monitoraggio composta di più di 100 trappole a feromoni, che vengono vuotate a intervalli regolari dal personale forestale. Questi dati di cattura ci danno preziose informazioni di natura scientifica e pratica.
In aggiunta, la Provinciaautonoma di Bolzano si giova da 2 anni di una convenzione conl’Universität für Bodenkultur di Vienna, che ha messo a disposizione il sistema “Phenips”, un sistema predittivo della fenologia del bostrico su tutta la provincia. Fino alla fine del 2023 in provincia sono stati esboscatiin totale 1,8 milioni metri cubi lordi di legname bostricato.
Altriinsetti corticicoli e lignicoli
Nei boschi a pino silvestree nei rimboschimenti a pinonero della V. Venosta sono stati segnalati coleotteri scolitidi dei generi Ips e Tomicus, che spesso attaccano parti diverse della stessa pianta; va poi citato Ips cem-
brae, coleottero scolitide specifico dellarice, che da qualche anno attacca i larici di bassa quota in Alta V. Venosta. Tali boschi sono da 2 anni oggetto di monitoraggio con trappole e feromoni ad hoc. Si cerca di frenare la pullulazione con abbattimenti mirati e, parallelamente, si lavora per una successione verso un bosco biologicamente più stabile.
Sempre sul larice si è trovato Tetropium gabrieli, un coleottero cerambicide che colonizza le parti più basse del tronco, spesso in combinazione con Ips cembrae; questo insetto è oggetto di un programma di monitoraggio da parte dell’Università di Padova attraverso il team del Prof Andrea Battisti e con l’appoggioinsostituibile dell’Ispettorato forestale di Silandro.
Singoli esempari di abete bianco sono stati attaccati in alta Val Venosta da Pissodes piceae, coleottero curculionide specifico di questa pianta; sulle piante attaccate è stato inoltre trovato Cryphalus piceae, piccolo coleottero scolitide,anch’esso specifico dell’abete bianco Con ogni probabilità l’attacco è da ricondursi alla situazione di stress indotto dalla siccità dell’estate 2022.
Processionaria del pino
La processionaria del pino (Thaumetopoea pityocampa) da noi attacca prevalentemente il pino silvestre e il pino nero; per questo motivo è molto diffusa nei rimboschimenti a
pino nero sul Sonnenberg in Val Venosta. Qui negli ultimi inverni, complice le temperature miti, ha avuto un crescente successo riproduttivo, con molte piante completamente defogliate Il pino è una pianta molto rustica edè in grado di emettere nuove foglie dopo l’attacco, ma ne esce indebolito e puó essere oggetto di attacchi di insetti o funghi secondari, questi ultimi letali. Inoltre le larve di questo lepidottero, a partire dalla seconda muta, sono provviste di peli urticanti cheesse sono in grado, quano minacciate, di liberare nell’aria. Questo può portare le note, fastidiose conseguenze su pelle e mucose di uomo e animali domestici. Per questi motivi la ripartizione Servizi Forestali, con autorizzazione ministeriale in deroga per trattamento aereo e con il supporto scientifico dell’Università di Padova, ha disposto il trattamento di tutti i 900 ha di bosco a pino nero con un prodotto biologico a base di Bacillus thuringiensis, batterio tossico per ingestione per la larva e assolutamente innocuo per i mammiferi Il trattamento è stato effettuato con un elicottero con apposita attrezzatura per la distribuzione del prodotto nel mese di settembre, momento propizio perchéle larve in quel periodo si nutrono in modo frenetico e sono più vulnerabili In questo modo la popolazione di processionaria si è ridotta in modo drastico, a vantaggio della vitalitá della pianta ospite e della funzione ricreativa di questo versante.

Altriinsetti non letali
Su una superficie totale di 59 ha è stata segnalata Coleophora laricella, un insetto minatore dellarice che dà luogo a episodiche pullulazioni. A questo attacco la pianta reagiscecon l’emissione di nuove foglie Nessuna segnalazione invece riguardo la tortrice grigia dellarice (Zeiraphera griseana), le cui gradazionihannoluogo con regolarità (ogni 8-9 anni) .
Su una superficie di più di 200 ha si è segnalato un lepidottero defogliatore del pino cembro, Ocnerostoma copiosellum; tale insetto puó predisporre la pianta adattacchi secondari, indebolendola. Tali gradazioni vengono generalmente riportate allalatenza da meccanismi di regolazione naturali. Occorre infine segnalare l’osservazione delle vistose coperture di seta sul pado (Prunus padus) nelle zone ripariali dell’Alta Val Venosta. Tali sete sono prodotte da Yponomeuta evonymellus, lepidottero defogliatore.
Danni abiotici
A livello provinciale sisono registrati modesti danni abiotici nel 2023, schianti da vento per un totale di 95,4 ha e schianti da neve per 312,2 ha.
I funghi sono parte integrante dell’ecosistema forestale dove svolgono numerose funzioni essenziali al benessere del bosco. Alcune specie fungine, tuttavia, sono anche i principali patogeni e provocano alcune delle malattie che colpiscono le piante. Nel 2023 sono state rilevate numerose infezioni legate a funghi patogeni fra le specie arboree forestali tipiche. Le segnalazioni di problemi patologici si sonolimitati a poche diagnosi. Limitatamente alle patologie fungine, comunque, nel corso del 2023 non ne sono state rilevate di nuove.
Funghi fogliari dellarice
Due patologie fogliari dellarice, entrambe note, sono state segnalate in Provincia nel corso dell’estate 2023. Hypodermellalaricis è stata osservata su alcune piante nel bosco intorno a 1800 m, in Val Venosta. Il fungo provoca il disseccamento dei ciuffetti di aghi su cui compaiono caratteristici isteroteci. Alla base degli stessi aghi èevidente un anello scuro, sintomo diagnostico. Il danno è apparso limitato e non esteso. Lo stesso fungo era

stato trovato sempre in Val Venosta anche agli inizi degli anni 2000: viene così confermata la sua presenza e persistenza nella valle Negli anni successivi è stato trovato molto sporadicamente in alcune localitàtrentine e sempre con attacchi limitati a poche o singole piante.
La presenza di Mycosphaerella laricina è stata segnalata in diverse località delle due province. Questo parassita fogliare è stato sicuramente favorito dalle abbondanti precipitazioni primaverili, che condizionano le infezioni primariein chioma La sua diffusione estiva è stata però limitata dalle minori condizioni di umidità di luglio ed
agosto, oltre che dalle altetemperature che hanno reso la superficie degli aghi meno favorevole alla germinazione dei conidi ed alla colonizzazione del parassita Gli attacchi registrati sono rimasti perciò abbastanza limitati e concentrati nelle zone piùumide, senza raggiungere l’estensione riscontrata in altri anni. Anche questo patogeno si conferma come presente praticamente in tutti i lariceti della Regione: il suo impatto appare però limitato e legato ad una defogliazione parziale o totale delle piante a fine estate
Dothistroma septosporum – Malattia delle bande rossesu pino cembro



(Pinus cembra) e pino mugo (Pinus mugo).
L'infezione legata alla malattia delle bande rosse provoca una grave perdita di aghi, in particolare di quelli più vecchi. Le specie di pino sono quelle maggiormente colpite da questa malattia. La caduta degli aghi inizia nei rami più bassi per poi diffondersi gradualmente verso la cima dell'albero. Nei casi più gravi, a rimanere sono solo gli aghi dell’anno.
I sintomi variano da singole macchie e/o le punte degli aghi marroni nei casi più lievi fino ad arrivare ad aghi completamente imbruniti nei casi più gravi. Al centro delle macchie e sui segmenti colpiti si formano corpi fruttiferi fungini neri all’interno dei quali si formano i conidi, spore derivate da riproduzione asessuata necessari alla moltiplicazionee diffusione del fungo. È proprio a causa di queste bande che la malattia prende il suo nome, quello di “malattia delle bande rosse”.
La presenza della malattiain Italia è nota dal 2017 In Alto Adige, invece, la presenza di questo patogeno è stata rilevata per la prima volta nel 2018 su alcuni individui di pino cembro e pino mugo della Val Sarentino; non è chiaro, tuttavia, quando il fungo sia effettivamente arrivato in provincia. Alcuni controlli effettuati nel 2022, seguiti dalle relative analisi di laboratorio svolte presso l’Università di Firenze, hanno accertato la presenza del patogeno in questione (Dothistroma septosporum) anche in altre valli altoatesine,e non solo. L’area principale di diffusione della malattia è nelle valli dolomitiche, soprattutto nella zona del Trentino Nelle aree fortemente infestate, comunque, la malattia delle bande rossesi è limitata alle specie di pino attaccate e non si ‘e diffusa sugli abeti e larici vicini.
L’effetto dell’attacco fungino sulla vitalità degli alberi è notevole. Infestazioni ripetute per diversi anni possono comportare un rischio estremamente elevato per gli alberi danneggiati, soprattutto se ancora nella fase giovanile Le contromisure sono tuttavia difficili da attuare soprattutto a causa dell'ampia diffusione della malattia. Ailanto (Ailanthus alitssima): L’ailanto è un albero deciduo invasivo originario della Cina e del Vietnam. Il così chiamato “Albero del paradiso”,

di
su
in rosso i siti positivi, in giallo quelli sospetti e molto probabili,in verde quelli apparentemente non infetti
utilizzato in passato come pianta ornamentale, è ormai molto diffuso anche in Alto Adige. Nella sua zona d’origine questa specie viene colpita da numerosi organismi patogeni; tuttavia,al di fuori del suo areale naturale didiffusione, nonha quasi nessun antagonista. Le misure introdotte per il contenimento dell’ailanto hanno avuto successosolo parzialmente Vent’anni fa in Europa e Nord America è stata osservata la morte di numerosi
individui di questa specie, riconducibile ad un’infezione da Verticillium Nell’estate del 2017 la stessa infezione, caratterizzata da avvizzimento delle foglie e disseccamento di rami, è stata riscontrata per la prima volta in Italia. Il fungo è stato identificato anche nel territorio della regione, sia a Covelano che a Rovereto L’anno successivo, nel 2018, la patologia fungina aveva raggiunto una diffusione tale da essere stata osservata in oltre 40 siti
sparsi per tutto il Trentino-Alto Adige Attualmente, con i nuovi focolai identificati nel 2023, sisono raggiunti i circa 190 punti di presenza accertata fra la provincia di Trento e quella di Bolzano. In generale, si è assistito sia all’allargamento dei vecchi focolai sia alla morte di numerose piante all’interno degli stessi.

Arrossamento chiome abete rosso
Anche alla fine dell’estate 2023, è stata osservata la sintomatologia già comparsa nello stesso periodo del 2022. In sostanza sisono visti arrossamenti diffusi nelle parti interne delle chiome di abete rosso: anche quest’anno i danni sono comparsi un po’ su tutto il territorio regionale, senza però raggiungere l’intensità del 2022. Su alcuni campioni sono state osservate fruttificazioni simili a quelle di Rhizosphaera kalkhoffii. Come causa principale dell’arrossamento si assume lo stress climatico.
Deperimento ontanonero
Si èeffettuato un tentativo di isolamentodi Phytophthora alni da campioni di ontano raccoltiin val Venosta. I tronchetti presentanti macchie scure sono stati prelevati a marzo e quindi tenuti in acqua per 24 ore. Si è proceduto all’isolamento piastrando tessuti infetti dalla corteccia, ma il risultato non è stato positivo Al momento, pertanto, non è ancora possibile confermare la presenza di p. alni come agente del deperimento. Occorreràriprovare nel prossimo anno, procedendo connuovi protocolli di isolamento.
Per l’analisi e l’identificazione delle patologie fungine la Ripartizione Foreste viene supportata dal prezioso lavoro del dott. Giorgio Maresi, ricercatore presso la Fondazione Edmund Mach di San Michele all’Adige
Non è superfluaa questo punto una visione d’insieme sull’incidenza dei danni boschivi 2023 a livello provinciale. Il risultato dell’elaborazione delle segnalazioni provenienti dalla capillare rete di stazioni forestali è sintetizzato nel diagramma che segue.
Incendi boschivi - Servizio di reperibilità forestale
Nel corso del 2023 si sono verificati 33 incendi boschivi e di sterpaglie per una superficie totale pari a 28,37 ha. Il tempestivo intervento delle squadre di vigili del fuoco e del personale forestale ha inoltreevitato l’estendersi del fuoco su più vaste superfici. In media la superficie persa per incendio (indice di efficienza dell’azione di spegnimento) risulta essere limitata a soli 0,87ha. Nel caso di incendi boschivi edeventi di pericolinaturali o di protezione civi-


le viene attivato il servizio di reperibilità forestale – attivo 24 ore su 24, che allerta i servizi forestali localmente competenti ed organizza l’eventuale intervento dell’elicottero per i lavori di spegnimento.(5 interventi con l’elicottero, 9 per esercitazioni).
Nel 2023 il servizio di reperibilità forestaleè stato allertato complessivamente 455 volte , di cui 355 volte per il recupero di animali selvatici feriti o morti - soprattutto coinvoltiinincidenti stradali.


I lavori in economia comprendono provvedimenti rivolti ad un generale miglioramento delle condizioni sostanziali dei nostri complessi boschivi
e rivolti a salvaguardia gli ecosistemi come rimboschimenti e cure selvicolturali, misure di ingegneristica ambientale per la stabilizzazione di erosioni e la deviazione controllata delle acque, sistemazioni antivalanga per la sicurezza delle infrastrutture, strade di allacciamento dei masi, costruzione di strade forestali ed alpicole, costruzione di sentieri, misure di tutela boschiva contro danni biotici ed abiotici, misure di prevenzione antincendio

boschivo, miglioramenti di pascolo e misure gestione/separazione pascolo-bosco, rivitalizzazione di boschi cedui e castagneti, miglioramenti e ripristino di particolari habitat boschivi, misure di pronto intervento in caso di eventi di pericoli naturali.
I progetti vengono elaborati dal servizio forestaleedeseguiti in gran parte dagli operai forestali. Anche la direzione lavori durante l’esecuzione

2.2.5
dei lavori viene svolta dai tecnici della Ripartizione Foreste. Il servizio forestale realizza i lavori con massima sensibilità ambientale e conl’uso di materiali naturali tipici, perraggiungere la massima integrazione delle opere nel paesaggio.
Gliinterventi si riferiscono ai lavori in economia dei distretti forestali, a quellinei vivai forestali, alle iniziative per l’impiegodei disoccupati, come da L.P. n.11/86, al rilevamento dei danni boschivi e all’elaborazione di piani di gestione dei beni silvo-pastorali. Poi-
ché trattasi in gran parte di attività manuali, presso i Servizi Forestali Provinciali è impiegatoogni anno un gran numero di operai.
L’ammontare finanziario complessivo dei 505 progetti di lavori in economia svolti nel 2023 da parte della ripartizione foresteera pari ad un importo totale di 15.150.200 euro Di questi 11.169.680 euro finanziati dall’amministrazione provincialee i rimanenti 3.980.520 euro da parte di terzi.
Inoltre, nell’anno 2023 sono stati realizzati progetti in parte per la sistemazione didanni da avversità atmosfe-
richee in parte per infrastrutture in zone rurali con una somma complessiva di 864.800 euro.
La maggior parte dei contributi pari a 648.700,00 euro è stata erogata per l'attuazione di misure di pronto intervento da parte della Pubblica Amministrazione. Gliinterventi da danni alluvionali sono stati sovvenzionati con 216.100,00 euro per la parte relativa ai privati.
«« Sono visualizzati lavori eseguiti in economia 2023 per tipologie di lavori realizzati e per ispettorati forestali a pag. 212 – 2013



Da settembre 2019 ed fino a gennaio 2023 non è stato possibile presentare nuovi progetti se non in casi urgenti o non differibili. Attualmente si lavora per la realizzazione dei progetti giá
precedentemente inoltrati. Negli ultimi anni 2020-2023 sono stati finanziati ben 543 progetti con una somma erogata di ~138.622.000 euro.


a) Viabilità rurale e collegamento dei masi
I masi montani altoatesini e la maggior parte delle malghe e dei boschi in provincia sono raggiungibili con una strada camionabile o una strada silvo-pastorale. Nella rete viaria rurale sono inserite tutte le strade aperte al pubblicoche portano a degliinsediamenti abitati per tutto l’anno. In comuni ruralila rete viaria agricola è molto estesa. Una buona e sicura accessibilità é una prerogativa per la futura gestione dei masi.
A titolo esplicativo il Comune di Castelrotto conta ben 156 strade che allacciano ben 211 masi, il Comune di Sarentino comprende una rete viaria che raggiunge 345 masi con una lunghezza complessiva di 200 chilometri.
Senza questa capillarerete viaria probabilmente anche in Alto Adige molti masi sarebbero stati abbandonati, con il conseguente ripercussione sul paesaggio e sull’attrattivitàturistica. La manutenzione, il miglioramento, la messa in sicurezza e il risanamento di spezzoni di rete viaria rovinati da eventi climatici distruttivi costituisce oggigiorno la maggior parte dell’attività costruttiva nelle strade rurali. La creazione di nuovi tratti riguarda, in prima linea nuovi tracciati per migliorare la viabilità già esistente.
La realizzazioneè garantita da enti pubblici e privati
In tutto l’Alto Adige i contadini di montagna di piccoli territori o di frazioni sisono aggregati ininteressenze o associazioni agrarie. Queste associazioni rappresentano i diversi borghi
montani o aggregazioni di masi e si preoccupano per la costruzionee il mantenimento delle infrastrutture necessarie. I vantaggi di queste organizzazioni sono evidenti: il diretto interessamento per i progetti con il conseguente coinvolgimento nelle decisioni con soluzioni pragmatiche. Un risvolto da non sottovalutare è lo sgravio delle amministrazioni comunali.
Tuttavia, negli ultimi anni sempre più interessenzee associazioni agrarie si ritirano Le motivazioni di questo fenomeno sono le restrizioni sempre più vincolanti per la realizzazione di progetti tecnici nonché la sproporzionata burocrazia.
Nell’anno 2023 sono sati finanziati 58 progetti, l’aumentare del contributo é stato di ~22.700.000 Euro.
L’incidenza tendenzialmente in aumento di fenomeni climatici estremi e l’aumento contestuale del traffico pesante si ripercuotano su una maggiore sollecitazione della rete viaria rurale.
b) Misure di sostegno per l’economia montana
Nell’anno 2023 i contributi versati per il miglioramento delle infrastrutture, come fondamenta per le attività produttive e per la salvaguardia del sostentamento degli agricoltori di montagna, sono distribuiti, come segue.
L'anno 2022 ha dimostrato che l'acqua sta diventando scarsa anche in montagna e quindi anche in Alto Adige. La scarsità d'acqua sta costringendo molti concessionari a progettare e realizzare progetti per garantire l'approvvigionamento di acqua potabile e antincendio. Da un lato la domanda è aumentata notevolmente in alcune aree, dall'altro molti sistemi di fornitura stanno invecchiando e devono essererinnovati.
Nell'ultimo anno sono stati presentati solo per le zone rurali 27 progetti per l'approvvigionamento di acqua potabile e antincendio nelle aree rurali, che in ragione dell'urgenza e dell'inderogabilità sono state finanziate (contributo complessivo: ~16.876.000 euro). Con la delibera n. 846 del 3 ottobre 2023, la giunta provinciale ha determinato le nuove linee guida per la concessione di contributi per i sistemi pubblici di approvvigionamento di acqua potabile in situazioni dissagiate.
c) Sussidi in casi di emergenza (L.P. del 21 ottobre 1996, Nr. 21, Art. 50)
La legge forestale prevede sussidi per iniziative dirette atte all’eliminazione didanni causati da avversità atmosferiche, alluvioni, valanghe e
smottamenti di terreni ad infrastrutture e per la prevenzione di danni forestale causati da infestazioni di insetti e funghi Nel corso dell’anno 2023 sono state concessi 89 sussidi d’emergenza con una somma totale di ~657.700 euro.


L´attuale situazione della fauna selvatica, e quindi la gestione della stessa, con il fine primario di tutelare e di migliorare la natura, ma anche l’agricoltura, la selvicoltura ed in generalele attività umane, rappresenta una continua sfida per l’autorità venatoria, per i cacciatori ed in generale per la comunità, poiché bisogna tener conto, oltre che degli equilibri ecologici e biologici, anche degli aspetti socioeconomici Da un lato, una parte molto preziosa dellanostra faunaalpina - in parte utilizzata per la caccia -, dall'altro, alcuni animali selvatici causano anche situazioni di conflitto, se le pretese di utilizzo dell'uomo sono limitate o gliinteressi di protezione dei gruppi di tutela degli animali sono prioritari
A causa della complessa normativa e degli opposti punti di vistaassumere decisioni che contemperino i diversi interessi e le diverse sensibilità è problematico, anche riguardo alla fauna selvatica cacciabile.
L’Ufficio caccia e pesca conduce censimentiin collaborazione con gli agenti venatori, con gli ispettorati forestali e con l’Associazione Cacciatori Alto Adige al fine di monitorare lo sviluppo delle popolazioni di fauna selvatica. Queste informazioni supportano la pianificazione degli abbattimenti e le misure di tutela e gestione delle specie di fauna selvatica.
Gestione della fauna selvatica protetta
La maggior parte delle specie di fauna selvatica, sia di mammiferi che dell’avifauna, è protetta e non cacciabile. Particolare attenzione viene riservata alle specie rare e minacciate, nonché a quelle che si trovano all’interno delle

aree protette: il parco nazionale dello Stelvio, i parchi naturali, i biotopi e le zone Natura 2000. La conservazione degli habitat viene comunque garantita anche al di fuori di queste zone attraverso le norme urbanistiche e ambientali.
Per alcune specie di fauna selvatica non cacciabile lo status della tutela non è di natura ecologica e gestionale, bensì stabilito giuridicamente. Molte specie a suo tempo minacciate se non estinte, come ad esempio alcuni rapaci diurni e notturni, sono oggi presenti con numerirassicuranti. Dopo la sua reintroduzione nelle Alpi, il gipeto (Gypaetus barbatus) nidifica con successo nella parte occidentale della provincia, mentre nel territorio provinciale vivono almeno 70 coppie di aquile reali (Aquila chrysaetos). Insieme alla Stazione Ornitologica Svizzera ed al Max-Planck-Institut è in atto uno studio su giovani aquilotti dotati di sensore GPS.
Il gufo reale (Bubo bubo) è presente soprattutto in Val d’Adigee nella bassa Val d’Isarco; spesso è minacciato dalle attività antropiche, per esempio nel caso di impatti conle lineeelettriche aeree. L’airone cenerino (Ardea cinerea) sispinge fino all’interno delle
valli alpine, mentre alcune colonie nidificanti sono stabilizzate nei fondivalle principali.
Risulta, di contro, problematica la situazione per quelle specie che necessitano di habitat particolari, in provincia quasi del tutto assenti: principalmente quelle che frequentano le zone umide.
Anche il gallo cedrone (Tetrao urogallus) diventa sempre più raro. Una recente rilevazione delle arene di canto storiche nei distretti occidentali, effettuata dalla Forestale coadiuvata dagli agenti venatori e dai cacciatori, ha dimostrato che diverse tra esse risultano abbandonate. Ciò avviene per cause diversee molteplici, di regola però di origine antropica.
I grandi predatori orso (Ursus arctos) e lupo (Canis lupus), invece, si dimostrano estremamente adattabili e riconquistano in continuazione nuovi spazi, generando spesso conflitti con le attività umane.
Degna di nota è la sempre più spesso confermata presenza dello sciacallo dorato (Canis aureus), migrato naturalmente in Alto Adige, dove si sta rapidamenteespandendo La faina (Martes foina) è molto diffusa nei pressi ed anche all’interno degli insediamenti urbani. Sempre più raramente viene segnalata la presenza
2.2.7
della martora (Martes martes). Il tasso (Meles meles) sista espandendo nelle aree di mezza montagna. Soprattutto nel Nord e nell’Est della provincia è stata riscontrata la presenza di puzzole (Mustela putorius) Nella Drava si è stabilizzata una piccola popolazione di lontra (Lutra lutra), specie endemica un tempo assai diffusa in Alto Adige. Nella parte orientale della provincia è comparso anche il più grande roditore europeo, il castoro (Castor fiber), proveniente dalla vicina Austria dove è ormai una specie stabile, mentre l’individuo avvistato in Alto Adigeè per ora l’unico sul territorio.
La presenza della faina nei centri urbani è frequentemente causa di conflitti con le attività umane. Con decreto è stato perciò prevista la possibilità di catturarla con trappole a cassetta in corrispondenza di edifici sia pubblici che privati, perragioni di sicurezza e per prevenire danni Gli animali vengono in tal caso catturati dagli organi di vigilanza venatoria per essere liberati lontano dagliinsediamenti urbani.
Sulla base di un parere dell’osservatorio faunistico provinciale, tramite decreti dell’Assessore competente, possono essere autorizzati prelievi di controllo di capi di specie non cacciabili o l’ampliamento del periodo di caccia per specie già cacciabili, se queste sisono espanse in modo tale da danneggiare l’equilibrio ecologico, le produzioni agricole e selvicolturali, la pesca,altri selvatici, ed infinenel caso in cui sussiste il rischio di pregiudicare la sicurezza o la salute delle popolazioni umane. Nell'anno di riferimento 2023, sono stati emessi decreti che hanno autorizzato il prolungamento del periodo venatorio per femmine e piccoli di cervo, per il controllonumerico di volpi e cormorani, per il trasferimento di marmotte e per l’abbattimento di cornacchie per mitigare danni eccessivi all'agricoltura.
A tutela della specie ittiche autoctone, in particolare il temolo (Thymallus thymallus) e la trota marmorata (Salmo marmoratus) sono stati prelevati 100 esemplari di cormorano (Phalacrocorax carbo) nell’ambito del piano di gestione, attivo tra novembre 2023 e marzo 2024, al fine di contenerne la presenza in costante crescita lungo i nostri sensibili corsi d’acqua alpini.



Confermato il letargo di un orso in Alto Adige
Il primo caso di svernamento nella nostra Provincia di un orso bruno (ursus arctos) è stato accertato nel 2002. Si trattava dell’orsa Vida, cheera stata rilasciata in Provincia di Trento nel mese di maggio 2001 nell’ambito del progetto Life Ursus. L’orsa aveva un carattere schivo e presentava un’elevata propensione allo spostamento che l’ha portata, dopo aver svernato nel 2002 nella zona di Bressanone, a dirigersi verso il Tirolo del Nord. Un secondo caso di svernamento dopo l’orsa Vida è stato accertato lo svernamentodi un orso in Provincia di Bolzanonel corsodell’inverno 2022/2023 Dai primi accertamenti sembra essere lo stesso plantigrado che ha svernato nella zona del Renon anche nel corso dell’inverno 2023/2024. I campioni di DNA raccolti nel corso del monitoraggio 2023, hanno confermato la presenza sulnostro territorio di tre orsi maschi, si tratta di M75 (4 anni), M84 (2 anni) e M107 (campionato per la prima volta).
Il primo accertamento di un plantigrado è avvenuto verso la fine di marzo all’alpe di Villandro, dove sono state rinvenute delle impronte sulla neve. Successivi indici della sua presenza sono stati notatitra i comuni di Barbiano e Renon, dove a seguitodelle analisi di un escremento è stato accertato che si trattava dell’orso M75. Di questo maschio, nato nel 2020 dai genitori F4 e M18, era già stataaccertata la presenza in Alto Adige nel corso del 2021. Sulla base dell’accertamento di ottobre 2022 e della prova genetica dell’aprile 2023, si può cautelativamente supporre che l’orso M75 abbia trascorso l’inverno 2022/2023 tra i territori di Sarentino e Renon. Altri accertamenti di M75 nell’anno 2023 sono avvenuti nel comune di Campo di Trens, Moso in Passiria nonchénelle zone di Flaggertal e Schalderertal. Le ultime impronte di M75 nel 2023 sono state avvistate nel comune di Renon, lungo una strada forestale, non distante dalluogo dove era stato ripreso nell’autunno del 2022 da una fototrappola Probabilmente nell’inverno 2023/2024, M75 ha svernato in questi luoghi.
L'orso M84, invece, è stato responsabile didiverse predazioni a carico apiari nella zona della Mendola fino a Marlengo. Questi eventi sisono veri-

ficati tra metà aprile e metà maggio. M84 è un giovane maschio nato nel 2022 (genitori: F7 e M18)
Ulteriori segnali della presenza dell’orso bruno, nel corso del 2023, sono stati accertati nei comuni di Appiano, e più precisamente nel bosco di Monticolo, a Tesimo, Senale-San Felice, Val d’Ultimo e Val Martello. Nel comune di Cortaccia, nella zona di Favogna, é stataaccertata mediante una prova genetica la presenza di un terzoorso, M107 il cui profilo genetico è stato rilevato per la prima volta. Il plantigrado, verso la meta di maggio aveva tentato di aprire, nella citata località una rotoballa.
A seguito dell´ attività dell’orso su apiari e bestiame, nel corso del 2023, la Provincia di Bolzano ha concesso
contributi per un valore complessivo di 8.731,00 €.
Il lupo continua ad espandersi Nel 2023, trentanove diversi genotipi di lupo (Canis lupus) sono stati geneticamente campionati in Alto Adige. Dieci di questi sono risultati ventiquattro maschi e quattordici femmine. L'analisi genetica di un altro animale non ha dato un risultato completo. Trenta animali provengono dalla popolazione italiana, nove animali dall’Europa Orientale. Dei trentanove lupi campionati, sei animali erano già stati confermati negli anni precedenti in provincia di Bolzano, a questi si aggiungono 6 animali dalla provincia di Trento. Per quanto riguarda il numero di lupi nel 2023, si può ipotizzare un numero mi-

nimo di oltre 78 individui in Alto Adige. Sulla base delle prove raccoltee dopo aver consultato le province limitrofe, sono stati confermati 7 branchi di lupi in Alto Adige. Tre di questi branchi hanno il loro territorio principalmente nella provincia di Bolzano. Gli altri quattro sono branchiinterprovinciali. Nel 2023, i danni causati dagli attacchi dei lupi al bestiame sono stati compensati con un importo di 99.209.- euro.
In autunno 2023, il presidente aveva ordinato il prelievo di un totale di quattro lupi sui monti sopra Fundres-Valle Aurina (9 settembre) e nel Comune di Castelbello (15 settembre) dopo un esame approfondito e la consultazione di esperti;il Tribunale Regionale di Giustizia amministrativa di Bolzano ha sospeso entrambe le autorizzazioni espresse decreto presidenziale e concluso con una decisione collegiale.
Management delle specie invasive di mammiferi
A livello europeo e nazionale è stata redatta una lista delle specie animali non autoctone invasive, che a causa dell’impatto negativo cheesercitano sugli ecosistemi locali devono essere tenute sotto controllo e se possibile del tutto eliminate. Nel Suddella provincia si trova con una certa frequenza

sarcoptica del camoscioin Alto Adige: casi documentati nel 2023 (rosso), casi documentati dal 2018 al 2022 (bianco), casosospettoso riscontrato sulla destra orografica dell'Adige (giallo)
la Nutria (Myocastor coypus). Nell’ultimo anno ci sono state anche singole prove di nittereute o cane procione (Nyctereutes procyonoides) e procione o meglio conosciuto come orsetto lavatore (Procyon lotor)
Management delle specie di fauna selvatica cacciabili
Il capriolo (Capreolus capreolus) rappresenta la specie numericamente prevalente di ungulato allo stato li-

bero, è presente su tutto il territorio provincialee viene cacciato in tutte le riserve di caccia. Il prelievo annuale si aggira intorno a 7.801 capi.
La diffusione del camoscio alpino (Rupicapra rupicapra) è condizionata dalla rogna sarcoptica, per cui varia da zona a zona; sista oltretutto espandendo sempre più in basso, raggiungendo i pendii ed i fondivalle anche delle Valli d’Adigee Isarco. La rogna sarcoptica provoca in alcune zone gravi perdite:

in tutta la provincia sono stati segnalati nel 2023 298 casi di rogna, un evidente incremento di 59% a confronto dei 187 casi dell’anno precedente, causando però gravi perdite in ambiti locali come nei monti di Fundres, la parte orientale delle Dolomiti, la val Badia, attorno al massiccio del Montone e della Cima del Vento Grande come anche lungo il dorso del Monte Regolo. Da un primissimo casosospettoso di rogna sarcoptica riscontrato sulla destra orografica dell'Adige, nella zona della Mendola, l'esame necroscopico non è riuscito a confermare la presenza del parassita sul cadavere del camoscio. L'areale di caccia nel 2023 è di 3.081 animali. La gestione professionale del camoscio richiede indagini sulla popolazione per consentire un prelievovenatorio conforme al mantenimento del buono stato di conservazione.
Anche il cervo (Cervus elaphus) è presente in tutto il territorio provinciale, con un aumento progressivo di consistenza sia nelle zone vocate che in quelle periferiche. Nei piani di abbattimento è stato sensibilmente
incrementato il numero di prelievi nelle riserve di caccia dell’alto Adige, per tenere anche conto dei danni arrecati alle foreste. Nelle riserve di caccia dell'Alto Adige non sono mai stati abbattuti tanti cervi quanti nel 2023, ovvero ci sono stati 4.829 abbattimenti. Un nuovo approccio della Commissione faunistica per calcolare i piani venatori, che stima prima la crescita dei cervi a livello delle unità di popolazionee assegna poi la quota di abattimento alle singole riserve di caccia,aveva la pretesa di elaborare piani fattibili per ogni riserva. Ciò ha permesso di raggiungere nel 2023 il 98% del piano d’abbattimento previsto, con differenze a livello delle riserve di caccia. Basato sul fatto che le popolazioni di selvaggina ungulata generalmente traggono vantaggio dai cambiamenti climatici, in alcune parti del paese si può prevedere un ulteriore aumento del cervo, nonostante alla conformità soddisfacente del piano di abbattimento. L'aumento della intensità e pressione venatoria sfocia sempre di più in una caccia più difficile. I cervi sistanno trasformando da ruminanti originariamente diurni e
da specie di selvaggina delle campagne (semi)aperte, in animali notturni e sono stati ricacciati nelle aree forestali soggette a conflitti Con l’aumento dell'uso ricreativo, i disturbi di ogni tipo e la pressione sull'habitat del cervo la situazione sistaaggravando sempre di più. A lungo termine, sarà necessaria una gestione integrale del cervo con strategiee concetti di caccia adattati al territorio, per tenere sotto controllo questa specie di selvaggina in un'area montana come l'Alto Adige.
Nelle zone con maggior presenza di cervi quali la Val Venosta bisogna prendere provvedimenti più concreti, in mododa preservare i boschi di protezione e l’equilibrio fra la fauna selvatica e l’agricoltura. Le recinzioni per le colture agrarie, anche solo per i prati, sono in continuo aumento benché questo non corrisponda all’ indirizzo colturale provinciale.
Dal 2012 viene condotto un rilievo sistematico degliincidenti stradali con ungulati. Nel 2023 sono stati registrati dagli agenti venatori di professione 981 incidenti con conseguenze mortali
2.2.7
per l’animale selvatico (793 caprioli, 112 cervi, 32 volpi, 37 tassi, 1 cinghiale e una marmotta), mentre nell’anno precedente erano 908. In molti dei tratti incidentati sono stati attivati dei progetti pilota in collaborazione con il servizio stradale, per testare l’efficacia delle misuredi prevenzione I distretti di caccia sono supportati dall'amministrazione provinciale nell'acquisto diriflettori di segnalazione della selvaggina per i tratti stradali particolarmente critici. Le misure per collegare gli habitat e ripristinare i corridoi faunistici interregionali possono includere anche la costruzione di ponti per la fauna selvatica.
Occasionalmente s’incontra il cinghiale (Sus scrofa), che qua e là si fa notare per i danni che provoca all’agricoltura. Con un totale di 5 capi (3 maschi di cui uno investito, una femmina giovane e un piccolo), sono stati uccisi meno cinghiali rispetto all'anno precedente (9 capi nel 2022)
Nella confinante Valle di Fassa è da tempo presente una popolazione di muflone (Ovis musimon), dalla quale questa specie alloctona di ungulato in diverse occasioni sconfinanella zona del Catinaccio e dalla quale, negli ultimi anni, sono stati prelevati alcuni individui. La specie di selvaggina allocto-

na èecologicamente problematica e compete con altri ruminanti selvatici. Nella zona da Appiano fino a Tesimo alla cresta della Mendola nel 2019 è inspiegabilmente nata una piccola popolazione di mufloni. La rimozione completa di questi animali di origine sconosciuta è stata effettuata immediatamente dagli organi di protezione della caccia dell'autorità forestale.
La lepre comune o europea (Lepus europaeus) trova un habitat ad essa confacente soprattutto fra gliimpianti frutticoli nei fondivalle ed è negli stessi diventata ovunque numerosa. Meno numerosa risulta nelle zone di montagna

Poco sisa della lepre bianca o variabile (Lepus timidus) ma dagli abbattimenti effettuati si presume il numero degli esemplari della specie essere costante. La specie arcto-alpina dovràaffrontare problemi con l'aumento delle temperaturee probabilmente risulterà perdente nei cambiamenti climatici, motivo per cui è necessario prestare particolare attenzione alle tendenze della popolazione.
IInnanzitutto, va ribadito che, con l’adeguamento del periodo di prelievo allalegge quadro statale avvenuto nel 2013, la popolazione di volpe (Vulpes vulpes) è cresciuta. Con decreto dell’Assessore competente è stato anticipato l’inizio della stagione di caccia alla volpe a partire dal 15 luglio 2022, per incrementarne il prelievo nel periodo in cui si verificano più numerose le predazioni di pollamee negli habitat dei tetraonidi. Del complessivo prelievovenatorio di 1.857 volpi ben 1.136 sono state abbattute durante il periodo aggiuntivo di apertura della caccia sancito col decreto predetto assessorile.
La norma di attuazione allo Statuto d’Autonomiaapprovata con D.lgs. 11 dicembre 2016, n. 240 ha consentito all’Amministrazione Provinciale per la prima volta di autorizzare il prelievo
venatorio di specie protette dalla Legge statale. Di questa eccezionale possibilità, unica in Italia, ha fatto uso l’Alto Adige a partire dal 2017 per quanto riguarda lo stambecco (Capra ibex) e la marmotta (Marmota marmota) Dopo aver ottenuto i pareri degli esperti e l'approvazione del Ministro dell'Ambiente e dell'Agricoltura, il Governatore ha emesso il decreto per il"Piano di gestione del cervo 2022-26" e il"Piano di gestione della marmotta 2022-26" nelluglio 2022.
La popolazione di stambecchiin Alto Adige, che nel frattempo è cresciuta ad oltre 2.000 esemplari, consente una caccia prudente Oltre alla caccia, il concetto di gestione prevede anche il prelievo o la cattura per la marcatura o la reintroduzione in piccole colonie di selvaggina di roccia in Alto Adige. L'obiettivo è raccogliere nuove conoscenze scientifiche su questa specie di selvaggina d'alta montagna per migliorare ulteriormente la gestione e contribuire alla ricerca su questa specie di bovidi
Nella primavera del 2023 sono state effettuate 22 catture. Di questi, 15 giovani femmine e maschi di stambecco sono stati catturati nella metapopolazione di Resia-Brennero e rilasciati a Pfunders (colonia di Eisbrugg), men-

tre 7 individui sono stati trasmessi per scopi scientifici nell'ambito del progetto Interreg Terra Raetica nel Weißkugel. Nella metapopolazione tra Resia e Brennero sono stati abbattuti un totale di 84 esemplari di stambecco Il nuovo concetto di gestione approvato per lo stambecco 2022-26 non esclude più il prelievovenatorio nella colonia di Sesvenna, cheè collegata alla popolazione dei vicini Grigioni, nella quale sono state prelevate 2023 un totale di 4 capi.
Molto diffusa nel territorio provinciale è la marmotta (Marmotta marmotta): la popolazione stimata è dell’ordine dei 57.000 individui. Con analogo modus operandi è stato predisposto per 86 riserve di caccia un piano di prelievo venatorio della marmotta, nel quale un terzo dei prelievi previsti erano da effettuarsi nelle zone dove la Forestale aveva certificato casi di danni da marmotta.
Complessivamente sono state prelevate 1.341 marmotte, di cui circa la metà in zone dove infrastrutture e/o prati falciabili erano stati danneggiati in modo consistente dagli scavi delle marmotte.
Alcuni galliformi e anatre possono essere oggetto di prelievo venatorio sostenibile. Per i tetraonidi e per la coturniceè prevista una valutazione

d’incidenza per prevenire qualsiasi rischio per lo stato di conservazione soddisfacente delle specie interessata.
Dal 2008 i galliformi vengono sistematicamente censiti. I censimenti annuali dei galli forcelli o fagiani di monte (Lyrurus tetrix), delle pernici bianche (Lagopus muta) e delle coturnici (Alectoris graeca) costituiscono il presupposto per i piani di abbattimento di tali specie e vengono eseguiti dalle stazioni forestali e dal personale esperto dell’Ufficio Caccia e Pesca. Al momento la popolazione di fagiani di monte ha una consistenza stabile con pocheeccezioni, quella delle pernici bianche tende a calare, mentre la coturniceè in regresso anche a causa di inverni passati particolarmente nevosi e di habitat non idonei, che si ricoprono senza gestione adeguata con vegetazione arbustiva, la quale rallenta il recupero della popolazione Per questa ragione nel 2023 solo ai comprensori all’internodel Gruppo
Presenza di galliformi a livello provinciale, piano d’abbattimento e prelievo:
Galliforme
Consistenza primaverile stimata
Prelievovenatorio autorizzato
Prelievovenatorio effettuato
Coturnice1.341 37 25
di Tessa, Ultimo-Maddalena e Alpi Retiche e Ötztal è stata data la possibilità di abbattere alcuni esemplari di coturnici, mentre nell’anno 2022 tale permesso non era stato concesso a nessuno su tutto il territorio della provincia. Ulteriori dettagli e sviluppi sono contenuti nelle relazioni sulla situazione dei volatili selvaticiin Alto Adige pubblicate annualmente in autunno dall'Ufficio Gestione Fauna selvatica.
Per il controllo delle malattie della fauna selvaticaannualmente numerose
carcasse di animali abbattuti o trovati morti vengono inviati all’istituto zooprofilattico per essere analizzati.
È stato intensificato il monitoraggio dell’echinococcosi alveolare, facendo analizzare cadaveri di volpe rinvenuti in tutto il territorio provinciale al fine di migliorare le conoscenze sulla diffusione di questo parassita.
In Val di Fleres gli stambecchi si ammalano di pedaina in misura sempre più consistente.

In Alto Adige l’attività venatoria è possibile in poco più di 623.200 ettari di territorio (84% della superficie provinciale), suddivisi in 145 riserve di caccia didiritto e 51 riserve private. Queste ultime si estendono per circa 14.000 ettari (2% della superficie provinciale).
Della superficie provinciale rimanente, 65.000 ettari sono oasi di protezione faunistica demaniale e 52.500 ettari (tra cui il Parco Nazionale dello Stelvio) bandite, in cui la caccia è proibita. I complessivi 2.963 ettari che rappresentano la superficie dei 226 biotopi protetti, che sono per lalegge venatoria oasi di protezione faunistica, sono ricompresi nelle rispettive riserve ovvero nella superficie della bandita in cui si trovano. Nei biotopi la caccia è assolutamente proibita, se di superficie inferiore ai 10 ettari; nei 56 biotopi con superficie maggiore di 10 ettari è invececonsentito il controllo degli ungulati e, per motivi sanitari, quello della volpe.
Nelle riserve didiritto la sorveglianza viene garantita dall'attività di 70 agenti venatori di professione, dipendenti delle singole riserve di caccia e dell'Associazione Cacciatori Alto Adige. Nelle riserve private invece il servizio di vigilanza è garantito soprattutto da agenti venatori volontari. Nel Parco Nazionale dello Stelvio, invece, la sorveglianza è garantita dagli appartenenti al Corpo Forestale provinciale. Nell’anno 2023 nelle riserve didiritto 6.067cacciatori erano detentori e detentrici di permessi annuali e d’ospite; di essi 416 erano donne.
La legge provinciale sulla caccia stabilisce che gli obiettivi della politica venatoria sonola conservazione della biodiversità e di un buono stato di salute nella fauna nonchéla protezioneed il miglioramento degli ambienti naturali mediante una gestione attiva della fauna selvatica. Il prelievo ecosostenibile degli ungulati e dei galliformi è determinato dai piani di abbattimento.
Dal dialogo“Feld-Wald-Wild” (=campo-bosco-fauna) tra l’Unione Agricoltori e Coltivatori diretti Sudtirolesi (=SBB), l’Associazione Cacciatori Alto Adigee le Ripartizioni Forestee Agricoltura escono periodicamente linee guida per contemperare gliinteressi legittimi
Danni da fauna selvatica
Uno dei principali compiti della caccia èevitare che si verifichino danni da fauna selvatica. Il risarcimento dei danni causati da fauna selvatica cacciabile vieneeffettuato, di norma, dalle riserve competenti per territorio.
A parziale copertura di danni causati da mammiferi non cacciabili, rapaci e lepri, sono previsti contributi da parte dell’amministrazione provinciale. Di rilevanza economica risultano essere i
danni al raccolto causati dal ghiro e i danni alle galline ovaiole da parte di volpee faina.
Per danni da orso, lupo e sciacallo dorato tempestivamente denunciati e confermati dall’autorità venatoria è previsto il risarcimento nella misura del 100% del danno subito.
È fondamentale che vengano poste in essere tutte le misure di prevenzione, in modo da prevenire situazioni conflittuali. Per questo l’amministrazione provinciale concede contributi per opere di prevenzione di danni, come recinzioni, griglie antiselvaggina nonché recinzioni elettriche Ciò principalmente a protezione dei frutteti e delle vigne dadanni da cervo e capriolo Nel 2023 alcune malghe hanno realizzato nuove opere di prevenzione contro danni causati da grandi carnivori.

Geograficamente, l'Alto Adige occupa una posizione climatica particolare a causa della sua posizione interna alpina sul bordo meridionale delle Alpi, che si riflette nella diversità dei suoi corpiidrici. La successione didiverse altitudini in un'area molto limitata ha permesso lo sviluppo di numerosi tipi diversi di corpiidrici, ognuno con la sua caratteristica flora e fauna.
Ogni specie ittica ha requisiti molto specifici per il suo habitat e le condizioni ambientali associate. Affinché una specieittica possastabilirsi permanentemente in un ecosistema acquatico, ivi devono essere garantiti le condizioni idonee a tutti gli stadi di vita di un pesce. Solo una ridotta frazione delle acque dell'Alto Adige hale caratteristiche per essere considerata un habitat ittico persistente.
Acque da pesca in Alto Adige
L'Alto Adige ha un sistema di corsi d'acqua di oltre 9.500 chilometri che si estende dai torrenti montani ai fiumi e fossi della vallata Di questi, solo circa 1.600 chilometri possono essere utilizzati per la pesca. Ciò corrisponde a una superficie d'acqua di circa 1200 ettari.
Anche le acque ferme sono distribuite a tutti i livelli altitudinali della provincia. In totale esistono circa 350 acque ferme, di cui solo il 20% utilizzabili per la pesca. I laghi naturali con una superficie complessiva di 520 ettari ne costituiscono la parte più piccola. La maggior parte delle acque ferme è composta dai invasi e laghi artificiali e costituiscono all’incirca 1200 ettari.
La maggior parte delle acque viene classificata come acque salmonicole. Si tratta di acque a scorrimento veloce e a bassa temperatura, nonché di laghi di alta montagna e di montagna tipici del paesaggio alpino Le acque ciprinicole, sono principalmente i laghi della bassa atesina, i fossi a lento scorrimento con un profilo a temperatura calda e i singoli stagni, invece, rappresentano solo il 6% delle aree acquatiche per pesci.




Non tutte le acque dell'Alto Adige sono soggette allalegge provinciale sulla pesca: lo sono le acque cheerano già registrate nella "vecchia" lista delle acque pubbliche, relativa all’anno 1943, e quelle collegate in modo diretto conle suddette. La legge provincia-
le sulla pesca non viene invece applicata in alcuni laghi montani e alpini, negli stagni senzaafflusso e deflusso o solo con afflusso, e nei laghetti realizzati artificialmente con opere di scavo.
Più del 90% delle acque da pesca è soggetto ad un diritto esclusivo di pesca.



Il diritto può essere posseduto da persone private o da associazioni private o pubbliche. In Alto Adige i diritti di pesca non sono collegate alla proprietà delle particelle fondiarie interessate e pertanto possono essere venduti liberamente a chiunque in qualsiasi momento. Il diritto di pesca sulle acque da pesca non gravate dadiritti privati appartiene alla Provincia Autonomia di Bolzano, che lo assegna in concessione alle associazioni di pesca locali.
Consistenza ittica
Nella primavera del 2023 sono stati effettuatiin tutta la provincia dall'Ufficio gestione fauna selvatica i rilievi per quantificare la densità degli avannotti nelle acque salmonicole. È stata confermata una moderata riproduzione naturale di trotee di temoli (58 individui/100m per entrambe le specie ittiche). In generalele acque correnti naturali non soggette ad eventi che


incidononegativamente su di esse, come l’innalzamento e l’abbassamento repentino dellivello, lo svaso dei bacini idroelettrici, la canalizzazione, la mancanza di habitat idoneo, la mancanza di materiale ghiaioso, gli uccelli ittiofagi e le inondazioni naturali, hanno popolazioni ittiche ben strutturate.
La trota marmorata (Salmomarmoratus) e il temolo (Thymallus thymallus) sono le specieittiche principali delle acque correnti più grandi situate nel bacino acquifero dell'Adige. Entrambe le specie denotano un’insufficiente strutturazione delle classi di età ed una biomassa molto bassa. So prattutto


nei corsi d'acqua principalila situazione diventa particolarmente acuta per effetto della complessa combinazione di numerosi fattori negativi Questo rende particolarmente difficile qualsiasi misura per proteggere e sostenere le specieittiche autoctone. Nel caso della trota marmorata, la situazione è ulteriormente aggravata dal fatto che le popolazioni sono fortemente ibridate conla trota fario e in molti casi solamente le analisi genetiche consentono didistinguere le due specie. Lo statodi qualità dei corpiidrici dell’Alto Adige viene tenuto costantemente sotto controllo, così come stabilito dalle normative europeeed italiane. In oltre 100 punti di campionamento distribuiti nelle maggiori acque correnti dell’Alto Adige vengono raccolti con continuità molteplici parametri biologici e chimici, inclusi quelli relativi alla fauna ittica tramite

campionamento con elettrostorditore effettuato dall’Ufficio caccia e pesca. Ciascun punto stabilito deve essere
sottoposto a campionamentoogni sei anni. Nel 2023 il popolamento ittico è stato monitorato in 26 acque diverse.
La gestione delle acque è curata da più di 100 acquicoltori. Tra i diritti di pesca si trovano ancora alcuni diritti di mensa risalenti al Medioevo, vale a dire diritti di pesca originariamente
limitati al fabbisogno di una famiglia. Le diverse associazioni di pesca ed i titolari didiritti esclusivi garantiscono la sorveglianza tramite guardiapesca volontari.
Nell’anno 2023 sono stateemesse 4042 permessi annuali e 13157 permessi giornalieri. In totale sono state registrate 23692 uscite di pesci, che corrispondono ad una biomassa di 9698 kg. Le specie preferite sono state la trota fario e la trota iridea, mentre il
coregone e la trota lacustre sono stati i più popolari sui laghi.
Obiettivi della pesca
L’obiettivo principale della pescaaltoatesina è la protezione, la conservazionee, dove possibile, il miglioramentodella qualità e della quantità delle acque da pesca come base per un esercizio sostenibile della pesca.
Un altro obiettivo importante è la protezione della trota marmorata, una specie di salmonide autoctona tipica dei grandi fiumi dell'Alto Adige. Nel rispetto delle disposizioni previste dal documento iniziale elaborato nell’anno 2016 che indica le misure di sostegno per la trota marmorata, la produzione di materiale di ripopolamento vieneeffettuata utilizzando un controllo totale della qualità genetica di tuttii pesci utilizzati.
È stato anche concordato che in futuro solole uova fecondatee i primi stadi giovanili della trota marmorata potranno essere usati per il ripopolamento delle acque da pesca. Come pesci madre saranno utilizzati quasi esclusivamente pesci selvatici catturati poco prima della stagione della deposizione autunnale delle uova e controllati geneticamente prima della spremitura, per essere liberate subito dopo nelle loro acque originarie. Eventuali pesci madre di allevamento devono appartenere alla prima generazione di pesci selvatici: ulteriori generazioni di pesci madre di allevamento non sono consentite La custodia dei pesci madre, la deposizionee la crescita degli avannotti avvengono in condizioninaturali o seminaturali.
Misure di sostegno della specie autoctona trota marmorata
Essendo la tutela e la promozione della trota marmorata uno dei punti di forza della politica alieutica in Alto Adige, dal 1994 sono statiindividuati dei cosiddetti “tratti da marmorata” per i quali sono state previste le semine di giovani marmorate allevate con il sostegno dei fondi finanziari provenienti dalle rendite da produzione idroelettrica delle acque altoatesine.
Dall’inverno 2017/2018 sono state effettuate in collaborazione con gli acquicoltori competenti catture di trote marmorateedè stato prodotto materiale di semina della stessa specie secondo degli standard di qualità
Catture 2023
Trota
Trota
Ibrido (T fario x T. marmorata)
Catture delle specie in funzione della rilevanza numerica e di biomassa.
predefiniti. Tale materiale di semina è stato assegnato a seguito di una valutazione comparata, su basi oggettive, delle diverse acque e tenendo conto dellelinee guida elaborate per la pesca, sia in forma di uova che di avannotti, alle acque-marmorata. Complessivamente, tenendo conto anche degli incubatoi privati di valle, negli ultimi anni sono stati allevate e seminate le seguenti quantità di trota marmorata: Per mezzo di queste articolate misure i popolamenti selvatici autoctoni di trota marmorata sono sostenutiin modo consistente, tale da grantirne la conservazione nellungo periodo.
Gamberi di fiume
Nell'ambito del progetto di conservazione delle specie "Gamberi di fiume
dell'Alto Adige", l'Ufficio gestione fauna selvatica coordina i rilevamenti a livello provinciale sulla distribuzione delle specie di gamberi di fiumee sullo stato del pericolo di estinzione del gambero di fiume (Austropotamobius pallipes), l'unica specie di gambero autoctona in Alto Adige. Lo stato di conservazione delle popolazioni autoctone del gambero di fiume deve essere classificato come critico con l'identificazione di solo sei luoghi con rilevamenti positivi in tutta la provincia nel periodo dal 2016 al 2023 Per garantire che questa specie di gamberi non corra il rischio di scomparire del tutto si è già iniziato, dopo apposite analisi genetiche, ad eseguire una protezione del patrimonio genetico di due areali Rio Angel e Rio Pozzo nell’area del


Centro Tutela Specie Acquatiche provinciale a Scena.
Oltre al gambero europeo (Astacus astacus), classificato come naturalizzato, si trovano sul territorio provinciale tre "specie invasive aliene d'importanza comunitaria europea": il gambero dal segnale, il gambero americano e il. Per queste specie sono state pianificatee attuate misure specifiche per controllare e contenere la loro diffusionee, dove possibile, per eradicarle Per esempio, come lotta biologica contro il gambero rosso della Louisiana è stata effettuata una semina di anguille giovani nellago di Caldaro e nella fossa di Caldaro. L’ effetto di questa misura si vedrà nei prossimi anni.
In altri posti la misura di prelievo di gamberi di fiume invasivi è stato effettuato anche nell’anno 2023 usando delle nasse Nello stesso periodo, individui di tutte le classi di età di gambero rosso della Louisiana, recentemente identificato, sono stati prelevati, dalle fosse della Bassa Atesina nel 2023, circa 80 esemplari. Infine, ai sensi del regolamento UE n. 1143, viene data grande importanza alle misure preventive. Queste comprendono la regolamentazione con restrizioni delle semine e dell’esercizio dell’attività alieutica facendo uso delle esche naturali, nonchéla sensibilizzazione della popolazione attraverso un programma articolato di pubbliche relazioni.
Esame di pesca 2023
Esame scritto e orale/pratico170 12674
Esami di caccia e di pesca, rilascio di attestati
L’esercizio della caccia e della pesca sono vincolati all’ottenimento di un documento di idoneità conseguente al superamento dei rispettivi, appositi esami organizzati dall’Ufficio caccia e pesca. Gli esami di caccia hanno avuto luogo regolarmente. Nel 2023 sono state emesse 273 nuove abilitazioni all’esercizio venatorio.
Decreti di nomina a guardia giurata particolare per il settore caccia e pesca 2023
Nuove assegnazioni Rinnovi Numero decreti 561
Da novembre 2021 gli esami di pesca sono organizzatiin da non avere più un’unica sessione d´esame, bensì in modo da avere più sessioniin un anno con un massimo di 57 candidati a sessione, che nell´anno 2023 sono state tre. Nel 2023 sono stateemesse 221 nuove licenze ministeriali per la pesca, mentre 5566 sono state rinnovate Inoltre, l’Ufficio competente per la pesca ha emesso 957 licenze per stranieri. Circa 12.500 persone sono in possesso di una licenza di pesca valida.
Sorveglianza e controllo
Siccome nell’anno 2021 è statoorganizzato un corso per le guardie di sorveglianza, nonne è statoorganizzato uno per l’anno 2023. I decreti di nomina a guardia giurata particolare per il settore caccia e pesca, di durata biennale, sono di competenza del direttore dell’Ufficio caccia e pesca. Nel corso del 2023 sono stati emessi 66 decreti.
Sostegni economici nel settore caccia e pesca a) Risarcimento danni da selvaggina e contributi per la prevenzione di danni
Gli articoli 37 e 38 della legge provinciale sulla caccia (nr.14 del 17/07/1987) prevedono risarcimenti per i danni da selvaggina, nonché l'erogazione di contribuiti per la prevenzione degli stessi. Riguardo alle misure di prevenzione contro i danni da animali selvatici (recinti, barriere e reti di protezione) sono state finanziate in tutto 150 richieste (19 recinti, 2 protezionilocali riutilizzabili per la protezione di singole piante, 42 opere di difesa per apiari, 22 opere di protezione delle greggi sulle malghe contro i grandi
Cambiamenato di coltura
Per cambio di coltura si intende la trasformazione di un bosco in altra qualità di coltura (p.es. prato, pascolo, vigneto…) o in superficie con altre destinazioni d´uso (es. pista da sci, parcheggio, zona per insediamenti produttivi…). Un cambiamento di cultura è un cambiamento definitivo e permanente dell’utilizzazione di un terreno boscato.
a) Landschaftsplanung: Nell’anno 2023 sono stati svolti in totale 148 procedimenti per trasformazioni di bosco in altra qualità di coltura; 146 procedimenti verde-verde (KGG)e 2
predatori e 65 opere di prevenzione contro i grandi predatori nei pressi dell’aziendaagricola con una spesa complessiva di 267.435,89 €.
Nel 2023 sono state corrisposte 191 richieste di indennizzo immediato per un ammontare complessivo di 142.441,62 €:
• 144 richieste con riferimento a danni provocati da grandi predatori. Sono statiindennizzati con complessivi 118.823,36 € 8 apiari, 385 pecore, 35 capre, 13 bovini e 8daini. I danni agli apiari sono stati provocati dall’orso. Circa il 94% dei danni hanno riguardano predazioni di pecore e capre da parte dellupo.
• 42 richieste con riferimento a danni provocati da piccoli predatori come volpi o faine. Sono statiindennizzati 1.226 polli e 6 maialini, con un costo complessivo 12.784,00 €.
• 5 richieste con riferimento a danni alle culture. Sono statiindennizzati, con complessivi 10.834,26€ per danni da morso causati da ghiri.
b) Contributi per la conservazione del patrimonio faunistico ed ittico
Per la conservazionee la tutela del patrimonio faunistico ed ittico e per sostenere le corrispondenti misure in-
trapresesono previsti sussidi sia dalla legge provinciale sulla pesca che dalla legge provinciale sulla caccia. Nel 2023 sono stati erogati contributi all’Associazione Cacciatori Alto Adige ed alle Riserve per interventi di gestione faunistica, compresa la costruzione di celle frigo, per complessivi 854.110,00 €, a centri di recupero per l’avifauna autoctona per 35.840 €, all’Unione Pesca Alto Adigee ad alcuni acquicoltori per la conservazione ed il miglioramento dei popolamentiittici per 42.923,10 €.
Sanzioninel settore della caccia e pesca
L'Ufficio gestione fauna selvatica svolge il procedimento amministrativo per l'imposizione di sanzioni amministrative in relazione alla vigilanza e al controllo da parte del Corpo forestale, dei guardiacaccia e dei guardiapesca. Nel corso del 2023 sono stati trattati in totale 252 procedimenti per sanzioni amministrative Di questi, 40 procedimenti amministrativi riguardavano la pesca e 212 la caccia.
procedimenti per cambiamenti del piano paessaggistico (KRL).
b) Piano urbanistico: ulteriori trasformazioni di bosco in altre qualità di coltura sono state svoltetramite cambiamenti di piani urbanistici per una superficie totale di 54.273 m² (Pianificazione comunale+Pianificazione provinciale).
Commissione tecnica
Nella commissione tecnica secondo l’art. 2 della L.P. 23/1993 sono stati valutati nel 2023 complessivamente 215 progetti - progetti della Ripartizione Opere idrauliche, della Ripartizione Foreste, dell’Agenzia per l’ambiente, della Ripartizione Agricoltura e della Ripartizione Protezione civile e antincendi Inoltre è stato approva-
to un Listino Prezzi per l’anno 2023 della Ripartizione Opere idrauliche e delle Ripartizioni Foreste, Agricoltura e dell’Agenzia per l’ambiente e sono state approvate 5 graduatorie per le misure forestali del PSR.
Autorizzazioni per movimenti di terra, interventi non sostanziali, pareri per la conferenza dei servizi ambientale e per la valutazione di impatto ambientale
Nel 2023 gliispettorati forestali hanno fornito 257 pareririguardanti la stabilità idrogeologico- forestalee l’ufficio gestione fauna selvatica ha fornito 104 pareririguardanti la regolamentazione sulle acque da pesca/pesca per la valutazione di progetti a livello di 21 conferenze dei servizi - settore ambiente e per 5 valutazioni di impatto ambientale. Inoltre gliispettorati forestali hanno rilasciato 1622 autorizzazioni per movimenti di terra e 159 parerei per interventi non sostanziali.

Permessi speciali per la raccolta di funghi
Il direttore di ripartizione, su delega dell'assessore provinciale alle foreste, può rilasciare permessi di raccolta di funghi per scopi scientifici o didattici, validi per zone determinate o anche per tutto il territorio provinciale,esclusii fondi espressamente interdetti dai rispettivi proprietari. Nel 2023 sono stati rilasciati 39 permessi di questo tipo.
Rientra nei compitiistituzionali del servizio forestale anche la sorveglianza ed il controllo sull’osservanza
dell’ordinamento forestalee delle leggi provinciali sulla caccia rispettivamente pesca. Oltre a ciò, negli ultimi decenni è stato demandato all’autorità forestale anche il controllo di ulteriori leggi a tutela dell'ambiente e del paesaggio; gli accertamenti eseguiti da parte del personale del Corpo forestale provinciale vengono poi elaborati dai rispettivi ufficicompetenti nelle ripartizioni provinciali 28, 29 e 35. Il Corpo forestale provincialeesegue vigilanza e controllo nei seguenti settori:
Accertamenti infrazioni ordinamento forestale rilevate
Accertamenti infrazionilegge sui funghi rilevati
Accertamenti infrazionilegge sui divieti di transito rilevati
Accertamenti infrazioni dellalegge sulla protezione di natura e paesaggio rilevati
Accertamenti infrazionileggi ambientali rilevati
Accertamenti
* 2 Servizi: • Servizio GG dell’Autonomia a Bolzano – 05.09.2023 / 15 personale CFP (1 gg) • Servizio vigilanza seggi elezioni Provinciali 2023 / 40 personale CFP (2 gg)
Autorizzazioni al transito su strade chiuse al traffico Il direttore di ripartizione, su delega dell'assessore provinciale alle foreste, può autorizzare il transito con veicoli a motore, per motivi di studio o di altra natura e che abbiano manifesto carattere di pubblico interesse, sulle strade chiuse al traffico. Nel 2023 sono state rilasciate 362 autorizzazioni di questo tipo.
• Diritti d’ uso civico (LP 16/1980)
• Tutela del paesaggio (LP 9/2018)
• Tutela della natura (flora, fauna, habitat, minerali; LP 6/2010)
• Traffico con mezzi aeromobili motorizzati (LP 15/1097)
• Gestione rifiuti e protezione del suolo (LP 4/2006)
• Protezione delle acque (LP 8/2002)
• Combustione di materiale biologico (LP 8/2000)
• Protezione dei corsi d’ acqua (LP 35/1975)
Statistica delle Notizie di Reato ad opera del CFP
Il Corpo forestale della Provincia Autonoma di Bolzano – Alto Adige (CFP), attraverso l’attività operativa svolta dalle proprie strutture distribuite in modo
notizie di reato - quantità
Attività di P.G.
contro noti
NdR contro ignoti
NdR Giudice di Pace
capillare su tutta la provincia, persegue lo scopo di preveniree reprimere, oltre le violazioni amministrative anche i reati commessi a danno del patrimonio forestale, faunistico, paesaggistico e ambientale del territorio provinciale.
NdR per FNCR (per fatto non costituente reato)
NdR su Denuncia
NdR su incarico Procura BZ (per reati non accertati dal CFP ma ad esso delegati)
totale notizie di reato8274
Atti successivi trasmessi, anno corrente e precedenti: (direttive indagine, sequestri, perquisizioni, rilievi tecnici, sopralluoghi,interrogatori, acquisizione atti, elezione domicilio/difensore, verbali, notifiche atti di PG, ecc.)
notizie di reato – per tipologia
Tipologia di reato
Reati vari settore caccia, pesca, CITES, armi, furto venatorio, ecc.
L. 157/1992 (caccia) – L. 150/1992 (cites) e altre normative specifiche
Abuso edilizio e paesaggistico, monumenti naturali, ecc.
D.lgs 42/2004 – DPR 380/2001 – C.P. art. 734 – e altre normative specifiche
Delitti colposi contro la salute pubblica (inquinamenti / ambiente)
C.P. art. 452/bis


Reati vari settore tutela ambientale (suolo, acqua e aria) D.Lgs 186/2012 – D.Lgs 152/2006
Incendio boschivo colposo
C.P. art. 423-bis (inclusi i casi con danno art. 635
Pascolo abusivo C.P. art. 636- -
Truffa ai danni dello Stato e della Pubblica amministrazione
C.P. art. 316-ter – art. 640 – altri artt. C.P. specifici
Stupefacenti (Cannabis / Hashish, ecc.) DPR 309/1990
Furto (di legname, materiale da cantiere, ecc.) C.P. artt. 626 e 6242 1
Maltrattamento di animali C.P. art. 544-ter1 -
Altri reati vari (tra cui danneggiamento, lesioni colpose, abuso d’ufficio,omissione d’ufficio, ecc.)
Reatiin correlazione con i controlli di contenimento COVID-19
C.P. artt. 650, 483, 495 e 651
Inosservanza dei provvedimenti dell’Autorità (in campo urbanistico) C.P. art. 6501 -
Delitti dei privati contro la Pubblica amministrazione violenza, minaccia, resistenza a P.U., rifiuto generalità, ecc.; C.P. artt. 336, 337 e 651
Controlli 2023in riferimento a premi agroambientali
Durante l’estate e in settembre - dicembre 2023 sono stati eseguiti il 3 % die controlli sui pagamenti agro-
Nell’anno passato 2023 sono state indette 82 sessioni forestali pubbliche ossia giornate d’ informazione forestali; quest’ ultime di regola si eseguono una voltaall’ anno in ciascun comune Nella sessione forestale vengono presentate lenovità del settore, vengono concordati obiettivi e programmi annualiin collaborazione con altre amministrazioni e si rilasciano diverse autorizzazioni.
Nel 2023 sono state organizzate a livello provinciale le feste dell’albero con 9.044 bambini delle scuole elementari, 79 escursioni e seminari tematici, 1 Presenza organizzata in fiera, 205 relazioni e manifestazioni d’ informazione, 50 articoli sono stati pubblicati 68 praticanti e laureandi sono stati assistiti.
ambientali 2023 dal corpo forestale provinciale in collaborazione con l’organismo pagatore. Questi controlli riguardano il rispetto degliimpegni delle varie misure ed il rispetto della
buona pratica (Cross Compliance) ossia il controllo delle superfici, registrazione degli animali ed il premio aziendale. In totale sono state ispezionate 424 aziende agricole.

2.2.14
Attività di formazione e di aggiornamento
Corso di formazione per 25 nuovi agenti forestali 21 allievi e 4 allieve agenti forestali hanno frequentato un corso di formazione della durata di sei mesi nella scuola forestale Latemar presso Carezza, che è iniziato nel mese di novembre 2022. I nuovi agenti forestali hanno concluso

laloro vasta formazione di base nel mese di aprile 2023 con l’esame finale e successivamente hanno preso ser-
vizio presso varie stazioni forestali. Inoltre, hanno frequentato una serie di moduli di approfondimento: moduli
interdisciplinari di pratica professionale, nonché un seminario didue giorni sulla comunicazione. Corso di formazionee moduli di approfondimento sono stati organizzati dal servizio forestale.
Per il personale dei vari ispettorati forestali è statoorganizzato un corso per l’applicazione QGIS per il rilievo e l’elaborazione didati geografici; le competenze acquisite sono state utilizzate in particolare per i rilievi delle superfici forestali colpite dal bostrico.
Nel 2023 dai vivai forestali provinciali sono state distribuite in totale 447.097 piantine a proprietari boschivi privati, enti pubblici e per i cantieri forestaliin amministrazione diretta:
394.241 piante a radice nudada rimboschiment, di cui
344410 aghifoglie per rimboschimenti
49831 latifoglie a radice nuda perrimboschimenti
27.590 piantine in fitocella per le feste degli alberi e da rimboschimento
5000 Piantine per la produzione di alberi di natale
14.221 latifoglie per la formazione di siepiin agricoltura
4901 piante ornamentali in vaso per enti pubblici 1.144castagniinnestati
447.097 totale piantine
C'erano un totale di 66 specie di piante diverse tra cui scegliere. A causa del lungo periodo di siccità e del risparmio acqua nell’irrigazione nell‘estate 2022, è stata rilevata una perdita significativa di piantine di larice; questi effetti saranno particolarmen-


te evidenti nella distribuzione delle piantine nel 2024.
Ancora buona è la richiesta di larice e pino cembro per lavori di rimboschimento e d interventi in alta quota. In agricoltura la necessità di arbusti per le siepi è rimasta più o meno costante. Le richieste di latifoglie come faggi e tigli superavano ampiamente la disponbilità.
Altraattività dell 2023
6.600
100.985
Piante messe in vaso grande per produzione piante ornamentali
Piante messe in vaso piccolo per produzione piante per le feste degli alberi e da rimboschimento
329.700Piante trapiantate
Il 2023 è stato un anno in parte debole per i semi; Sono stati raccolti complessivamente 795 kg di semi.







2.2.16
Arboricoltura e silvicoltura: cattedra convenzionataalla Libera Università di Bolzano È sorta una cattedra convenzionata nel campo delle scienzee delle tecnologie della arboricoltura e della silvicoltura. La Giunta provinciale ha approvato il 17 maggio 2022 l’istituzione di questa cattedra convenzionata nel campo delle scienze e delle tecnologie della arboricoltura e della silvicoltura per il periodo compreso tra il 2022 e il 2025 Per la creazione della cattedra la Provincia stanzierà 130.000 euro per ognuno degli anni accademici 2022/2023, 2023/2024 e 2024/2025. Le ricerche delle due istituzioni Il interes-
sano soprattutu il valore ecologico del bosco quale importante elemento per il contenimento dei cambiamenti climatici ed il ruolo delle foreste in relazione all’assorbimento dell’anidride carbonica ed ai servizi ecosistemici in relazione ai cambiamenti climatici. Un ruolo particolare in questa cooperazione alla ricerca è svolto dalla stazione di misurazione di Selva Verde, sull’altipiano di Renon, già gestita dalla Ripartizione Foreste della Provincia. Qui vengonoosservati lo scambio energetico tra il bosco e l’atmosfera e quello di vapore acqueo e anidride carbonica tra ecosistema e l’atmosfera stessa La stazione di monitoraggio situataadalta quota fa parte di diverse reti europeeed è una delle tre più importanti accreditate dall’IOS (Integrated Carbon Observation System) in Italia ed un elemento chiave per lo studio del ciclo del carbonio a livello regionale.
«« Vedasi cap. 2.6 La Facoltà di Scienze agrarie, ambientali e alimentari, Libera Università di Bolzano, pag. 152 segg.
Il sito ICOS di Renon
La stazione di Renon-Selva Verde è stata fondata nel 1996 Da questo anno vengono misurati i flussi di biossido di carbonio, il vapore acqueo e la energia tra atmosfera ed ecosistema forestale; in pratica “il respiro del bosco”. Il sito Renon-Selva Verde (ITRen) a partire dal 2021 fa parte dell'infrastruttura europea ICOS come sito di Classe 2. Il sistema integrato di osservazione del carbonio ICOS sta osservando i tre principali tipi di ecosistemi esistenti: terrestre, marino e atmosferico. Si basasu 61 siti di osservazione a lungo termine in 17 paesi europei, anche al di fuori dell'UE. Ulteriori siti associati e osservazioni di navi marittime compongono la rete.
Le misurazioni vengono eseguite seguendo protocolli rigorosi ed un programma serrato di calibrazione degli strumenti. Negli ecosistemi terrestri, come il bosco del Renon,le misure comprendono la quantificazione dello scambio di anidride carbonica e vapore acqueo tra vegetazionee atmosfera mediante la tecnica dell'eddy covariance. Inoltre, le osservazioni meteorologiche sopra edentro la vegetazione servono a comprendere le funzioni di questa foresta subalpina. I dati vengono inviati quotidianamente al database centrale ospitato a Lund, in Svezia, dovevengono elaborati per fornire informazioni giornalieree annuali.
I dati elaborati vengono poi organizzati in un database globale, FluxNet. A questo database convergono tutte le reti regionali, come l’asiatica Asiaflux (https://www.asiaflux.net) e l’americana NEON (https://www.neonscience.org) per comprendere meglio la risposta globale degli ecosistemi naturale al clima che cambia.
A Renon è stato misurato lo scambio netto di anidride carbonica,“il respiro del bosco “ per oltre 25 anni. Nel grafico, i valori negativi indicano l’assorbimento di anidride carbonica dovuti alla fotosintesi, che avviene per 8-10 mesi l’anno ed inizia prima dello scioglimento della neve in primavera. I valori positivi sono dovuti alla respirazione delle piante e di tutti gli organismi del bosco:
Neofite
Le specie vegetali non autoctone, introdotte dall’uomo in un datoterritorio dopo la scoperta dell’America, vengono definite “neofite”.
Di tutte le neofite, solamente una parte riesce a sopravvivere nei nuovi ambienti e a riprodursi. Un numero ancora più esiguo di specieinfine, si trova talmente benenei nuovi habitat, dadiffondersi rapidamentee diventare invasiva. Le specie invasive dimostrano una grandissima capacità concorrenzialenei confronti delle specie autoctone, arrivando a soppiantarle in molti ambienti Oltre a produrre un impoverimento nella biodiversità tipica di un luogo, alcune specie invasive possono avereeffetti negativi sulla salute di uomini ed animali.

Mappa dei siti di osservazione ICOS Giallo: siti ecosistemici; rosso siti atmosferici; blu siti oceanici.
Tra le specie maggiormente problematiche attualmente diffuse in provincia, si annoverano il panace di
Mantegazza, il senecione sudafricano, il poligono del Giappone, la balsamina

Links: https://www.icos-cp.eue https://fluxnet.org


dell’Himalaya, la verga d’oro del Canada, oltre alla robinia e all’ailanto.
La Ripartizione Foreste ha avviato nel 2012 due progetti per il contenimento del panace di Mantegazza e del senecione sudafricano Mentre la prima specie può provocare pericolose ustioni cutanee, la seconda risulta altamente tossica per gli animali al pascolo e per le api. Anche altri neofiti invasivivengono combattuti dal servizio forestale su alcune aree protette.
Tutti i focolai noti di panace vengono costantemente monitorati ed annualmente trattati Questi provvedimenti hanno permesso di limitare fortemente l’ulterioreespansione della specie a livello provinciale. Anche nel 2023, in un’area di saggio della Val d’Ega sono state testate diverse tipologie
di interventi meccanici (sradicazione, ritaglio, escavazione, rimozione delle infiorescenze,ecc.).
Secondo i risultati precedenti, la misura più efficace era la potatura meccanica anticipata delle giovani piante in primavera.
Il senecione sudafricano è stato controllato con successo da diversi interventi di sradicazione manuale nelle due zone di maggiore diffusione: Castelfeder e val Venosta. Anche nel 2023 sono stati organizzati diversi interventi di sradicazione a livello provinciale, soprattutto all'interno della Ripartizione Foreste.
La presenza del poligono del Giappone è stata sempre più osservata nel 2023. Nel territorio di Vipiteno, Bressanone e Merano sono state sperimentate misure di contenimento di piccole

aree con poligongo del Giappone definibili localmente.
Per quanto concerne l’ailanto sono stateeseguite prove di contenimento della speciein diverse aree test nei boschi cedui della Bassa Atesina. Queste prove hanno portato alla pubblicazione di una prima tesi di laurea nel 2019 (Masterarbeit_Tratter_Lukas(2). pdf (provincia.bz.it). Una seconda tesi, prosecuzione della prima è stata completata nel 2021 (Masterarbeit_ Goetterbaum_Frenes(1).pdf (provincia.bz.it) Qui possono essere letti i risultati delle tesi.
Rilevamento degli ostacoli al volo
Secondo la Legge Provinciale 1/06 gli ostacoli alla navigazione aerea esistenti, quelli di nuova costruzione,

nonché quelli smantellati devono essere comunicati dai gestori alla Ripartizione provinciale Foreste.
Tali comunicazioni serviranno per creare una carta digitale aggiornata quotidianamente di tutti gli ostacoli presenti in Alto Adige.
La carta forniràai piloti dei velivoli tutte le informazioni necessarie per evitare tali ostacoli e con ciò contribuire sensibilmente adaumentare la sicurezzaaerea.
Nel 2023 sono stati comunicati attraverso le stazioni forestali e l’Ufficio Pianificazione forestale 1.502 nuove lineee 1.434 smantellamenti. Questo grande numero di nuove comunicazioni e smantellamenti è da ricondurre all’esbosco delle aree danneggiate dagli schianti da neve nell’autunno/inverno 2019 e 2020 e dellegname danneggiato dal bostrico negli anni successivi. Quindi si tratta prevalentemente di comunicazioni di teleferiche temporanee per il trasporto di legname.
Attualmente (situazione al 31.01.2024) la carta digitale degli ostacoli al volo contiene 3.998 ostacolilineari e 1.005 ostacoli verticali.
In generale nel corso degli anni proseguono a diminuire gliimpianti fissi utilizzati nell’agricoltura (piccole teleferiche, fili a sbalzo).
In generale sono in declino gliimpianti fissi utilizzati nell’agricoltura (piccole teleferiche, fili a sbalzo).
Gli ostacoli al volo finorarilevati ed aggiornati quotidianamente dall’Ufficio Pianificazione forestale, sono pubblicati sul Geobrowser Maps della Provincia e possono essere visualizzati in qualsiasi momento.
Attualmente 74 persone ossia gruppi di persone hanno richiesto il servizio download degli ostacoli al volo. «« Ulterioriinformazioni relative a questo progetto e l’accesso al Geobrowser Maps si possono trovare al seguente indirizzo: http://www.provincia.bz.it/foreste/studi-progetti/rilevamento-ostacoli.asp
Progetto strade L’interesse per dati affidabili, riguardanti le strade forestali e poderali, è elevato. La conoscenza esatta della viabilità svolge un ruolo importante per i diversi enti pubblici, per la centrale provinciale d’emergenza, i comuni, i corpi dei vigili del fuoco volontari e permanenti e per diverse aziende private. Le strade poderali e forestali rappresentano la vera struttura portante del catasto stradale in forma digitale
Il servizio forestale aggiorna e gestisce attualmente 16.283 km di strade (strade forestali e poderali). Il numero dei singoli tratti ammontaa 25.653.

per il trasporto esclusivo di cose*
ranea
(acquedotti, ecc.) 7273747579 848388 9497
telefoniche 00000000000 222
* Dal 2020 in poi gli ostacoli al volo rilevati come “teleferiche per il trasporto esclusive di cose” sono stati suddivisi tra teleferiche piccole (carico < 1.000 kg) e teleferiche grandi (carico > 1.000 kg).
La classificazione delle strade chiuse al traffico ai sensi della L.P.n.10/90 è proseguita per dare in quest’ambito una migliore visione d’insieme e in modo che fosse possibile uniformare la cartografia.
La verifica linearee la correzione dei parametri descritti è stata attualizzata per tutte le strade poderali della provincia. Attualmente sono cartografati 3.994 km di strade poderali corrispondenti a 7.945 singoli tratti, di cui 3.717 km camionabili e 277 km trattorabili e 12.289 km di strade forestali corrispondenti a 17.708 singoli tratti, di cui 5.807 km camionabili e 6.482 km trattorabili.
Inoltre, a partire dal 2018, sono stati digitalizzati e descritti 21.105 km percorsi escursionistici e 7.820 km percorsi per montain bike. Ciò include la raccolta dei dati, emissione dei dati e il miglioramento continuo dei dati, sia graficamente che correzioni nella banca dati.
Monitoraggio degli spostamenti superficiali del versante di frana di Corvara in Badia e Trafoi
Frana di Corvara
Dal 2001 l’Ufficio Pianificazione Forestaleeffettua misurazioni GPS per monitorare la frana di Corvara che si trovaa sud-est del paese omonimo edè compreso nell’area delimitata da: Corvara - Strada Statale Campolongo fino al campo da golf – rifugio Pralongià – rifugio Bioch - Ciablun – rifugio Piz Arlara. La superficie è di circa 300 ha.
Dei 52 punti di misurazione che furono fissati all’inizio del progetto, oggi ne sono rimasti 33, 11 dei quali sono stati dati in uso al centro di ricerca Eurac Research per lo svolgimento didiversi studi.
I 22 punti restanti vengono misurati dall’Ufficio Pianificazione Forestale una voltaall’anno.
Nell’anno 2023 la misurazioneè stata effettuata nel mese di agosto. I dati ottenuti dai rilievi di campo sono molto differenziati. Alcuni punti non si muovono, altriinvece hanno movimenti di alcuni decimetri all’anno.
Frana di Trafoi
Questa frana si trova in orografica sinistra a monte dell’abitato di Trafoi, fra la malgaalta di Tarcese il rifugio
Forcola e copre un’area di circa 600 ha. La frana può essere suddivisa in 2 parti. La parte superioreè compresa fra i 2000 e i 2900 m s.l.m. e viene monitorata dall’Ufficio Pianificazione Forestale con 11 punti di misurazione. Nell’anno 2023 è stato effettuato un rilievo nel mese di giugno In 4 degli 11 punti si notano dei movimenti che variano fra i 2 e i 6 cmcon riferimento l’anno precedente e sono in linea l’andamento dell’ultimo periodo. I restanti puntiinvece non si muovono.
Nel 2023 l’Ufficio Pianificazione Forestale ha effettuato su tutti i 33 punti misurazioni GPS di precisione. I risultati di queste misurazioni vengono trasmessi annualmente all’Ufficio Geologia e prove materiali e costituiscono un’importante base dati per il monitoraggio di queste frane.
«« Ulterioriinformazioni sono accessibili in Internet al seguente indirizzo: https://www.provincia.bz.it/agricoltura-foreste/bosco-legno-malghe/studi-progetti/ gps-monitoring.asp
Corvara (a sinistra) e Trafoi (a destra) »»



“Proteggiamo e utilizziamo le risorse naturali che ci vengono affidate. In maniera sostenibilee responsabile”. Questa è la missione dell’Agenzia Demanio provinciale, che, nella gestione del patrimonio indisponibile ad essa affidato, prosegue il suo impegno a favore della sostenibilità, secondo le logiche dell‘economia circolare e della preservazione delle risorse naturali in materia di agricoltura, selvicoltura e giardinaggio. L’Agenzia è un ente strumentale della Provincia autonoma di Bolzano, ma allo stesso tempo è dotata di caratteristiche da impresa di tipo privato. Tramite l’Azienda agricola Laimburg e l’Azienda forestale, essa provvede alla gestione dei terreni demaniali, siano essi agricoli, forestali o montani, e delle relative infrastrutture. Inoltre, essa si occupa dei venti poderi di proprietà provinciale, di quattro stazioni di vigilanza forestale, dei Giardini di Castel Trauttmansdorff a Merano, della Scuola forestale Latemar e della Segheria demaniale Latemar a Nova Levante, nonché del Centro Tutela Specie Acquatiche a Scena.

Oltre a ciò, l’Agenzia segue amministrativamente lo sviluppo di più di 1500 progetti facenti capo alla ripartizione Natura, Paesaggio e Sviluppo del territorio, al dipartimento Foreste e all’Agenzia per l’ambiente; essasi occupa anche della realizzazione di importanti lavori per la Provincia autonoma: cura delle foreste, rimboschimenti, stabilità delle pendici, difesa dalle valanghe, protezione dei biotopi, sentieri per escursionisti, interventi d’urgenza in caso didanni causati da fenomeni climatici e molto altro.

L’Agenzia Demanio provinciale è costituita da 5 settori, con funzioni sia organizzative che di servizio: l’Azienda agricola Laimburg, l’Azienda forestale, i Giardini di Castel Trauttmansdorff, l’Amministrazionee l’Amministrazione immobili L’attività principale dell’Agenzia consiste nella gestione e nella tutela sia delle zone di alta montagna che delle superfici agricole e forestali, facenti parte del patrimonio indisponibile della Provincia, nonché dei beni immobili ad essi pertinenti. Oltre ai suddetti settori, fanno parte dell’Agenziaanche la Scuola forestale Latemar, la Segheria demaniale Latemar e il Centro Tutela Specie Aquatiche. È compito dell’Agenzia conservare e impiegare al meglio le proprietà demaniali della Provincia. Con oltre
L‘Agenzia Demanio provinciale in cifre
Superficie complessiva Agenzia Demanio provinciale75.000 ha Bosco 5.074 ha
Terreni agricoli 224 ha
I Giardini di Castel Trauttmansdorff12 ha
Centro Tutela Specie Acquatiche 2 ha
Concessioni 601
Concessioni di caccia 73
Contratti attivi 9
Contratti passivi 20 Immobili 73
140 ettari di terreni dedicati alla frutticoltura, 50 ettari alla viticoltura, circa 15 ettari di prati, 5 ettari scarsi di
orticoltura e ca 5.070 ettari di bosco, l’Agenzia è l’aziendaagricola e forestale più grande della Provincia.
All‘Aziendaagricola Laimburg appartengono 20 poderi situatiin varie zone dell’Alto Adige: dalla Val Venosta passando per il Burgraviato, l’Oltradige, la Bassa Atesina fino alla Val Pusteria. Tutte le diverse tipologie di coltivazione locale trovano così una loro applicazione: agricolturaalpina, frutticoltura, viticoltura, orticoltura, cereali, coltivazione di piccoli frutti e piante officinali e aromatiche, apicoltura. Inoltre, nei 4 masi di Freiberg-Montefranco sopra


Merano vengono coltivate le castagne.
La produzione di frutta viene venduta a diversi consorzi frutticoli, mentre l’uva vendemmiata viene destinata all’azienda vinicola Cantina Laimburg e ad altre cantine.
È difficile fare un paragone tra l’Azienda agricola Laimburg e le altre aziende agrarie in provincia, poiché gran parte delle superfici agricole sono affidate al Centro di Sperimentazione Laimburg e destinate ai fini della ricerca scientifica; inoltre, l’Aziendaagricola è parte di un ente pubblico e deve quindi rispettare delle direttive diverse da quelle di un’aziendadi tipoprivato (p.e. in materia di appalti, gestione del personale, contabilità, sicurezza sullavoro, ecc.).
Obiettivo: un sistema di irrigazione di precisione per tutti i poderi L‘Agenzia Demanio provinciale, oltre alla produzione ecologica edeconomicamenteefficace di alimenti sicuri, sani e di alta qualità, ha un ulteriore obiettivo nell’utilizzo parsimonioso delle risorse. I sistemi di irrigazione dell‘Azienda agricola vengono costantemente convertiti a sistemi di irrigazione a goccia e quindi, gradualmente, si passerà a un sistema d‘irrigazioneerogataal bisogno, tramite monitoraggio con sensori.
Nel 2022 il Moarhof di Labers a Merano è stata la primaaziendaa usufruire del sistema di irrigazione automatica di precisione. Di conseguenza, in un’annata molto secca come l’attuale, si è potuto risparmiare una gran quantità di acqua, se paragonata al precedente anno 2021, senza causare impatti negativi in termini di resa e di qualità. Grazie a tali risultati molto positivi, nel 2023 sono statiinstallati sensori di rilevamento dell’umidità del suolo anche in tutte le altre aree frutticole e viticole dell‘Aziendaagricola Laimburg. Dal momento che, nel corso del 2023, i risultati sono stati di nuovo molto positivi, si proseguirà a lavorare ulteriormente per ottimizzare i sistemi di irrigazione con l’automatizzazione del rilevamento di fabbisogno idrico in frutticoltura e viticoltura
Stagione agricola 2023
Nel 2023, la produzione di mele dell’Aziendaagricola Laimburg è stata buona, sia dal punto di vista quanti-

tativo che qualitativo. In particolare, la varietà Pink Lady ha impressionato per la straordinaria produttività, sebbene il clima, durante le fasi conclusive di raccolta, non sia stato l’ideale, causando alcune difficoltà per l’immagazzinamento. É stata nuovamente registrata una buonaannata anche per la vendemmia, sia per qualità che per quantitativi di raccolto, malgrado le condizioni climatiche nel 2023 non siano state eccezionali come per il 2022.
Parassiti e malattie
La stagione agricola 2023 si è svolta nella media, in termini di infestazioni
parassitariee di insorgenza di malattie. Il problema dell’afide lanigero (pidocchio del melo) continua ad aggravarsi, in conseguenza alla riduzione dell’utilizzo di sostanze pesticida, e ciò rappresenterà sicuramente una delle maggiori sfide in futuro per la coltivazione delle mele altoatesina. Inoltre, in diversiimpianti, negli ultimi anni sisono avuti problemi con infestazioni di acari tetranichidi.
In viticoltura, in Alto Adige ha continuato ad ampliarsi l’infestazione di flavescenza dorata: in futuro questa malattia sarà riscontrabile su tutto il territorio e occorre quindi contrastarla efficacemente. Nel corso del 2023 la
lotta alla peronospera e all’oidio (mal bianco) è stata più difficile che in altri anni.
Nel corso del 2023 sono stati realizzati un po’ menonuoviimpianti, dal momento che molto era già stato fatto negli anni precedenti e lo stato degli impianti nell’Azienda agricola Laimburg è attualmente molto buono. Si è quindi optato per rinnovare solo alcuni singoliimpianti mirati, poco redditizi, anche perché è piuttosto complicato ottenere nuove varietà di piante da coltivare.
Mele 6.197t
Volume dei raccolti 2023 Coltura
Uva 3.266 dt
Latte 236.317l
Miele 937 kg
Piante officinali e aromatiche secche 158 kg
Verdura 55.014 kg
Ciliegie 8.508 kg
Castagne 1.240 kg
Olive 0 kg
Drupee frutti a bacca 1.050 kg
Frutticoltura di cui melicolturaa produzione biologica:
Vivaio
Viticoltura di cui viticolturaa produzione biologica:
Ciliegie
Frutti a bacca
Albicocche
Altra frutta
Piante officinali e aromatiche
Cereali
Verdure
ha
ha
ha
ha
ha
ha
ha
ha
ha
Prati13,6 ha
Prati temporanei
Patate
ha
ha
Mais per mangime 1,4 ha
* Superficie lorda secondo Lafis, situazione: luglio 2023
La famosa meta escursionistica dell‘Alto Adige, che si estende su una superficie di 12 ettari, da più di vent’anni mette in mostra oltre 80diversi paesaggi botanici ispirati a tutto il mondo. Nell’area dei Giardini si trovano,oltre a diverse coltivazioni a tema e collezioni di piante, anche numerosi padiglioni artistici e stazioni sensoriali da sperimentare Premiato come uno dei giardini più belli a livello internazionale, i Giardini di Castel Trauttmansdorff a Merano oggi puntano soprattutto al loro ruolo di struttura modello, in senso ecologico.
La seconda migliore stagione dalla creazione dei Giardini
Grazie a 422.449 visitatori e visitatrici, la stagione 2023 è stata la seconda migliore in 23 anni di esistenza dei Giardini, raggiungendo il record mensile adaprile con 76.158 ospiti. In questa stessastagione, il team didattico dei Giardiniha condotto 1298 visite guidate: di queste, il 28% erano rivolte alle scuole in forma di azioni didattiche o itinerari a tema, il 36% erano dedicate a prenotazioni di gruppi e un altro 36% a visite individualiin date prestabilite.
Tema annualeed eventi
La stagione 2023 si è svolta all’insegna del tema “Neofite invasive”: in vari punti sono state messe in mostra 35 varietà diverse di queste piante alloc-
tone, con le descrizioni degliimpatti negativi che esse hanno avuto sull’ambiente. Il Touriseum ha proposto nuovamente la mostra “We need you”. L’edizione 2023 della rassegna internazionale World Music Festival ha avuto largo successo: due concerti, dei cinque proposti, sono andati sold-out e nel complesso hanno partecipato circa 7000 spettatori.
Nei mesi estivi sono stati realizzati numerosi eventi, tra i qualii beneamati picnic serali al Laghetto delleninfee. Un buon riscontro si è avuto anche con la proposta autunnale dei laboratori di decorazione artistica. La novità della stagione è stato l’evento “Wine & Garden” con i Vignaioli dell’Alto Adige, che ha riscosso grande consenso
Pianificazione, tecnologia e cura dei Giardini
Anche nel 2023 i Giardinihanno esibito una superba fioritura primaverile ed estiva, grazie alle piantine stagionali coltivate presso la Giardineria Laimburg.
Oltre alle coltivazioni temporanee, sono stati effettuatiinterventi di integrazione in diverse aree. È stata creata un’altra aiuola di yucca resistente al freddo, che però sarà aperta al pubblico solo dopo i previsti lavori di costruzione. Un altro obiettivo del 2023 era e sarà anche nei prossimi

anni l‘aumento di piante esotiche in vaso e rarità.
In qualità di centro qualificato per i metodidi rafforzamentodelle piante, i Giardini di Castel Trauttmansdorff sperimentano sempre nuovi prodotti, alla ricerca di soluzioniinnovative Oltre al rinforzo di piante e terreni finora eseguito, si è provveduto, nel corso del 2023, a introdurre con successo diverse varietà di funghi, come ad esempio il Trichoderma, per lalotta biologica a malattie fungine; il Mykorrhiza, perrafforzare l’apparato radicale delle piante; la varietà Metarhizium anisopliae, un fungo che colpisce diversiinsetti parassita. Con i rifiuti vegetali dei Giardini, si è provveduto a produrre circa 400 m³ di compost, il quale, arricchito da microorganismi viventi e da carbone vegetale, torna ad essere mescolato al terreno. L’impianto di compostaggio è stato visitato a settembre da una delegazione internazionale, nell’ambito del progetto europeo CORE, in collaborazione conl’ufficio Gestione rifiuti.

Per assicurare una maggiore sicurezza degli alberi, si è provveduto a controllare la stabilità di circa mille esemplari e, per settecento di loro, si è proceduto a svolgere i necessari interventi di potatura.


2023
Superficie 12 ha
Stagione 229 giorni (1° aprile fino al 15 novembre)
Visitatori/visitatrici
Visitatori/visitatrici/giorno
Mesi di maggior affluenzaaprile (76.158) e agosto (69.227)


L’Azienda forestale dell’Agenzia Demanio provinciale amministra oltre 75.000 ha di territori in area alpina, di cui 5.070 ha sono costituiti da boschi, proprietà della Provincia. La supervisionee la gestione delle superfici forestali sono affidate a quattro stazioni forestali.
Ilavori continuano a essere condizionati da un’elevata produzione di legname danneggiato
Presso l’Azienda forestale, i lavori di selvicoltura sisono concentrati su quelli resi necessari dagli effetti della tempesta di vento VAIA nel 2018 e per le precipitazioninevose nel 2019 e 2020. Il tasso annuo sostenibile di prelievi dalle foreste demaniali, di circa 11.000 m³, si è concretizzato invece in una produzione pari a totali 33.000 m³ di legname. L’incidenza dell’infestazione da bostrico, nel 2023, è stata pari al doppio degli esemplari destinati annualmente al prelievo, in tutte le foreste demaniali. A ciò si sono aggiunti gli abbattimenti provocati da tempeste di vento, per un volume pari ai prelievi di un intero anno Circa il 75 % dellegno danneggiato è stato asportato dai boschinel corso di questo stesso anno
A causa di questi considerevoli lavori di smaltimento, non si aveva più mano-

dopera sufficiente per gli ordinari lavori di cura e diradamento. Inoltre, gliinterventi di rimboschimento sono attualmenteesposti a rischio di infestazione, in quanto durante un massicciointerventodi posa, ogni terrenodissodato favorisce l‘infestazione da bostrico La stazione di vigilanza forestale Aica ha organizzato la tradizionale consegna dell‘albero di Natale per il capoluogo Bolzano. In questa occasione, l‘albero per piazza Walter è arrivato da Maranza. L’abbattimento e il trasporto dell’albero di Natale destinato a Vienna hanno richiesto particolari sforzi Per tradizione, ogni nove annila piazza del Municipio di Vienna è decorata da un abete di circa trenta metri proveniente

dall’Alto Adige. Quest’anno si è trattato di un abete proveniente dalla val di Rudo nel comune di Marebbe.
Segheria demaniale Latemar
Le zone boschive del comune di Nova Levante sono state colpite come mai prima d’ora da gravi eventi calamitosi: nel corso del 2023 si è proceduto ad asportare 21.000 m³ di legname infestato e altri 6.000 m³ di materiale abbattuto da tempeste di vento. Tale volume di legname corrisponde ai prelievi complessivi di otto anni, con il risultato che, in un solo anno, circa il 4 % della superficie boschiva è stato disboscato La raccolta dellegnameè stata realizzata conl’impiego di propria forza lavoro e macchinari, ma anche con l’intervento di ditte esterne. Un tale imponente quantitativo di legname non poteva essere smaltito unicamente dalla segheria Latemar; si è pertanto proceduto a vendere il tondame a terzi tramite aste e vendite in stock.
Ancheillegnameprodottoinaltriboschi della Provincia è stato messo all’asta, eccetto piccoli quantitativi di larice e pino cembro.
A causa del notevole volume di tondame fresco, provocato dalle tempeste di vento, per l‘estate si è dovuto rimettere in funzione il deposito a irrigazione presso il lago di Carezza, quello stesso deposito realizzato nel 2019 a seguito della tempesta Vaja
Nella segheria Latemar è stato processato un volume di tondame pari a circa 8.200 m³, nella stagione di taglio che andava da ottobre 2022 ad agosto 2023.
2.3.3
Monitoraggio della fauna selvatica e altri compiti
Tra gli innumerevoli compiti degli agenti forestali dell‘Agenzia Demanio provinciale si può menzionare il monitoraggio di marmotte, ungulati e galliformi, nonché di grossi predatori Nella foresta del Latemar, molto probabilmente anche a causa della ricchezza di prede, un branco di lupi della vicina Val di Fassa ha fatto sosta con frequenza regolare. Tuttavia, lì e in altre foreste demaniali, soprattutto in seguito alla recente distruzione delle aree boschive, è stato necessario il prelievo di fauna selvatica per mantenere una corretta rigenerazione delle foreste. È stato incrementato l’abbattimento di esemplari femmina di cervo da parte del personale forestale. D‘altra parte, la popolazione di camosci presente nelle aree boschive, al momento, viene per la maggior parte preservata, in quanto laloro situazione attualeè compromessa dalla rogna.
Le zone di alta montagna, all’infuori delle foreste demaniali, sono assegnate a loro volta in concessione, in qualità di riserve di caccia; in tal caso, i forestali devono limitarsi adattività di supervisione e controllo delle concessioni. La stazione di vigilanza forestale di Funes ha collaborato in-

tensamente con la Scuola forestale Latemar per l‘organizzazione e l‘allestimento dei corsi di lavoro forestale. Per i corsi di caccia è particolarmente utile il recinto per selvaggina Zannes.
Collaborazione scientifica Utilizzando nuove tecnologie, l‘Ufficio di Pianificazione forestale, in collaborazione conla Libera Università di Bolzano, ha elaborato il piano di gestione forestale Chiusa: con l’ausilio dellaser scanner sono stati com-

piuti, via elicottero, dettagliati rilevamenti delle aree boschive, che ora sono a disposizione per la raccolta di dati sul legname. Questo metodo innovativo di pianificazione gestionale delle foreste demaniali è stato finora il primo ad essere attuato e con il metodo LiDAR ha permesso di fare una stima dello stock di legname. Il lavoro di ricerca della Libera Università di Bolzano continua a concentrarsi soprattutto sulla distinzione, la più precisa possibile, delle diverse specie


arboree, in condizioni di interpretazione automatizzata dei dati. LaLibera Università di Bolzano ha condotto indagini di ricerca sul bostrico nei boschi di Kölblegg a Nova Levante.
Il progetto di ricerca prevede misurazioni fisiologiche degli esemplari di albero contorti e striminziti: ciò dovrebbe approfondire le conoscenze sui fattori di stress e inaridimento che affliggono gli alberi, causandone la perdita di vitalità
Ambito di attività nelle aree demaniali di alta montagna
In passato, lo sviluppo e le attività concernenti il patrimonio demaniale non sono sempre stati realizzati conla dovuta attenzione, in materia di natura e ambiente.
Vivaio forestale Aica
Il vivaio forestale Aica si adopera per incrementare la produzione di flora selvaticaautoctona, in particolare latifoglie e arbusti, così da incontrare un pubblico più ampio. Il vivaio forestale vuole così promuovere il patrimonio culturale del „paesaggio a siepe“, con-

tribuendo alla sua conservazione e a quella dell’ambiente naturale in Alto Adige. Nel 2023 il personale del vivaio forestale ha proseguito la raccolta di sementi rinforzate per la produzione di arbusti rustici autoctoni, da allevare nei prossimi anni Nel corso del 2023 sono stati prodotti circa 1400 arbusti selvatici e 600 esemplari di latifoglie, oltre a 37.000 piante per il rimboschimento. L’assortimento per la vendita comprendevaanche salici da vimini.
Gli acquirenti sono perlopiù enti pubblici e aziende private, ma anche semplici privati.



La missione principale del Centro Tutela Specie Acquatiche consiste nella salvaguardia della fauna ittica autoctona.
Preservazione della molteplicità e delle caratteristiche genetiche delle specie ittiche
Il compito principale del Centro Tutela Specie Acquatiche è preservare la fauna ittica dei fiumi altoatesini, anche tramite ripopolamento. Il lavoro del Centro si focalizza in particolare sulla trota marmorata, la regina dei principali corsi d’acquaaltoatesini. Per ciò che riguarda la genetica, ci si occupa innanzitutto della preservazione
dellecaratteristichegenetichenaturali delle specie Il concetto di base consiste nel sostenere la popolazione esistente grazie a un’opera di incremento e allevamento di giovani esemplari selvatici. A questo scopo, ogni anno vengono catturati esemplari di trote marmorate cresciute allo stato naturale, da cui ottenere uova per la riproduzione Nel 2023 sono state fecondate complessivamente circa 30.000 uova, di cui la maggior parte ha potuto già essere reintrodotta nelle acque d’origine. Una piccola parte di questa discendenza viene allevata in condizioni simil-
naturali, così che negli anni a venire si possa contare su un numero sempre maggiore di uova per la riproduzione. Per evitareeffetti di addomesticamento, si è provveduto ad adeguare progressivamente sia il mangime utilizzato che le strutture proprie del Centro, affinché corrispondano sempre più a un habitat naturale Nel periodo di crescita, le trote marmorate vivono in un canale artificiale costruito appositamentee che ha le sembianze di un ruscellonaturale. Nell’autunno 2023, per la prima volta, il grande stagno denominato “grande gorgo” è stato svuotato dai pesci. In questo modo sono stati recuperati alcuni esemplari di trote marmorate, che ormai erano diventati notevoli Dalla spremitura di questi è stata ricavata una ragguardevole quantità di uova. Complessivamente, nell’impianto sono state messe inincubazione circa 250.000 uova, delle quali 90.000 sisono trasformate in avannotti. Il resto delle uova di trota marmorata è stato distribuito direttamente in acque naturali, grazie anche alla collaborazione conl’ufficio Caccia e pesca.
Temoli, gamberi di fiume e pesciolini
Un secondo importante progetto del Centro Tutela Specie Acquatiche è la conservazione della popolazione autoctona di temolo adriatico. A questo scopo, nel corso della prima fase di progetto, si è provveduto a rilasciare diverse centinaia di esemplari nel Lago di Valdurna. Lì essi potranno riprodursi e creare una coloniaautonoma. Altri cosiddetti ceppi genetici sorgeranno in val d’Ultimo nei fiumi Valsura e Passirio. I primi esemplari di temolo sono stati liberati nel Valsura già nel 2023, mentre per il 2025 è pianificato l’avvio degliinterventi di insediamento nel Passirio.
Anche gli sforzi attorno alle sanguinerole stanno procedendo bene: già da alcuni anni, presso il Centro vengono allevati con successo esemplari autoctoni,identificati geneticamente, che si moltiplicano in uno stagno naturale Nell’estate 2023, come già in quella precedente, le sanguinerole sono state rilasciate nellago di S. Valentino alla Muta, da dove dovrebbero distribuirsi e ripopolare il territorio provinciale.
Per quanto riguarda il gambero di fiume, si hanno anche buoni risultati: gli esemplari si riproducono nello stagno naturale presso il Centro. Nel 2023 si è proceduto a prelevare alcune centinaia di individui, che sono stati messi a disposizione per la reintroduzione Una parte di essi è stata rilasciata in uno stagno remoto, lontano da fattori didisturbo e di interferenze ambientali; il resto è stato rilasciato in un fosso in Bassa Atesina. Nei prossimi anni sarà dato sapere se i gamberi di fiume sisaranno insediati con successo e se si staranno riproducendo.



2023
(Le cifre riguardanti gli anni precedenti sono tra parentesi.)
La Scuola forestale Latemar è un centro di formazione forestale, venatoria e ambientale. In attività dal 1973, oggi essa fa parte dell’Agenzia Demanio provinciale. Dal 2006 la sua sede si trovaa Carezza, nel comune di Nova Levante.
Programma delle manifestazioni di nuovo a livello pre-pandemia
La pandemia da Covid-19 può essere considerata definitivamente superata nel 2023, dal punto di vista dell’organizzazione e svolgimento del programma formativo alla scuola forestale. La struttura eraa piena capacità e gli eventi in programma, quali corsi e seminari, hanno potuto aver luogo senza limitazioni.
Cacciatrici e cacciatori ben formati
Sono stati proposti corsi su tematiche di arte venatoria in lingua tedesca e italiana, rivolti a tutti gli appassionati di caccia, siano essi provenienti dall’Alto Adige, come dal resto d’Italia L’obiettivo principale di questi corsi è ampliare le competenze e le conoscenze di cacciatori e cacciatrici.
I corsi venatori in lingua tedesca,ad es. il corso per neo-cacciatori e il corso per accompagnatori al camoscio, erano costantemente al completo Particolarmente richieste la formazione per conduttore di cane da traccia e le prove per i cani da lavoro e assistenza Sono stati proposti anche nuovi corsi, come ad esempio la tassidermia per princi-
pianti. Apprezzati in modo particolare sono stati i corsi per il completo utilizzo e lavorazione della selvaggina.
I corsi venatori in lingua italiana sono stati frequentati da cacciatori e cacciatrici provenienti da tutto il territorio nazionale con grande soddisfazione
Riguardo ai corsi di lavoro boschivo, continua la grande richiesta e presenza di nuovi istruttori
La formazione continua professionale per persone impegnate nellavoro boschivo, sia in quanto attività principale che secondaria, rappresenta un settore di grande importanza per il territorio altoatesino. Obiettivo primario è impedire il verificarsi di incidenti, che comportano spesso gravi conseguenze. Presso i vari ispettorati forestali di tutta la Provincia sono stati realizzati più di cento corsi di lavoro boschivo, ma l’interesse è in continua crescita. Anche per questo motivo, a inizio 2023 è stata organizzata la formazione per istruttori Dopo un percorso didattico di tre settimanee numerosi tirocini, abbiamo oggi in servizio sette nuovi istruttori
Utilizzazioni boschive ed esbosco dellegname
Nel 2023 sono stati realizzati diversi corsi relativi al taglio e all’esbosco del legname con trattore e verricello; un altro corso ha riguardato lo svolgimento di lavori in quota su alberi Invece, il corso di esbosco con gru a cavo ha dovuto essere cancellato.
Corsi di formazione peragenti forestali
Tra ottobre 2022 e aprile 2023, ha avuto luogo il corso di formazione di sei mesi per 25 agenti forestali. Poiché altri corsi sono stati organizzati dalla Scuola forestale contemporaneamente allo svolgimento della formazione ad agenti forestali, una parte dei partecipanti è stata ospitata esternamente alla scuola forestale.
Danni da infestazione da bostrico
Visto il perdurare dell’attualità del tema, anche nel 2023 è stata organizzata una giornata informativa dedicata al bostrico, in collaborazione con la ripartizione Servizio forestalee il reparto formazione del Südtiroler Bauernbund. Le persone interessate hanno potuto essere informate sulle cause del problema attuale, sulle caratteristiche biologiche dell’insetto e sui provvedimenti in essere e finanziamenti disponibili.






Regionalità e diversità: sono i due pilastri dell’agricoltura e della silvicoltura in Alto Adige, che saranno sostenuti e consolidati anche con il nuovo Programma di Sviluppo Rurale.

2.4.1
Programma di Sviluppo Rurale
2014-2022 della
Provincia Autonoma di Bolzano
– Regolamento (UE) n. 1305/2013 del 17 dicembre 2013
Approvazione del PSR da parte della CE:
Il Programma di Sviluppo Rurale 2014-2020 della Provincia Autonoma di Bolzano n.2014IT06RDRP002 è stato approvato dalla Commissione dell’Unione Europea con decisione n. C(2015) 3528 del 26.05.2015 modificato con decisione n. C(2022) 5586 del 27.07.2022, e dalla Giunta provinciale con delibera n. 727 del
16.06.2015, ultimamente modificata con delibera n. 13263 del 03.08.2022. La visura attuale dell’opuscolo del Programma di Sviluppo Rurale 2014 – 2022 è pubblicata sulla pagina web della Ripartizione Agricoltura (http://www.provincia.bz.it/agricoltura/service/pubblicazioni.asp).
Approvazione del PSR da parte della Giunta Provinciale:
La Giunta Provinciale ha approvato il PSR con Deliberazione del 16 giugno 2015, n. 727, modificata con decreto n. 13263 del 03.08.2022.
Pubblicazione delle deliberazioni di Giunta
sul Bollettino della Regione Trentino/Alto Adige:
• La Deliberazione del 16 giugno 2015, n. 727 è stata pubblicata nel Bollettino Ufficiale n. 25/I-II del 23/06/2015.
• La Deliberazione n. 1280del 21.11.2017 è stata pubblicata nel Bollettino Ufficiale n. 48/I-II del 28/11/2017.
• La Deliberazione n. 1122 del 17.12.2019 è stata pubblicata nel Bollettino Ufficiale n. 52/Sez. gen. del 27/12/2019
• DLa Deliberazione n. 382 del 09.06.2020 è stata pubblicata nel Bollettino Ufficiale n. 25/Sez gen. del 18/06/2020
Riunione del Comitato di Sorveglianza:
Il 7 giugno 2023 si è tenuta a Bolzanola nona riunione annuale del Comitato di Sorveglianza.
Punti presiin esami durante il Comitato di Sorveglianza:
• Presentazione della Relazione Annuale di Attuazione anno 2022
• Avanzamento del PSR 2014-2022 (Fondi QFI, EURI e Top-up) al 18 maggio 2023
• Verifica del disimpegno automatico n+3 al 18 maggio 2023
• Relazione del Valutatore Indipendente (Leader e PSR)
• Presentazione al Comitato delle attività di comunicazione
• Informativa sul tasso di errore
Misura 1 Trasferimento di conoscenze e azioni di informazione 1.800.000,00
Misura 4Investimentiinimmobilizzazioni materiali54.351.942,48
Misura6 Aiuti all'avviamento di imprese per i giovani agricoltori (es premio insediamento) 35.220.896,00
Misura 7Servizi di base e rinnovamento di villaggi nelle zone rurali 17.779.104,00
Misura8 Investimenti nello sviluppo delle aree forestali e nel miglioramento della redditività delle foreste 24.709.139,62
Misura 10 Pagamento agroambientale 137.450.000,00
Misura 11 Agricoltura biologica12.550.000,00
Misura 13 Indennità compensativa 156.000.000,00
Misura 16 Cooperazione 2.000.000,00
Misura 19 Sostegno allo sviluppo locale LEADER 26.135.061,35
Misura 20 Assistenza tecnica2.000.000,00 totale 469.996.143,45
Totale spesa pubblica al 31 dicembre 2023
Misura 04 (4.4)
Misura 19 (19.3)
Misura 19 (19.4)
2.4.2
nazionale della PAC 2023-2027
Regolamento (UE) n. 2021/2115 del Parlamento
europeo e del Consiglio del 2 dicembre 2021
Il Piano strategico nazionale della PAC 2023-2027 è stato approvatodalla Commissione Europea con Decisione n. C(2022)8645 finale del 2 dicembre 2022 e modificato con Decisione C(2023) 6990 del 23 ottobre 2023
Il Regolamento (UE)n. 2021/2115 del Parlamento europeo e del Consiglio del 2 dicembre 2021 reca le norme sul sostegno ai piani strategiciche gli Stati membri devono redigere nell’ambito della politica agricola comune (piani strategici della PAC) e finanziati dal Fondo europeo agricolo di garanzia (FEAGA) e dal Fondo europeo agricolo per lo sviluppo rurale (FEASR) e che abroga i regolamenti (UE) n. 1305/2013 e (UE) n. 1307/2013. Il Regolamento (UE) n. 2021/2116 del Parlamento e del Consiglio del 2 dicembre 2021 regola il finanziamento, sulla gestione e sul monitoraggio della politica agricola comune e abroga il regolamento (UE) n. 1306/2013.
Interventi di sviluppo rurale attivati dalla Provincia Autonoma di Bolzano
SRA08 – gestione prati e pascoli permanenti
SRA09 – impegni gestione habitat natura 2000
SRA14 – allevatori custodi dell’agro biodiversità
La Giunta provinciale con Delibera n. 959 del 13.12.2022 ha approvato la Costituzione del Comitato di Monitoraggio regionale per l’attuazione degli elementi regionali della Provincia Autonoma di Bolzano – Alto Adige del Piano Strategico nazionale della PAC 2023-2027 ai sensi del Regolamento (UE) n. 2021/2115.
La prima riunione del Comitato di Monitoraggio regionale per l’attuazione degli elementi regionali della Provincia Autonoma di Bolzano è stata convocata il 19 gennaio 2023. Il Complemento per lo Sviluppo Rurale (CSR) del Piano Strategico della PAC 2023-2027 della Provincia autonoma di Bolzano – Alto Adigeè stato approvato con Delibera della Giunta Provinciale del 31/01/2023 n. 100. L’ultimamodifica del CSR è stataapprovata con Decreto del Direttore della Ripartizione Agricoltura n. 2273/2024 del 16/02/2024
SRA29 – pagamento al fine di adottare e mantenere pratiche e metodidi produzione biologica
SRA30 – benessere animale
SRB01 – sostegno zone con svantaggi naturali montagna
SRD01 – Investimenti produttivi agricoli per la competitività delle aziende agricole
SRD04 – Investimenti non produttivi agricoli con finalità ambientale
SRD11– Investimenti non produttivi forestali
SRD12 – Investimenti per la prevenzioneed il ripristino danni foreste
SRD13 – Investimenti per la trasformazione e commercializzazione dei prodotti agricoli
SRD15 – Investimenti produttivi forestali
SRE01 – Insediamento giovani agricoltori
SRG01 – Sostegno gruppi operativi PEI AGRI
SRG05 – Supporto preparatorio LEADER- sostegno alla preparazione delle strategie di sviluppo rurale
SRG06 – LEADER - attuazione strategie di sviluppo locale
SRH03 – SRH03: Formazione degliimprenditori agricoli, degli addetti alle imprese operanti nei settori agricoltura, zootecnia, industrie alimentari, e degli altri soggetti privati e pubblici funzionali allo sviluppo delle aree rurali
SRH05 – Azioni dimostrative per il settore agricolo, forestaleed i territorirurali


Il Centro di Sperimentazione Laimburg, fondato nel 1975, è un ente strumentale dalla Provincia Autonoma di Bolzano dotato di propria personalità giuridica, che realizza attività di ricerca e sperimentazione negli ambiti dell’agricoltura e della trasformazione alimentare.
La ricerca svolta dal Centro Laimburg promuove la coltivazionee la realizzazione di prodotti agricoli e alimentari altoatesini di qualità. Qui lavorano ogni anno oltre 200 collaboratrici e collaboratori a circa 380 progetti di ricerca sia nei laboratori a Vadena e al NOI Techpark, sia sui campi sperimentali dell'Agenzia Demanio provinciale, con la quale il Centro mantiene una storica collaborazione. La ricerca scientifica spazia in tutti i settori dell’agricoltura altoatesina: dalla frutticoltura, alla viticoltura, dall’agricoltura montana fino alle colture specializzate come ortaggi, piccoli frutti e frutta con nocciolo.
Nel settore delle scienze alimentari, sviluppatosi in concomitanza con il NOI Techpark, il Centro di Sperimentazione Laimburg continua a incrementare le proprie competenze tecniche negli ambiti della trasformazione degli alimenti, della qualità e dell’innovazione di prodotti, ampliando l’offerta dei servizi alle aziende operanti nel settore alimentare. Con il suo lavoro sostiene così l’intera filiera produttiva, dal campo fino al prodotto finito. I laboratori del Centro forniscono a questo scopo un contributo importante nei vari settori di competenza, effettuando analisi di terreni, organi vegetali e foraggi, così come analisi dei residui, analisi chimico-fisichee microbiologiche di mosti, vino, succhi di frutta e distillati.


Il Programma di attività del Centro di Sperimentazione Laimburg viene stilato a stretto contatto con i Comitati scientifici di settore, nei quali, accanto alle ricercatrici e ai ricercatori del Centro, sono presenti i portatori d’interessi del mondo agricolo e della trasformazione alimentare locale. In questo modo si assicura che i programmi di ricerca e sperimentazione siano sempre indirizzati verso le necessità concrete della pratica in Alto Adige. Nel 2023, oltre 130 rappresentanti dei gruppi d’interessi hanno presentato 118 proposte di progetti: 49 di queste proposte sono state integrate in sperimentazioni esistenti e per ulteriori 35 proposte sono stati avviati dei pro-
getti di ricercaad hoc nel Programma delle attività del 2024 del Centro.
Le collaboratrici e i collaboratori del Centro sono impegnati fortemente anche nell’insegnamento e nella divulgazione delle conoscenze, per trasmettere a studentesse e studenti della Libera Università di Bolzano e degliistituti professionali agrari le loro conoscenze tecniche.
Tutti i progetti, le attività e le pubblicazioni del Centro di Sperimentazione
Laimburg possono essere scaricati dal sito www.laimburg.it. A cadenza biennale vieneedito il “Laimburg Report”, che offre un quadrod’insieme della struttura e delle attività del Centro.
Inoltre, sul Laimburg Journal (www. journal.laimburg.it), rivista digitale open access del Centro Laimburg, vengono pubblicati articoli originali e relazioni.
Informazioni per il pubblico:
• 384 progetti e attività di ricerca
• 355 relazioni a conferenze
• 29.086 analisi di laboratorio
• 198 pubblicazioni
• 23 progetti di ricerca commissionata per aziende private
• 343 visite guidate al Centro di Sperimentazione Laimburg
• 69 eventi (co-)organizzati 2.5.1

Andreas Wenter, Lorenzo Panizzon, Christoph Thaler, Martin Thalheimer Centro di Sperimentazione Laimburg
L'anno 2023 è iniziato all'insegna della siccità L'inverno 2022/2023 saràricordato per il clima mite e la scarsa neve, con temperature medie a dicembre, seguite da temperature miti a gennaio e febbraio. Dal 18 gennaio al 9 marzo 2023, si è registrato un periodo eccezionalmente lungo di 51 giorni senza precipitazioni.
Anche la primavera del 2023 è stata molto secca per lunghi periodi, con scarse precipitazioni soprattutto a marzo. Il germogliamento eraanticipato rispetto alla mediaa lungo termine per via delle temperature miti di marzo, che registravano una media mensile di 10,1 °C rispetto al valore di riferimento di 8,6 °C Per la varietà di melo di riferimento, la Golden Delicious, lo "stadio di gemma verde"è stato raggiunto a Laimburg il 24 marzo, sei giorni prima rispetto alla mediaa lungo termine. Dopo un inizio di primavera mite, adaprilele temperature sono diventate più fresche A causa del freddo, la fioritura è durata più del solito. La varietà Golden Delicious di Laimburg ha iniziato a fiorire il 3 aprile, raggiungendo la piena fioritura il 9 aprile e terminando la fioritura il 24 aprile (la date della mediaa lungo termine per queste fasi sono invece 12, 16 e 28 aprile). Solo a
maggio le abbondanti piogge hanno reintegrato significativamente le riserve idriche del suolo, compensando il deficit di precipitazioni.
Con una temperatura media di 23 °C, l'estate 2023 è stata più calda della media. In totalele precipitazioni estive hanno raggiunto i 312mm, la maggior parte dei quali caduti a luglio, rendendo l'estate 2023 leggermente più piovosa della media. Una persistente alta pressione con masse d'aria subtropicaliha determinato il meteo nella regione alpina a partire da metà giugno. La prima ondata di calore ha raggiunto il picco nella terza decade di giugno, con una massima di 35,4 °C il 26 giugno. Sono seguite altre due ondate di calore a metà luglio e unaa metà agosto. Alcuni temporali intensi hanno causato danni localizzati per via della grandine. Gli ultimi giorni di agosto sono stati molto piovosi e il clima si è
rinfrescato. Le condizioni per la colorazione dei frutti delle varietà precoci sono state miglioririspetto all'anno precedente, grazie al raffreddamento di fine agosto.
L'autunno 2023 è stato caldo, con una temperatura media di 13 °C, e in particolare i mesi di settembre e ottobre hanno raggiunto nuovi massimi. Non ci sono mai stati 14 giorni estivi a settembre dall'inizio delle registrazioni. Anche le temperature al suolo sono state ben al di sopra della media a lungo termine, con un aumentodi 2,5 gradi Le temperature sono rimaste relativamente stabili per tutto ottobre. Il tanto atteso calo delle temperature per una buona colorazione delle mele si è fatto attendere. Le temperature notturne sono scese solo brevemente intorno al punto di congelamento a metà ottobre. Un periodo particolarmente piovoso si è protratto dal 19 ottobre all'11 novembre, con un totale di 273 mm di precipitazioni Il livello delle falde acquifereè aumentato significativamente conle piogge di fine ottobree inizio novembre Le condizioni di pioggia hanno reso difficilela raccolta delle varietà a maturazione tardiva. A dicembre il clima è stato più simile a quello tardo autunnale che a quello invernale, con leggere gelate mattutine e disgeli. Il periodo natalizio è stato insolitamente caldo. Con 69 mm, le precipitazioni mensili sono state leggermente superiori alla mediaa lungo termine.
Il 2023 è stato l'anno più caldo misurato alla stazione meteorologica di Laimburg dall'inizio delle registrazioni nel 1965.
Complessivamente, i mesi di maggio, luglio, ottobree novembre, caratterizzati da elevate precipitazioni, hanno contribuito in modo significativo al fatto che le precipitazioni annuali di 901 mm sono state superiori alla mediaa lungo termine di816 mm.
Per la prima volta la temperatura mediaannuale ha battendo i 13 °C, superando il record del 2003 con 12,5 °C e la mediaa lungo termine di 11,6 °C Il caldo all'inizio dell'anno e le temperature superiori alla media di settembre e ottobre sono statii principali fattori. L'elevato numero di 59 giorni tropica-

li, rispetto alla mediaa lungo termine di 43, riflette il clima caldo dell'anno scorso. Nel 2023 la stazione meteorologica di Laimburg non ha registrato nemmeno un giorno di ghiaccio.
La nuova Meteo-App del Centro di Ricerca Laimburg
Mentre in precedenza i valori misurati dalle stazioni meteorologiche del Centro Laimburg non erano accessibili al pubblico e venivano pubblicati solo sotto forma di rapporti mensili o annuali, lanuovaapplicazione web "Meteo-App" ha seguito la tendenza generale alla disponibilità gratuita dei dati online. "Questi dati sono visualizzabili e consultabili online dall'inizio del 2024."
La nuova Meteo-App è liberamente accessibile tramite smarthpone o computer. Su Meteo-App gli interessati possono visualizzare e scaricare sia i dati meteo attuali che le tendenze a lungo termine.
La registrazione dei dati meteorologici a Laimburg risale al 1965 La registrazione manuale iniziale è stata automatizzata nel corso dei decenni utilizzando dispositivi di misurazione elettronici. Nel frattempo le sedi sono state ampliate e ora comprendono anche i siti periferici di Orisin Val Venosta, Castel Verruca vicino a Merano e Teodone in Val Pusteria Le stazioni meteorologiche di Laimburg e Oris sono gestite in collaborazione con Ufficio provinciale Meteorologia e prevenzione valanghe.
La Meteo-App consente di accedere ai dati delle quattro località citate con una finestra temporale liberamente selezionabilee con diverse risoluzioni. Ciò significa cheè possibile richiamare o visualizzare informazioni dettagliate sulle condizioni meteorologiche degli ultimi giorni o settimane, nonché su una serie di dati a lungo termine per diversi decenni. Ciò consente di fare affermazioni e valutazioni sull'anda-
mento del meteo nel tempo e sui cambiamenti climatici degli ultimi decenni. Le medie mensili dei singoli anni e la loro deviazione dai valori medi a lungo termine possono essere visualizzate anche nella sezione tendenze a lungo termine.
Nel caso delle precipitazioni, è anche possibile visualizzare i periodi di siccità in un grafico a colori.
La Meteo-App del Centro di Sperimentazione Laimburg può essere utilizzata a diversi scopi, sia in agricoltura che in altri settori.
L’applicazione Meteo con le informazioni sulle quattro stazioni meteorologiche è disponibile al seguente link:
https://meteo.laimburg.it/info


2023 FebbraioMarzo Aprile Maggio Giugno Luglio Agosto Settembre OttobreNovembreDicembre2024 anno
Fig. 1 Il grafico sottostante mostra la fase di bassa precipitazione in primavera e la fase di alta precipitazione alla fine di ottobre 2023, accessibile tramite l'app Meteo. ©Laimburg Research Centre


2.5.3 Istituto di Fruttie Viticoltura
Valutazione di cloni e selezioni massali di
Pinot nero
Josef Terleth
Gruppo di lavoro Varietà e Materiale di Propagazione Viticola
Ulrich Pedri
Gruppo di lavoro Tecniche Viticole e Vinificazione
Il Pinot nero è tutt’ora una delle varietà emergenti, nonché il vitigno rosso più coltivato in Alto Adige. Nel 2023 ha raggiunto una superficie coltivata pari a 568 ettari, che corrisponde a una percentuale del 9,87% della superficie viticola totale.
Negli ultimi decenniil Centro di Sperimentazione Laimburg ha eseguito di-
versistudi sull’idoneità alla coltivazione dei cloni di Pinot nero Nel mercato vivaistico francese, oltre al materiale clonale, vengono anche proposte le cosiddette selezioni massali.
La differenza fondamentale tra un clone e una selezione massale è che il primo nasce da una singola vite, mentre la seconda proviene da più ceppi con caratteristiche simili
Il miscuglio di questi dovrebbe aumentare la biodiversità nel vigneto e conferire al vino maggiore complessità.
I cloni e la selezione massale messi a confronto Per valutare questa affermazione è stato costituito, nel 2018, un impianto sperimentale ubicato a Caldaro nel sito “Trifall”. Oltre alla selezione massale ATVB “fins”, sono stati messi a dimora anche due cloni di provenienza francese, ovvero ENTAV 828 ed ENTAV 943. Grosse differenze si sono riscontrate soprattutto nella forma dei grappoli. Mentre il clone 828 si distingueva per i grappoli regolari, compatti e grandi, il clone 943 era leggermente più irregolare con grappoli più piccoli.





2: profilo dei vini degustatiin prova.
Scala di valutazione da „poco pronunciato“ (0) fino a „molto pronunciato“ (10) – ad eccezione della qualità dei tannini da „poco pronunciato“ (--10) ad ottimale (0) fino a „molto pronunciato“ (10)
Laselezione ATVB “fins”, invece, mostrava una maggiore variabilità di forma, presentandosi con grappoli spargoli adacini piccoli o con grappoli compatti e acini grandi.
Questa diversità non ha rivelato uno schema preciso (Fig 1) Inoltre, le diverse forme dei grappoli, hanno comportato una differente suscettibilità alla botritee al marciume acido. Il clone 828 ha mostrato un maggior numero di infezioni, rispetto al clone 943, dove sono risultate minime, mentre per la selezione ATVB “fins”, la cui suscettibilità si collocava a livello intermedio rispetto ai due cloni, variava notevolmente nelle viti con grappoli compatti Sono state inoltre riscontrate leggere differenze nel grado zuccherino, dove i valoririsultavano lievemente superiori nel clone 828 rispetto agli altri.
Durante la degustazione, i vini del clone ENTAV 828 sono risultati di qualità inferiore sotto molti aspetti rispetto a quelli del clone ENTAV 943 e quelli della selezione ATVB “fins” (Fig 2), in quantotendevano adavere aromi di confettura e note di frutta secca. Sebbenele differenze tra il clone ENTAV 943 e la selezione “fins” fossero minime, quest’ultima ha evidenziato maggiori caratteristiche positive, in particolare in termini di intensità del colore, complessità e speziatura dei vini La selezione ATVB “fins”, inoltre, presenta un contenuto di antociani più elevato. L'elevato valore del pH nel mosto e nel vino del clone ENTAV 828 e allo stesso tempo il grado alcolico leggermente più alto indicano la sua tendenza ad una maturazione precoce.
In sintesi si può quindi affermare che il clone ENTAV 943 e la selezione ATVB “fins” hanno prodotto buoni risultati mentre il clone ENTAV 828, nelle attuali condizioni di coltivazione, non può essereraccomandato senza riserva.

Il sensore "FylloClip":
nuovo sensore per il riconoscimento dello stress idrico
Martin Thalheimer
Gruppo di lavoro Terreno, Concimazione, Irrigazione
Una delle principali sfide del futuro, a causa dei cambiamenti climatici, è l'uso più efficiente delle risorse idriche sempre più scarse. Non solo per continuare a garantire il fabbisogno della produzione agricola, ma anche per soddisfare le esigenze della natura, dell'economia e del consumo umano. Uno degli approcciclassici per raggiungere questo obiettivo è l'uso di sensori dell‘umidità del suolo. Nel caso di piante con radici profonde, tuttavia, tali strumenti sonolimitati nella loro efficacia, poiché di solito fornisco-

no solo informazioni sullo stato idrico degli strati più superficiali del suolo. In questi casi, sensori applicati direttamente alle piante, come il sensore sviluppato dal centro di Sperimentazione Laimburg “FylloClip”, potrebberorappresentare un’utile alternativa.
Le foglie sono indicatori affidabili dello stato idrico di una pianta
Gli stomi presenti sulle foglie di una pianta regolano gli scambi gassosi con l‘ambiente e controllano così l'assorbimento di CO2 e il rilascio di vapore acqueo. Una pianta sufficientemente rifornita d'acquaapre gli stomi finché espostaalla luce del sole, consentendo così la traspirazione.
In condizioni di siccità, invece, gli stomi si chiudono in anticipo nel corso della giornata, per evitare un'eccessiva perdita di acqua. Questo comportamento può essere utilizzato come utile indicatore dell'inizio di una condizione di stress idrico.

Un principio di misura semplice permette il monitoraggio continuo
Il sensore "FylloClip" di nuova concezione viene posizionato sulla foglia di una pianta come una graffetta Quando la foglia traspira, rilasciando vapore acqueo dagli stomi, questo si condensa sul disco sul lato inferiore della foglia, formando piccole gocce d'acqua che vengono percepite dal sistema. Allo stesso tempo, viene misurata la radiazione solare sullato superiore della foglia.
Confrontando l'andamento giornaliero della radiazione solare e della traspirazione, si possono trarre conclusioni sullo stato idrico della pianta: un andamento giornaliero costantemente parallelo delle due linee indica un approvvigionamento idrico sufficiente, mentre un calo precoce della traspirazione rispetto alla radiazione solare è un chiaro sintomo dell'inizio di una situazione di stress idrico.

Il sensore fogliare "FylloClip" è già stato sperimentato su piante in vaso e in campo. I test condotti su diverse specie vegetali sono stati finora prevalentemente positivi Il settore della viticoltura sta mostrando un particolare interesse verso questo dispositivo innovativo e a basso costo, ma anche le primeesperienze condotte su altre colture perenni, come il castagno, indicano interessanti prospettive di applicazione.
2.5.3

Corretta densità di impianto in fragolicoltura: fondamentale per ottimizzare il profitto dell’azienda agricola
Sebastian Soppelsa, Michael Gasser, Massimo Zago
Gruppo di lavoro Piccoli Frutti e Drupacee
Resa e qualità: densità d’impianto a confronto
Dalle valutazioni èemerso che la biomassa delle piante coltivate in bassa densità eraaumentata del 50% alla fine del primo anno edera addiritturaraddoppiata nel secondo anno (Fig 2) Le piante coltivate in alta densità producevano un numero di fioriinferioree frutti più piccoli (Fig 3) Sebbene impianti a densità media e bassa abbiano avuto una resa migliore, le rese ad ettaro maggiori si
sono raggiunte nelle coltivazioni ad alta densità (con 90.000 e 100.000 piante/ha, Fig. 4). Bisognaanche tenere conto dei costi, soprattutto per il materiale d'impianto, la manodopera e la raccolta, che sono più elevati con un'alta densità d'impianto rispetto alle altre varianti In termini di qualità, i frutti provenienti dalla bassa densità di impianto presentano una colorazione più rossa, rispetto ai frutti provenienti da piante in alta densità.
Ottimizzare la redditività in fragolicoltura è una sfida ricorrente per poter sopravvivere in un ambiente altamente competitivo. In questo contesto, la densità di impianto gioca un ruolo decisivo
L'obiettivo di una prova sperimentale durata due anni è stato quello di analizzare l'influenza della densità di impianto sulla crescita e sulla resa delle piante e valutarne, quindi, il profitto finale. A tal fine, nel campo sperimentale in Val Martello (1.361 m s.l.m.) sono state messe a dimora piante di fragola della varietà Elsanta su un terreno baulato con cinque diverse densità di impianto (30.000, 45.000, 60.000, 90.000 e 100.000 piante per ettaro). I rilievi sono stati effettuati per due anni consecutivi sia da un punto di vistaagronomico cheeconomico (Fig. 1).

Conclusioni
Scegliendo la giusta densità di impianto, è possibile aumentare le rese e ottimizzare il profitto.
Le seguenti indicazioni si basano sui risultati della prova:
• Non si dovrebbe superare una densità di impianto di 100.000 piante/ha, poiché ciò comporta svantaggi di tipo economico.
• È consigliabile scegliere densità di impianto basse o medie per favorire una coltivazione della fragola più sostenibile (con la diminuzione della
densità di impianto si è osservata una minor suscettibilità all'oidio).
• Con basse densità di impianto, i tempi di raccolta devono essere pianificati con attenzione per evitare un'alta percentuale di fruttitroppo maturi a causa di una maturazione più rapida.
• Un basso numero di piante riduce i costi complessivi, ma può aumentare il rischio imprenditoriale, ad esempio attraverso perdite di piante dovute a marciume del rizoma e delle radici o perdite di produzione dovute all'antonomo della fragola Anthonomus rubi
In sintesi,i nostririsultatiindicano che una densità di impianto media garantisce un buon sviluppo delle piante, una resa e quindi un ricavo economico soddisfacente e, non meno importante, si va maggiormente nella direzione della sostenibilità.


la presenza del parassita Metcalfa pruinosa nei meleti in Alto
Stefanie Fischnaller, Angelika Gruber, Manfred Wolf Gruppo di lavoro Entomologia
Metcalfa pruinosa è un insetto dannoso (Fig.1) originario del Nord America, cheè stato individuato per la prima volta in Europa nel 1979 Questa cicalina infesta oltre 300 piante ospiti, prediligendo quellelegnose come il melo. Indebolisce le piante succhiandonelalinfa e provocando una curva-

tura nelle foglie. Le cere e la melata secrete da questo insetto possono essere colonizzate dalla muffafuligginosa, causando perdite di qualità in viticoltura e frutticoltura. Inoltre, questo insetto può trasmettere il batterio Pseudomonassyringae pv Actinidiae, associato a varie fitoplasmosi A causa della suaalta mobilità, della polifagia e della protezione cerosa dei giovani, Metcalfa pruinosa è difficile da gestire con i metodi fitosanitari
convenzionali. I nemici naturali in Europa sisono dimostrati poco efficaci nelle aree di recente colonizzazione. Nel 1987 in Italia è stato avviato un protocollo di controllo biologico, introducendo un parassitoide nemico naturalenelle aree di origine, la piccola vespa Neodryinus typhlocybae Dopo essere stati utilizzati con successo in varie regioniitaliane, tra cui l'Alto Adige, i metodi di rilascio con-
trollato sono stati applicati anche in altri Paesi europei.
Presenza in Alto Adige Studi sulla presenza di cicalinenei meleti dell'Alto Adige dal 2014 al 2016 hanno mostrato che la presenza di M. pruinosa era solo sporadica rispetto adaltre specie nei meleti studiati. Tuttavia, recentemente è statoosservato un aumento della densità di popolazione su melo in alcune aree, soprattutto nelle zone limitrofe ai meleti. Per questo motivo, nel 2023 sono state condotte indagini preliminariin alcuni meleti locali perraccogliere informazioni sulle piante ospiti e ottenere i primi dati sulla parassitizzazione delleninfe di M. pruinosa da parte di N. typhlocybae.
Ospiti riproduttivi e tassi di parassitizzazione
Nell'estate del 2023 sono stati esaminati in laboratorio i germogli dadiverse piante per verificare la colonizzazione delle ninfe di cicalina e laloro eventuale parassitizzazione da parte
della vespa (Fig. 2). Dei 911 germogli esaminati,il 28% è stato colonizzato da M. pruinosa, ma solo l'1% delle ninfe ha mostrato una parassitizzazione. I campioni di melo prelevati in tre diverse località hanno mostrato una colonizzazione dei germogli compresa tra l'11% e il 47%, con un basso tasso di parassitizzazione
In autunno sono stati analizzati altri campioni di diverse specie vegetali in varie località della Bassa Atesina. È stato riscontrato un aumento del numero di ninfe di M. pruinosa su Carpinus, Ailanthus, Fraxinus, Ulmus, Cornus, Viburnum e Malus Ninfe parassitate sono state trovate su Acer, Ulmus e Cornus. Al contrario, non è stata rilevata alcunaninfa parassitata sul melo.
Anche il clima influenza la dinamica di popolazione degli insetti
I cambiamenti dei fattori abiotici, come il clima e la coltivazione, influenzanole dinamiche di popolazione dei parassiti e dei loro nemici naturali

Fig. 2: Colonizzazione di specie vegetali da ninfe di Metcalfa pruinosa e loro tasso di parassitizzazione durante l’estate 2023. 2.5.4
Colonizzazioni di specie che in passato erano considerate "parassiti eccezionali" potrebbero verificarsi più frequentemente in futuro e portare a perdite di qualità in agricoltura. Le indagini locali sulla biologia, la distribuzionee la dinamica di popolazione di M. pruinosa costituiscono la base per una gestione mirata del parassita. Sulla base di queste osservazioni iniziali sono previste indagini mirate nei prossimi anni.

Nemici naturali per il controllo biologico del moscerino dei piccoli frutti
Silvia Schmidt, Peter Neulichedl, Martina Melchiori
Gruppo di lavoro Metodi Biologici di Protezione delle Piante
Il moscerino dei piccoli frutti, Drosophila suzukii, è stato individuato per la prima volta in Alto Adige nel 2010. Da allora è diventato uno dei principali parassiti delle coltivazioni di ciliegie e piccoli frutti. La lotta è difficile e si basa principalmente su trattamentiinsetticidi e costosi impianti con reti antinsetto
Nell'area sua di origine (il sud-est asiatico), il moscerino dei piccoli frutti è regolato da specie parassitoidi: in particolare due specie di microvespe, Leptopilina japonica e Ganaspis brasiliensis,
che parassitizzano lelarve di D. suzukii in maniera più efficace
L'insediamento di antagonisti esotici nelle aree didiffusione del moscerino è auspicabile per ottenere una regolazione a lungo termine del parassita. Il rilascio mirato di queste piccole vespe in condizioni favorevoli dovrebbe consentire loro di moltiplicarsi e diffondersi localmente
Allevamento di massa e rilasci
Dopo averesaminato lo studio sull’analisi del rischio, il Ministero dell'Ambiente ha approvato rilasci mirati di G. brasiliensis per la prima volta nell'agosto 2021 e successivamente anche per gli anni 2022 e 2023. Per il rilascio in Alto Adige, l'insetto utileè stato allevato presso la sede principale del Centro di Sperimentazione Laimburg (Fig 1), oltre che in altre sette località idonee poste a diverse altitudini (da 200 a 1.200 m s.l.m.). Ogni anno sono stati rilasciati 200 individui tre volte a stagione in paesaggi naturali adiacenti ai frutteti (Fig. 2). Prima e dopo i rilasci
sono stati prelevati campioni di frutta infestati da D. suzukii e analizzati in laboratorio per osservare e identificare lo sfarfallamento delle specie di moscerini. I risultati sono stati trasmessi annualmente al Ministero dell'Agricoltura e al Ministero dell'Ambiente.
Microvespe parassitoidi: insediamento e tasso di parassitizzazione
Nei campioni di frutta sono state identificate sette diverse specie di vespe parassitoidi, tra queste le due specie esotiche G. brasiliensis e sorprendentemente L. japonica La specie G. brasiliensis è molto specifica e attacca solo D. suzukii
Alcuni individui di questo antagonista esotico sono stati recuperati da frutta proveniente da cinque siti di rilascio, postiin fondovalle e fino a 1.200 m s.l.m. Tuttavia, sono stati trovatiindividui svernanti di questa specie solo una volta, e solo in fondovalle La microvespa L. japonica preferisce D. suzukii, ma può riprodursi anche su altre specie di moscerini. Essa è stata trovata in tutti i siti (Grafico 1) e ha mostratotassi di parassitizzazione crescenti nel corso
dei tre anni, fino a una media del 20% nel 2023. Durante i rilievi sono state riscontrate anche altre specie utili(L. heterotoma, L. boulardi, Asobara sp., Pachycrepoideus vindemmiae e Trichopria drosophilae), che però sono generalistee quindi il loro potenziale di regolazione del parassita è basso.
Conclusionee Prospettive
L'indagine ha dimostrato che L. japonica sista diffondendo sul territorio e che la specie G. brasiliensis, rilasciata solo di recente, mostra già un potenziale di insediamento. I rilasci e il monitoraggio con campioni di frutta continueranno. Sono in corso studi specifici sulla capacità di svernamento in altitudine Esistono quindi i presupposti per un futuro contenimento delle popolazioni di D. suzukii.

1: L'allevamento della microvespa Ganaspis brasiliensis presso il Centro di Sperimentazione Laimburg.

Nu me ro in di vi dui
An za hl In di vi du en L. japonica L. boulardi L. heterotoma P. vindemmiae Asobara sp. Leptopilina sp. G. brasiliensis
Novale di fiéSludernoValas
Ried Schluderns Flaas TablandEppan Berg Rotwand Ritten
TablàAppiano MontePietrarossa Renon
Yazmid Reyes Domínguez, Andreas Gallmetzer, Christian Springeth Labortaorio di Virologia e Diagnostica
Il Laboratorio di Virologia e Diagnostica è responsabile della diagnosi delle malattie delle piante causate da batteri, virus, viroidi, fitoplasmi e funghi Nel corso del 2023 sono stati analizzati oltre 3.500 campioni di varia provenienza, tra cui campioni provenienti dal Servizio fitosanitario della Provincia di Bolzano, da cooperative frutticole e organizzazioni di produttori, dal Centro di Consulenza per la fruttiviticoltura dell'Alto Adige e da istituzioni private. Inoltre, sono stati analizzati campioni di materiale di propagazione proveniente da coltivazioni di frutta, vino, ortaggi e piante ornamentali nonché da vari progetti di ricerca del Centro di Sperimentazione Laimburg.
Individuato un nuovo patogeno della vite:
Roesleria subterranea
Nell'aprile 2023, nella zona di Bolzano è stata osservata la presenza l'insorgere di viti morenti(Vitis vinifera cv. Lagrein) con internodi atrofizzati, foglie gialle e radici secondarie. Erano presenti anche viti completamente morte. Grazie a test microbiologici e biologici molecolari, è stata individuata per la prima volta in Alto Adige il fungo Roesleria subterranea, che causa il marciume radicale della vite Esso è considerato un patogeno primario della vite e può causare ingenti danni economici,in quanto sopravvive in un'ampia gamma di condizioni ecoclimatiche.
Primo rilevamento di Tobacco Ring Spot Virus (TRSV) su melo in Alto Adige
Un compito importante del Laboratorio di Virologia e Diagnostica è quello di effettuare controlli fitosanitari sul materiale di propagazione del melo: in conformità al Regolamento (UE)
2016/2031 sulle misure di protezione contro gli organismi nocivi alle piante, tutte le piante importate devono rimanere in una stazione di quarantena ed essere testate per i principali patogeni entro un determinato periodo prima di essere commercializzate come materiale di propagazione
A questo scopo, è stato testato un portinnesto importatodal Nord America nelnovembre 2021 per la propagazione. Sono stateeseguite specifiche analisi per individuare la presenza didiversi virus e viroidi latenti. Tutte le analisi hanno dato risultati negativi.
Come previsto dallalegge, la pianta madre innestata è stata mantenuta nella stazione di quarantena dopo
l'importazione fino a maggio 2023 e non ha mostrato sintomi di malattia per tutto il periodo. Durante la seconda ispezione fitosanitaria di routine, questa pianta di melo è risultata positiva al Tobacco Ring Spot Virus TRSV: Il confronto dell’informazione genetica del virus con un database internazionaleha mostrato un’identità del 97,9% con l'isolato TRSV "Budblight". Dopo la chiara identificazione di questo virus, la pianta madre infetta è stata eliminata.
In questo modo sisono evitati possibili effetti sulla propagazione e sulla commercializzazione e si è contenuta la diffusione del virus. Ciò sottolinea l'importanza delle misure preventive e delle risposte rapide per controllare la diffusione delle malattie delle piante.

2.5.4
L'orologio biologico della carpocapsa del melo: uno sguardo ai suoi meccanismi genetici di ibernazione
Christian Oehlmann, Katrin Janik, Gruppo di lavoro Genomica Funzionale
Peter Neulichedl
Gruppo di lavoro Metodi Biologici di Protezione delle Piante
La carpocapsa del melo(Cydia pomonella L.) è un insetto fitofago nocivo molto noto a livello globale in melicoltura. In Alto Adige, le strategie di contenimento della carpocapsasi basano attualmente sulla confusione sessuale con feromoni e il controllo con prodotti fitosanitari Tuttavia, questo insetto provocaancora danni considerevoli a causa delle variazioni annuali nella risposta ai feromoni.
Le larve della carpocapsasvernano in luoghi protetti come la corteccia degli alberi, le foglie o le cassette delle mele. Al termine di questa fase didormienza, chiamata diapausa, lalarva si risveglia e continua il suo sviluppo a pupa e adulto in tempi che variano a seconda delle temperature. Gli adulti si accoppiano e depongono le uova sulle foglie giovani e sulle mele. Le uova si schiudono in una nuova generazione di larve che penetrano nel frutto (fig. 1), dove rimangono protette dai trattamenti (fig. 2).
Il momento in cui la carpocapsa emerge dalla diapausa può influenzare il numero di cicli riproduttivi durante una stagione Quanto più precocemente gliindividui terminano lalorodiapausa, tanto più tempo hannodi sviluppare diverse generazioni e quindi causare maggiori danni.
La terminazione della diapausa è nei geni
In una stretta collaborazione tra il Centro di Sperimentazione Laimburg e l'Istituto Julius-Kühn per la Protezione Biologica delle Piante di Dossenheim (Germania), sono stati condotti esperimenti pluriennali di incrocio tra individui di carpocapsa precoci e tardivi. Attraverso analisi genetiche siamo riusciti a stabilire che i meccanismi per la terminazione della diapausa sono ancorati nei cromosomi sessuali dell’insetto. Inoltre, abbiamoottenuto informazioni su un altro fattore genetico, precedentemente non identificato, che influenza l'inizio dell'attività dopo lo svernamento. Queste conoscenze ci aiuteranno a identificare e sviluppare marcatori geneticicorrelati al risveglio delle carpocapse, consentendo di anticipare questo momento cruciale.
I risultati della nostraricerca sono fondamentali per comprendere i modelli comportamentali di questo insetto in campo. Le prossime tappe mirano a identificare i geni responsabili e a sviluppare test rapidi in grado di prevedere la durata della diapausa in una popolazione di carpocapsa Il nostro obiettivo è quello di incorporare la componente genetica nelle previsioni di fuoriuscita dallo svernamento della carpocapsa, consentendo così prognosi più precise sulla prima comparsa in determinate aree.


Daniela Hey, Peter Robatscher, Laboratorio per Aromi e Metaboliti
Gli “small RNA”, ovvero piccole molecole di RNA, sono composti onnipresenti in frutta e verdura che manifestano proprietà benefiche per la salute umana, come il loro potenziale antinfiammatorio e antivirale. Il progetto puRipiaNtA mira a sviluppare un nuovo metodo per ottenere small RNA puri dagli estratti di frutta e verdura al fine di creare un nuovo ingrediente salutare per la dieta umana.
Come separare gli small RNA da altre molecole delle piante
La cromatografia è un metodo molto selettivo per separare composti di origine vegetale con proprietà chimico-fisiche determinate.
Nel corso del progetto, è stata individuata una resina cromatografica che interagisce specificamente con gli small RNA senza legare altre molecole, come per esempio coloranti, zuccheri ed acidi, presenti in un estratto vegetale. I campioni di estratti ricco di small RNA sono stati preparati dall’azienda altoatesina Mirnagreen. Sono state ottimizzate le condizioni per ottenere small RNA puri in conformità con gli standard alimentari, evitando l'uso di solventi organici tossici e l’aggiunta di additivi incompatibili con il consumo alimentare (Fig. 1).
Inoltre, il processo è stato adattato alle esigenze della produzione alimentare, passando dalle quantità analitiche di small RNA ai livelli di produzione semi-industriali Questo adeguamento ha comportato la transizione da un flusso continuo ad una produzione a lotti, facilitandone la gestione

di estratti vegetali ricchiin small RNA.
Un nuovo processo alimentare
Il metodo sviluppato nel corso del progetto puRipiaNtA consente la purificazione di estratti di frutta e verdura ricchiin small RNA, ottenuti mediante un processo brevettato dall'azienda Mirnagreen La purificazione cromatografica degli small RNA apre la possibilità di ottenere questi composti in
quantità semi-industriali per l'industria alimentare, introducendo sul mercato un nuovo ingrediente salutare. Il processo non solo è compatibile con le normative alimentari, utilizzando materiali sicuri, ma è anche applicabile a diverse varietà di frutta e verdura (Fig 2), sfruttando così prodotti agricoli regionali e i loro potenziali sottoprodotti come bucce, torsoli e foglie.

Conclusionee prospettive
Grazie al nuovo processo cromatografico sviluppato per la purificazione di small RNA, è possibile separare questi composti salutari da altri componenti vegetali Partendoda estratti di frutta e verdura, è possibile ottenere small RNA puri in quantità significative, non solo da prodotti agricoli di alta qualità, ma anche dai potenziali sottoprodotti della catena alimentare.
L'obiettivo della ricerca attualeè di implementare il processo cromatografico nella produzione di un ingrediente a base di small RNA per arricchire prodotti alimentari e promuovere così la salute umana (Fig 3).


Nuovi prototipi alimentari da sottoprodotti agricoli perridurre il rischio di insorgenza della sindrome metabolica
Martina Magni, Andrea Pichler, Peter Robatscher Laboratorio per Aromi e Metaboliti
Il progetto REALiSM, in collaborazione con l’aziendaaltoatesina Dr Schär, si è posto come obiettivo la messa a punto di una formulazione alimentare che abbia la potenzialità di diminuire il rischio di insorgenza di Sindrome
Metabolica associataad un aumento significativo dello sviluppo di complicanze cardiovascolari e didiabete di tipo 2. Le caratteristiche principali della formulazione sviluppata sono la presenza di ingredienti funzionali ricchi di nutraceutici di interesse derivanti principalmente da prodotti di scarto della filiera agroalimentare altoatesina, l’apporto di beta-glucani grazie all’impiego di avena e l’elevata appetibilità.
Selezione delle materie prime ricche in nutraceutici
Le materie prime ricche di nutraceutici sono state campionate grazie alla collaborazione di alcune aziende del territorio e del gruppo di lavoro Colture Arativee Piante Aromatiche del Centro di Sperimentazione Laimburg È stato seguito l'andamento della concentrazione dei nutraceutici durante i processi applicati, selezionando le migliori condizioni di essiccazione e macinazione. È stata monitorata la quantità di nutraceutici quali antiossidanti (come i polifenoli presenti in uva, mele e avena), acidi grassi essenziali (apportati dai vinaccioli e dall’avena) e fibre, come i beta-glucani contenuti nell’avena.
È stata fatta una caratterizzazione dei beta-glucani presenti, valutando il peso molecolare che, come è noto da altri studi,influisce sulla loro capacità di moderazione del picco glicemico dopo i pasti. Analisi di laboratorio hanno permesso di identificare le varietà più ricche di beta-glucani con maggior peso molecolare e quindi con un maggioreeffetto positivo sulla salute.
Formulazione di prototipi di prodotti alimentari
In collaborazione con il dipartimento "Nutrition Service" dell’azienda Dr. Schär, si è definito il profilo nutrizionale dei prototipi di prodotti In maggior dettaglio, ciascun prototipo deve contenere sottoprodotti di uva e mela, contenere almeno un grammo di beta-glucani da avena per porzione, fornire gli acidi grassi omega-6 e omega-3 rispettivamente presenti nei vinaccioli dell'uva e nei semi di lino, e senza zuccheri aggiunti, in mododa soddisfare i requisiti stabiliti dall'EFSA, l’Autorità Europea per la Sicurezza Alimentare.
Sulla base di questi requisiti,i ricercatori della Dr. Schär R&D Center hanno formulato prototipi di grissini, biscotti e focaccia, valutandone il profilo antiossidante (Fig.4).
Conclusionee prospettive
L’ottimizzazione dei processi applicati alle materie prime ha permesso la massima conservazione dei nutraceutici fino alla realizzazione di prototipi alimentari La funzionalità dei prototipi è stata infine validata, utilizzando modelli in vitro che simulano il microbiota intestinalee, a livello di attrattività e gusto, con analisi sensoriali e test con i consumatori.


alimentari, dovuta all’aggiunta di sottoprodotti



Fig. 3 Prototipi sviluppati nel progetto: grissini, biscotti e focaccia con sottoprodotti da lavorazione delle mele e vinacce di Lagrein ricchi di polifenoli antiossidanti e avena ricca in beta-glucani.
Potenziale antiossidante
senza aggiuntadi vinacce conaggiuntadi vinacce



Fig. 4: Prototipi sviluppati nel progetto di grissini, biscotti e focaccia con il rispettivo aumento del potenziale antiossidante dovuta all’aggiunta di sottoprodotti da lavorazione di vinacce di Lagrein.
Confronto tra ibridi cavolfiore per valutare
Markus Hauser
Gruppo di lavoro Orticoltura

varietà testate 2023
Seoul F1
Clapton F1, Starline F1
Marmorex F1, Ovindoli F1
Bouchard F1, Jonsson F1
Whiton F1
Moncayo F1 (E 40 W.716 F1), Nebula F1
CRX 13990 F1, CRX 13992 F1, Fulmine F1
Sigurd F1
Alcala F1, EXP 3279 F1
il colore, la granulosità, la compattezza, la peluria dei fiori raccolti.
Il cavolfiore, uno dei tipi di cavolo più apprezzati, occupa una posizione speciale nella coltivazione in di ortaggiin Alto Adige. La costante produzione di qualità, soprattutto in Val Venosta centrale e superiore, fa sì che questo ortaggio sia ben presente nell'assortimento dei mercati freschiitaliani durante i mesi estivi. I cavolfiori vengono piantati da fine marzo a metà luglio in terreni ricchi di sostanze nutritive. La finestra di raccolta va da giugno a ottobre. La disponibilità di sementi sul mercato è in continua evoluzione, per cui è necessario un continuo confronto varietale per valutare l'idoneità delle varietà di cavolfiore per la nostra zona di coltivazione.
Confronti varietali
Nell'estate del 2023, sono state coltivate in due date di semina diverse, 16 varietà ibride F1 di cavolfiore Sono state piantatetre repliche per varietà in parcelle di 22 m² con 82 piante ciascuna. Durante la raccolta delle varietà di cavolfiore sono stati registrati edesaminati diversi parametri significativi, come la resa, il periodo di vegetazione, la finestra di raccolta nonché
Seoul F1 rimane la varietà raccomandataalla prassi agricola è molto convincente La valutazione della prova conferma l'eccellente idoneità della varietà “Seoul F1”, attualmente raccomandata per la coltivazione agricola nella nostraregione per l'intero periodo di coltivazione che interessa i mercati forniti. In entrambi trapianti la varietà ha ottenuto ottimi risultati sia in termi-
ditta fornitrice
Vilmorin
Syngenta Seeds
Seminis
Rijk Zwaan
Esasem
Enza Zaden
Cora Seeds
Clause
Bejo
ni di resa per ettaro che di peso medio dei fiori. In termini di periodo di vegetazionee finestra di raccolta, questa varietà ha confermato i risultati delle prove degli anni precedenti. Infatti, ha ottenuto ottimi risultati anche nei parametri qualitativi rispetto alle altre 15 varietà testate.
Si può presumere che questa situazione non cambierà nel prossimo futuro, anche se la gamma di nuove varietà disponibili deve essere sempre osservata e continuamente rivista e testata.

2.5.6

Manuel Pramsohler, Alessia Castellan, Angelika Ruele
Gruppo di lavoro Colture Arativee Piante Aromatiche
La coltivazione delle piante aromaticheè considerata una nicchia nell’agricoltura montana altoatesina e può rappresentare un’interessante alternativa di coltivazione per diverse aziende. Una delle specie più coltivate in Alto Adige in questo settore è la menta piperita.
Esistono diverse varietà che tra loro possono variare notevolmente in quanto rendimento e qualità del prodotto finale, così come adattabilità alle condizioni ambientali Pertanto, la scelta della varietàadatta riveste un ruolo decisivo per una coltivazione di successo.
Caratteristiche della menta piperita
Lamenta piperita(Mentha x piperita L.), un ibrido tra la menta romana (Mentha spicata L.) e la menta d’acqua(Mentha aquatica L.), è una pianta erbacea perennee nota per essere particolarmente ricca di oli essenziali Le foglie di menta piperita possono contenerne fino al 5%. I principali componenti dell'olio essenziale di menta piperita sono il mentolo e il mentone.
La quantità e la composizione variano notevolmente a seconda della varietà, dell'origine, del momento della raccolta, delluogo di coltivazione e delle condizioni climatiche. Attualmente in Alto Adige la coltivazione della menta piperita si concentra sulla varietà “Multimentha”, scelta principalmente per la sua resistenza alla malattia nota come ruggine della menta (causata dal fungoPuccinia menthae).
Confronto varietale
Tra il 2021 e il 2023 è stata effettuata una prova di confronto varietale in cui, oltre alla varietà “Multimentha”, sono state testate altre due varietà selezionate in Baviera (“Agnes” e “Proserpina”) per valutare il loro potenziale di coltivazione in Alto Adige. La sperimentazioneè stata condotta presso l'Azienda provinciale Gachhof a Labers/Merano (620 m s.l.m.).
Durante il primo anno di impianto sono stati effettuati due tagli, mentre negli anni successivi ne sono stati eseguititre. Dopo ogni raccolta, il prodotto è stato essiccato in un essiccatore ad una temperatura massima di 35°C
Nel corso dei tre anni sono stati rilevati vari parametri agronomici come altezza delle piante, peso fresco e secco, resa fogliare e percentuale di foglie. Inoltre, sono state condotte analisi del contenuto di olio essenziale e dei suoi componenti principali.
Conclusioni e prospettive Tra le tre varietà testate sono emerse differenze significative diresa, con i valori più elevati ottenuti nel secondo anno di coltivazione (Fig. 2) Le varietà “Proserpina” e “Multimentha” sisono dimostrate mag-
giormente produttive rispetto alla varietà “Agnes”. Per quanto riguarda il contenuto di olio essenziale, sono stati raggiunti valori fino al 4,3 % (Tab. 1), il che indica una buona qualità. Lo studio ha confermato una notevole variazione tra i diversi tagli. Anche
per quanto riguarda il contenuto dei principali componenti nell'olio, il mentolo e il mentone, sono emerse grandidifferenze; questa variabilità verrà approfondita in sperimentazioni successive.
analizzato un campione costituito dalla miscela delle quattro repliche


Lorenza Conterno, Noemi Tocci, Letizia Bernardi
Gruppo di lavoro Fermentazione e Distillazione
Daniel Ortler, Manuel Pramsohler
Gruppo di lavoro Colture Arativee Piante Aromatiche
Christof Sanoll
Laboratorio per Analisi Vino e Bevande
Il tempeh è un alimento a base di legumi fermentati, originariamente a base di semi di soia. È considerato una fonte funzionale sostenibile,eco-
nomica e ricca di proteine, vitamine e composti bioattivi. Il consumo di tempeh è una preziosa fonte di proteine alternativaalla carne. Tuttavia, la produzione tradizionale di questo alimento prevede la decorticazione dei legumi, con conseguente produzione di rifiuti alimentari e dispendio di tempo. Lo studio mirava a sviluppare un processo di produzione di tempeh impiegando legumi interi provenienti da coltivazioni locali, con l’obiettivo di ridurre gli sprechi alimentari.
Preparazione del tempeh e analisi del contenuto in aminacidi
Per la produzione del tempeh sperimentale sono stati utilizzati piselli proteici (Pisum sativum), lupini bianchi (Lupinus albus), lupini blu (Lupinus augustifolius) e fave (Vicia faba), utilizzando la materia prima intera. Nella sperimentazioneè stato confrontato
anche il prodotto ottenuto con gli stessi legumi decorticati (Fig. 1). Per la trasformazione in tempeh sono state inoculate spore del fungo Rhizopus oligosporus, la cui crescita è stata monitorata visivamente. Successivamente sono state studiate la conservazione a freddo, la pastorizzazione e la sterilizzazione dei campioni Infine, è stata condotta l’analisi sulla composizione degli aminoacidi in laboratorio.
La composizione in aminoacididel tempeh L’analisi degli aminoacidi ha consentito di misurare il contenuto di 36 aminoacidi, evidenziando un contenuto di aminoacidi liberi inferiore nel tempeh di legumi interirispetto al tempeh decorticato (Fig 2) Probabilmente a causa della presenza del tegumento, ovvero la buccia esterna dellegume, l’attività delle proteasi fungineè stata espressa in misura minore. Tra i legu-
mi testati,i pisellihanno mostrato la più alta quantità di aminoacidi e il più bassoscarto di tegumento. Ciò suggerisce che potrebbe rappresentare un legume adatto per la produzione di tempeh intero Durante il processo di fermentazioneè stato osservato un aumento del contenuto totale di aminoacidi in tutti i campioni insieme a metaboliti peculiari che si rilevano solo in prodotti fermentati.
Inoltre, lo studio ha mostrato che trattare il cibo con calore (come nella pastorizzazionee sterilizzazione) aiutaa stabilizzare il prodotto, in quanto fermare la rottura delle proteine causata dagli enzimi fungini.
Conclusionee prospettive
Attraverso queste osservazioni è stata evidenziata la possibilità di produrre tempeh con tuttee quattro le varietà di legumi, adatte alla coltivazione in Alto Adige. Con alcune di queste varietà è possibilela produzione anche utilizzando i legumi interi, riducendo quindi la quantità di scarto Per la conservazione è risultata efficace la pastorizzazione, tuttavia per una conferma della durabilità del prodotto sarannonecessarie ulteriori analisi.

2.5.6
2: Analisi delle componenti principali del tempeh fresco prodotto con diverse varietà di legumi per i 36 aminoacidi misurati P: Pisello proteico(Pisum sativum), W: Lupino Bianco(Lupinus albus), B: Lupino Blu (Lupinus augustifolius) e Fava(Vicia faba). D: da legumi decorticati; O: da legumi interi


La Libera Università di Bolzano è stata fondata nel 1997 con una vocazione internazionale e multilingue (tedesco, italiano, inglesee ladino). Inoltre, dispone di cinque Facoltà con un’alta percentuale didocenti (35%) e studenti (17%) provenienti dall'estero che studiano, insegnano e fanno ricerca nei campi delle scienzeeconomiche, naturali, ingegneristiche, sociali, dell’educazione, del design e delle arti. In media sono iscritti 4.100 studenti a più di 30 corsi di laurea e post-laurea.
L’offerta formativa e i progetti di ricerca sono collegati a reti internazionali e interregionali - ad esempio, nell’ambito dell’Euregio, con le Università di Innsbruck e Trento - e si orientano verso elevati standard qualitativi.
L’insegnamento e la ricerca sono organizzati all’interno di cinque facoltà e quattro centri di competenza.


2.6
La Facoltà di Scienze agrarie, ambientali e alimentari esiste dal 2023 La sostenibilità e l'interdisciplinarità sono le basisu cui si fonda la facoltà quando si tratta di risolvere problemi complessi, soprattutto nelle regioni montane, nei settoridella produzione agricola primaria, della produzione e della qualità degli alimenti e delle innovazioni di processo e di prodotto per l'industria. Di conseguenza, nel 2023 la ricerca si è concentrata sullo sviluppo di innovazioni nei settori della produzione primaria, dell'ambiente e della produzione e tecnologia alimentare Il lavoro di ricerca è di base e in parte orientato all'applicazione. Molti progetti sono realizzati in collaborazione conla Provincia e con partner delsettore. Diver-
si esempi sono elencati nella sezione seguente del rapporto.
La Facoltà dispone complessivamente didiversi laboratori in cui un team formato da giovani ricercatori affrontatematiche strategiche, con particolare attenzione alla realtà altoatesina.
L’acquisizione di fondiinterni ed esterni per progetti di ricerca fa registrare dal 01.01.2020 al 31.07.2023 un budget complessivo pari a circa 10 Mio. €. Particolarmente consistenteè la quota proveniente dall’acquisizione di fondi terzi (provinciali, nazionali, europei e ricerca commissionata) pari a circa 8,6 Mio. €. Tale somma distribuita su base annuale rappresenta circa il 30%
dei fondi di ricerca annualmente acquisiti dall’Ateneo.
La Facoltà di Scienze agrarie, ambientali e alimentari in cifre:
• 2 Corsi di laurea di primo livello
• 4 Codi di laurea magistrale
• 2 Programmi di dottorato di ricerca
• Oltre 300 studenti
• 22 professori
• 17 ricercatori

D. Asensio, C. Andreotti, W. Shtai, F. Benyahia, M. Tagliavini, D. Zanotelli
Facoltà di Scienze agrarie, ambientali e alimentari
Gli effetti del cambiamento climatico sono già evidenti in alcuni aspetti importanti della coltura della vite In particolare, l’anticipo delle fasi fenologiche della pianta e dell’epoca di maturazione delle bacche causate
dall’aumento delle temperature medie stagionali sono tra le conseguenze più evidenti delle mutate condizioni climatiche. In aggiunta a quanto appena riportato, il cambiamento climatico è spesso associato all’incremento della frequenza ed intensità di eventi climatici estremi, quali ondate di calore, periodi di siccità, piogge intense, grandinate etc. A questi eventi estremi corrispondono condizioni fisiologiche sfavorevoli per le piante di vite (spesso a causa di stress multipli e contemporanei) che si traducono frequentemente in minore produzione per pianta e decadimento qualitativo delle bacche. Il progetto CLEVAS (Effect of climateextremes on grapevine production in South Tyrol: early detection of abiotic stress and consequences for wine quality, finanziato dalla Provincia Autonoma di Bolzano)
ha permesso di comprendere meglio la fisiologia della vite durante di stress ambientali multipli, causati da temperature eccessive e siccità, nonché di prevedere le conseguenze sulle performance produttive e qualitative delle piante di vite Per il raggiungimento degli obiettivi prefissati, il progetto (frutto di una collaborazione tra Libera Università di Bolzano, Università di Innsbruck, Centro di Ricerca Laimburg e Eurac Research), ha previsto attività di ricerca condotte sia in ambiente controllato che in pieno campo (vigneto).
Per poter meglio comprendere gli effetti singoli e combinati di eccesso di calore e della siccità, è stato condotto un esperimento all’interno delle camere di crescita della struttura terraXcube di Eurac Research dove si è


rossa continua), permettendo a quest’ultime di limitare l’aumento della temperatura fogliare e dunque di mantenere attiva la capacità di assimilazione del carbonio (fotosintesi).
provveduto a simulare condizioni ambientali rappresentative di un’ondata di calore estiva In particolare, piante in vaso della cultivar Sauvignon blanc su SO4, dopo un periodo di acclimatamento di 3 giorni, sono state sottoposte a temperature crescenti fino a raggiungere il limite prefissato di 40°C di temperatura massima giornaliera, poi mantenuta per un periodo continuativo di 5 giorni al termine dei quali la temperatura è tornataai livelli iniziali (Figura 1) Le piante in prova sono state inizialmente suddivise in due gruppi in funzione della disponibilità idrica (irrigate vs non irrigate) al fine di poter distinguere l’effetto della temperatura elevata da quello della carenza idrica, nonché di valutare l’effetto dei due stress combinati. Il principale risultato dell’esperimento è consistito nel fondamentale ruolo della disponibilità idrica per la mitigazione degli effetti dell’ondata di calore. Le piante pienamente irrigate, aumentando significativamente la quantità di acqua traspirata dalle foglie, hanno mantenuto più bassa la temperatura della chioma come risulta chiaramente dalla differente colorazione presente nell’immagine all’infrarosso presa in corrispondenza del picco dell’ondata di calore (Figura 2) L’effetto combinato del calore eccesivo e della carenza idrica ha viceversa causato severe limitazioni nelle condizioni fisiologiche delle piante. In particolare, l’elevate
temperature combinate con la scarsa disponibilità idrica hanno spinto le piante a ridurre le perdite idriche per traspirazione tramite chiusura quasi completa delle aperture stomatiche, determinando quindi una forte limitazione dell’attività di assimilazione del carbonio (fotosintesi) e dunque dell’accrescimento. È quindi stato possibile dimostrare come la possibilità di irrigare le piante in previsione e durante un’ondata di calore rappresenti uno strumento efficace e fondamentale per mitigarne gliimpatti sulle piante di vite.
Una conferma di questo risultato è stata ottenuta anche nel corso della sperimentazione condotta in un vigneto appartenente all’Agenzia Demanio provinciale vicino al lago di Caldaro con due cultivara bacca bianca (Sauvignon blanc e Chardonnay), entrambe innestate sul portinnesto SO4. Nel vigneto è presente dal 2020 una stazione per il monitoraggio in continuo dei flussi di carbonio ed acquaa livello di ecosistema. Seguendo un piano sperimentale a blocchi randomizzati, alcune parcelle del vigneto sono state poste “in asciutta” escludendo il sistema d’irrigazione. Nel corso delle due stagioni oggetto di studio (2021 e 2022) sisono verificati periodi di siccità combinataad elevatetemperature in momenti differenti dell’accrescimento stagionale della
vite In particolare, nel 2021 lo stress combinato idrico-termico ha colpito le piante durante la fase di fine fioritura-allegagione, determinando una riduzione marcata della produttività delle piante non irrigate. Nel 2022 si è invece verificata un’ondata di calore (preceduta da un prolungato periodo senza precipitazioni significative) in corrispondenza dell’invaiatura delle bacche. Le piante non irrigate hanno sviluppato sintomi severi di stress, contraddistinti da ingiallimenti e necrosi fogliari diffuse, che hanno suggerito di intervenire con un’irrigazione di soccorso al fine di evitare la loro morte. È stato inoltre interessante notare come, nonostante le condizioni di stress comune ad entrambe le cultivar, le piante di Chardonnay fossero più tolleranti. La variabilità genetica nella tolleranzaa questotipo di stress sarà una delle misure più importanti di adattamento agli eventi climatici estremi.
In considerazione dell’incremento della frequenza di eventi climatici estremi prevista per il prossimo futuro, appare quindi evidente, anche in funzione dei risultati del presente studio, come la gestione irrigua di precisione deivigneti èe sarà sempre più rilevante per il superamento dei periodi contraddistinti da stress ambientali combinati.
2.6.1
CLASSYFARM per valutare il benessere animale e la biosicurezza nelle aziende lattiero-casearie dell'Alto
T.
Zanon, L. Holighaus, M. Gauly
Facoltà di Scienze agrarie, ambientali e alimentari, Gruppo di ricerca di scienze animali
Contesto dell'indagine
Le sfide che il settore della salute e l'industria agricola e alimentare affrontano sono diventate sempre più complesse nel corso degli anni Il benessere degli animali, l'uso di medicinali veterinari, l'abitazione in cui viene determinata la sicurezza alimentare e la biosicurezza sono interconnessi,
rendendo necessario un approccio integrato per valutare la biosicurezza. Questo è proprio ciò che l'UE sta ora richiedendo a tutti gli Stati membri. Ciò ha portato la Direzione generale della sanità animalee dei farmaci veterinari (DGSA) del Ministerodella Salute (MINSAL) a sviluppare un sistema integrato chiamato Classyfarm, mirato a categorizzare l'agricoltura in base al rischio. Lo scopo della presente indagine era valutare la praticabilità del protocollo di benessere animale del sistema Classyfarm per valutare la situazione attuale dell'allevamento di bovini da latte in Alto Adige. Infine, l'agricoltura montana a conduzione familiareè significativamente diversa da altre aziende agricole italiane La partecipazione diretta al protocollo di benessere animale di Classyfarm non è obbligatoria, ma è una condizione preliminare per l'etichetta di benessere animale SQNBA (Sistema di qualità nazionale per il benessere animale), introdotta obbligatoriamente nel 2023 dal Ministero della Salute Pertanto, la partecipazione è indirettamente obbligatoria per tutti i produttori di alimenti di origine animale. Non c'è una vera scelta.
Risultati e conclusioni
I risultati confermano che la stabulazione fissa rappresenta ancora circa il 70% del sistema di allevamento per bovini da latte in Alto Adige. Un sistema che, dal punto di vista del benessere
animale, è principalmente classificato come critico a causa della limitata libertà di movimento degli animali. Naturalmente, ci sono motivi bennoti per cui questo è il sistema più diffuso nella nostra provincia. Questi includono la dimensione della mandria (media: 14,8 mucche da latte) e la difficile topografia, che in molti casi limita la possibilità di costruire stalle grandi e costose. Indipendentemente dal sistema di allevamento, i risultati mostrano che il 63% degli agricoltori altoatesini permette alle proprie mucche in lattazione di accedere al pascolo per una media di 96 giorni all'anno, e in quasi tutte le aziende i giovani animali (animali tra 6 mesi e il primo parto) e le vacche asciutte hanno accesso al pascolo per una media di 157 giorni e 53 giorni all'anno, rispettivamente. Inoltre, l'uso dei pascoli è più diffuso nelle aziende con stabulazione fissa (69,3%) rispetto a quelle con stabulazione libere (47,3%).
L'accesso regolare a un'areaall'aperto o al pascolo è fondamentale affinché la stabulazione fissasiaaccettato anche in futuro. I risultati dell'analisi mostrano inoltre che alcuni aspetti del protocollo Classyfarm, nella loro forma attuale, in particolare per quanto riguarda la biosicurezza, sono difficilmente applicabili allo scenario produttivo delle piccole aziende agricole montane, poiché non tengono conto dellelimitazioni nella progettazione degli edifici e delle strutture dovute a vincoli topografici ed economiciin
montagna. Un esempio è l'agriturismo, dove gli ospiti hanno l'opportunità di visitare la stalla durante il loro soggiorno senza dover indossare indumenti protettivi o passare attraverso camere didisinfezione La visita alla stalla è ciò che desideriamo, ovvero mostrare e avvicinare le persone all'agricoltura.
Non sononoti casi in cui, a seguito di tali visite, siano sorti problemi sanitari. Un altro esempio è che a causa della mancanza di spazio o della struttura ridotta delle aziende,è difficile realizzare più compartimenti di stalla come stalle di quarantena e sembrano anche nonnecessari. Inoltre, i risultati degliindicatori di benessere animale non offrono una visione differenziata della situazione attuale del benessere animale in un'azienda, poiché secondo il protocollo Classyfarm vengono segnalati solo casi estremi,il che può portare a conclusioni fuorvianti. Soprattutto per quanto riguarda gliindicatori di benessere animale (zoppia, lesioni cutanee, pulizia), le prevalenze secondo il protocollo Classyfarm erano molto inferiori rispetto a quanto osservato in precedenti studi. Inoltre, alcuni valori soglia per determinati indicatori di benessere animale (ad es.
mortalità) dovrebbero essere adattati specificamente per piccole mandrie al fine di evitare informazioni fuorvianti. Ad esempio, secondo il protocollo Classyfarm, il limite di mortalità per le mucche da latte è del 5% Con una dimensione media della mandria in Alto Adige (circa 15 mucche da latte), questo limite sarebbe superato conla morte di un solo animale. Infine, è importante sottolineare che nel contesto del protocollo Classyfarm dovrebbero essere possibili determinate correzioni per compensare alcuni deficit, in particolare per quanto riguarda l'allevamento degli animali (ad es elevata percentuale di stabulazione fissa) e la biosicurezza nelle aziende montane, attraverso misure di gestione specifiche come l'alpeggio e il pascolo praticato frequentemente.
Di conseguenza, gli autori raccomandano vivamente una maggiore considerazione delle peculiarità dell'agricoltura montana e quindi una ulteriore differenziazione del protocollo Classyfarm al fine di evitare risultati errati che potrebbero avere un impatto negativo sulla sopravvivenza elo sviluppo delle piccole aziende agricole montane. Queste ultime sono di fondamentale
importanza in quanto forniscono una vasta gamma di servizi ecosistemici e rappresentano un pilastro importante per l'economia rurale e lo sviluppo nelle aree montane.
Fortunatamente, i rappresentanti delle autorità locali e di varie associazioni si stanno impegnando intensamente per apportareeventuali modifiche a favore di una valutazione pratica delle aziende montane. Auguriamo loro buona fortuna nei negoziati!
2.6.3
E. Corretto, L. Ragionieri, H. Schuler
Facoltà di scienze e agrarie, ambientali e alimentari, gruppo di lavoro: Selvicoltura, Pianificazione ed Ecologia Forestale. Centro di Competenza per la Salute delle Piante
La fitoplasmosi del melo (scopazzi del melo) è una delle malattie più importanti nella coltivazione del melo in Europa. L'agente patogeno della fitopla-
smosi è Candidatus Phytoplasma mali, il quale produce delle proteine che interferiscono con la fotosintesi, con il metabolismo e conla regolazione degli ormoni della pianta ospite. Gli alberi colpiti da questa malattia mostrano sintomi tipicicome la formazione di rami con il tipico aspetto a scopa, foglie laterali ingrandite, arrossamento precoce delle foglie, che portano a clorosi e a frutti di dimensioni ridotte, insapore e privi di una colorazione naturale. Sin dalla sua scoperta negli anni '50, l'unica misura impiegata per limitare la diffusione di questa malattia e le conseguentiingenti perdite economiche per gli agricoltori è la tempestiva eliminazione degli alberi sintomatici.
Come altri fitoplasmi, anche Candidatus Phytoplasma mali è un simbionte obbligato che colonizza sia il floema della pianta che l'emolinfa dell'insetto vettore. Gliinsetti vettori di Candidatus Phytoplasma mali sono due psille: Ca-
copsylla picta e Cacopsylla melanoneura In Europa, la loro distribuzione così come laloro efficacia come vettore varia nelle diverse regioni geografiche. Nelle aree dove è presente Cacopsylla picta, questa è il principale vettore del fitoplasma. Al contrario, Cacopsylla melanoneura è ampiamente diffusa in Europa e la sua efficacia nel trasmettere il fitoplasma può variare notevolmente tra le diverse regioni. Ad esempio, le popolazioni di Cacopsylla melanoneura in Germania e in nord Italia non sono considerate vettori o trasmettono solo in misura molto limitata i fitoplasmi,invece questa è il principale vettore nell’Italia nord-occidentale. Pertanto, si ipotizza che l'esistenza di diversi genotipi o specie criptiche influenzi le differenze osservate nell'efficacia di trasmissione dei fitoplasmi Inoltre, le due specie presentano un'altra differenza significativa nella loro biologia: sebbene gli adulti di entrambe le specie svernino su conifere e migrino sulle piante ospiti perriprodursi all'ini-
2.6.3

Figura 1.Panoramica dei siti di campionamento in Europa Germania: Meckenheim (Mela, DE19), Ilbesheim (Mela, DE25), Winden (Mela, DE27), Neustadt an der Weinstraße (Biancospino, DE23); Austria: Vienna (Mela, AT13_1; Biancospino, AT13_2), Pressbaum (Mela, AT3_1), Thalber-Siedung (Mela, AT14), Neulengbach (Biancospino, AT5_1), Stiria (Biancospino, AT19); Repubblica Ceca: Brno (Biancospino, CZ); Romania: Bucarest (Biancospino, RO); Italia: Aosta (Mela), Saint-Pierre (Mela), Champagne (Biancospino), San Michele all'Adige (Mela), Laimburg (Mela), Bolzano (Mela), Barbiano (Mela), Bressanone (Mela), Gargazzone (Mela), Lana (Biancospino), San Pancrazio (Mela), Tirolo (Mela), Sluderno (Mela). Gli indicatori in arancio si riferiscono a popolazioni di alberi di mele, gliindicatori in blu popolazioni di biancospino.
zio della primavera, Cacopsylla picta si riproduceesclusivamente sugli alberi di melo, Cacopsylla melanoneura può riprodursisia sul melo che sul biancospino. Esperimenti di laboratorio suggeriscono che le popolazioni che si riproducono sul melo sono ecologicamente diverse da quelle che usano il biancospino, ovvero le popolazioni adattate al melonon possono sopravvivere né riprodursisul biancospino e viceversa. Tuttavia, al momento sono disponibili poche informazioni sulle differenze genetiche tra queste due popolazioni.
Al giorno d’oggi le identificazioni tassonomiche degli insetti mediante l'uso di chiavi morfologiche vengono supportate dall'utilizzo di strumenti di biologia molecolare Ad esempio, l'analisi di un frammento di un gene mitocondriale (la subunità I della citocromoossidasi - COI) consente di distinguere diversi generi e specie di insetti. Con l'aiuto di questa tecnica chiamata "DNA Barcoding", è possibile
distinguere anche diverse specie di Cacopsylla Inoltre, all'interno di una specieè possibile determinare specifiche varianti genetiche (dette aplotipi) che consentono di valutare la diversità genetica di questi insetti. In questo progetto, abbiamo esaminato la diversità genetica di Cacopsylla melanoneura in Sudtirolo, Valle d’Aosta e altre regioni Europee. Da un lato, volevamo verificare se le popolazioni della Valle d'Aosta sono geneticamente diverse da quelle di regioniin cui questi insetti hanno una scarsa importanza per la trasmissione dei fitoplasmi come ad esempio in Sudtirolo. Dall'altro lato, volevamo determinare se le popolazioni che si riproducono sul biancospino sono geneticamente diverse da quelle del melo.
Abbiamo caratterizzato geneticamente un totale di 283 individui provenienti da diverse regioni d’Europa. In totale 17 popolazioni provenienti da frutteti di mele di cui due popolazioni provenienti da Aosta (dove Ca-
copsylla melanoneura è considerato un vettore), otto popolazioni provenienti dall'Sudtirolo, una dal Trentino, tre dall'Austria e infine tre dalla Germania. Inoltre, abbiamo caratterizzato geneticamente un totale di otto popolazioni di biancospino, una popolazione proveniente da Aosta, una da Sudtirolo (Lana), tre dall'Austria, una dalla Germania, una dalla Repubblica Ceca e una dalla Romania (Vedi Figura 1) I campioni sono stati raccolti con l'aiuto di partner locali (Beratungsring, Laimburg e Fondazione Edmund Mach), nonché da colleghi di istituti di ricerca nazionali e internazionali (Università di Torino, RLP Agroscience, Boku Wien, Masaryk University Brno, Research & Development Institute for Plant Protection Bukarest). Dei 283 individui analizzati, abbiamo identificato 33 diverse varianti genetiche (aplotipi), di cui solo cinque erano già state descritte in precedenza.
Tra gliindividui di Cacopsylla melanoneura trovati sugli alberi di melo,
l'aplotipo gt01 è il più comune in tutti i siti. Le popolazioni che usano il melo come ospite in Italia presentavano un numero maggiore di aplotipi rispetto a quelle in Germania e Austria. La maggior parte degli aplotipi è stata trovata solo in un numero limitato di individui in diversi siti, senza differenze significative tra le regioni. Di conseguenza, non è stato possibile individuare differenze significative tra popolazioni ad alta e bassa efficienza vettoriale.
Al contrario, le popolazioni di biancospino mostravano una maggiore diversità genetica e variabilità tra le diverse regioni piuttosto che all’interno delle stesse popolazioni. In particolare, le due popolazioniitaliane presentavano un numero maggiore di aplotipi rispetto agli altri paesi. Anche negliinsetti raccolti su piante di biancospino, l'aplotipo gt01 era il più comune in Italia e in Germania.
Tuttavia, le popolazioni di biancospino in Austria, Repubblica Ceca e Romania presentavano aplotipi molto diversi
rispetto a Italia e Germania. Queste sequenze si distinguono per un alto numero di mutazioni rispetto agli aplotipi già descritti. Questa scoperta suggerisceche Cacopsylla melanoneura in queste aree potrebbe essere una specie criptica e pertanto necessita di essere studiata in maniera più approfondita in futuro.
Nel presente studio abbiamo dimostrato che l'uso di un singolo gene (COI) è uno strumento prezioso per un rapido screening genetico e può essere utilizzato per distinguere diverse specie di Cacospylla Tuttavia, nonha una risoluzione sufficiente per identificare caratteristiche specifiche legate siaa una maggiore competenza nella diffusione delle fitoplasma del melo o alla preferenza per una determinata pianta ospite.
Per determinare da cosa è influenzata l'efficienza nella trasmissione dei fitoplasmi in popolazioni geneticamente diverse in Valle d'Aosta e in altre regioni e se le popolazioni che si trova-
no su piante di melo e biancospino rappresentino popolazioni geneticamente diverse (e quindi abbiano una rilevanza diversa come vettori di fitoplasmi nella coltivazione delle mele), utilizzeremo metodi più accurati per analizzare il materiale genetico degli insetti vettore nei prossimi studi. I recenti progressi nel sequenziamento del DNA consentono di caratterizzare l'intero genoma degliinsetti, permettendo un confronto preciso delle informazioni genetiche degliinsetti vettore.
Queste informazioni possono essere utilizzate per sviluppare nuovi marcatori genetici per un accurato monitoraggio della presenza di insetti vettori sul campo.
2.6.4
Differenze di sostenibilità tra aziende agricole con e senza alloggio per gli ospiti – uno studio empirico a lungo termine
G.Grillini 1), G. Sacchi 1), C. Fischer 1), T. Streifeneder 2)
1) Libera Università di Bolzano, 2) Eurac Research Bozen-Bolzano
In che modo le attività agrituristiche modificano un'azienda agricola? In che modo le attività agrituristiche influiscono sulle attività di produzione agricola tradizionali (produzione vegetale/
allevamento) delle aziende agricole?
Le aziende agricole con alloggio per gli ospiti sono dimostrabilmente più sostenibili (economicamente,ecologicamente, socialmente) di quelle senza attivitàturistiche?
LaLibera Università di Bolzano e Eurac Research, in collaborazione con l'Università di Innsbruck (Centro di Ricerca sull'Agricoltura di Montagna), stanno indagando su queste domande nell'ambito di uno studio empirico a lungo termine.
Obiettivi e metodologia di ricerca
1. Indagine teorica e descrizione delle possibili differenze di sostenibilità tra aziende agricole con e senzaalloggio per gli ospiti sulla base di un'analisi sistematica dellaletteratura scientifica esistente.
2. Quantificazione empirica delle differenze di sostenibilità sulla base di dati empirici raccolti nell'ambito di un'indagine su aziende agricole con
e senzaalloggio per gli ospiti in Alto Adige, Trentino e Tirolo.
3. Derivare conclusioni sulla sostenibilità degli agriturismi sulla base delle conoscenze acquisite.
Dal punto di vista metodologico, vengono utilizzate procedure statistiche economiche per analizzare le serie di datitrasversali e longitudinali (dati panel) ottenuti.
In particolare, si tratta di confrontare le aziende agricole dotate di alloggi per gli ospiti (gruppo di "trattamento") con quelle che ne sono prive (gruppo di controllo) utilizzando metodidi "Propensity Score Matching and Weighting" per quantificare gli effetti del "trattamento".
Nell'osservazione dello sviluppo longitudinale attraverso varie ondate di indagine (una ogni tre-cinque anni per un periododi 10-15 anni), vengono effettuate analisi econometriche longitudinali/panel con i dati aziendali ottenuti per quantificare gli effetti delle attività agrituristiche sulla performance di sostenibilità dell'azienda. 2.6.4
Primi risultati
La prima ondata dell'indagine è stata condotta nella primavera del 2022. Un totale di 3.750 aziende agricole sono state contattate via e-mail 493 aziende agricole (229 con alloggio per gli ospiti e 264 senza) hanno accettato di partecipare allo studio a lungo termine e hanno risposto in modo esauriente alle domande. Le analisi mostrano che l'insieme dei dati ottenuti è ampiamente rappresentativo in termini di tipologie di aziende agricole, categorie didimensioni, distribuzione regionalee altre caratteristiche socio-demografiche
I risultati statistici mostrano cheesistono differenze significative in diverse variabili di sostenibilità in modo controllato. Tuttavia, tali differenze possono essere osservate solonelle dimensioni della sostenibilità socialee ambientale
Misurata in termini di crescita del reddito e degliinvestimenti, l'ipotesi che
Dimensione economica
Finanziario
Reddito agricolo
Investimenti in fabbricatie attrezzature aziendali (ad es. appartamenti pergli ospiti, saune)
Produzione agricola
Quantità
qualità
Metododi produzione (biologico, ecc.)
Dimensione sociale
Dimensione ambientale
La vitafamiliare
nelle fattorie
Benessere animalee impatto ambientale
Numeroe gestionedegli animali da allevamento
Usodipesticidi
Soddisfazione dei membri della famiglia
Tensioni/ Conflitti
Opportunità di lavoro per le donne
Relazioni con i villaggi e i quartieri
Frequenza di interazione
Qualitàdell' interazione
le aziende agricole con servizi per gli ospiti siano più sostenibili dal punto di vista economico rispetto a quelle senza servizi può essererespinta Tuttavia, il volume della produzione agricola diminuisce significativamente nelle aziende con servizi per gli ospiti. Differenze significative si osservano anche nella dimensione della sostenibilità sociale. Ad esempio, il tempo libero disponibile per la famiglia nelle aziende UaB è inferiore, ma le opportunità di lavoro in azienda sono decisamente migliori per le agricoltrici Allo stesso tempo, diminuisce l'intensità dell'interazione con la comunità del villaggio. Per quanto riguarda la dimensione ambientale, si registrano differenze stabili-significative per quanto riguarda l'aumento dell'uso di metodidi produzione biologici/ecologici, l'uso più frequente di energie rinnovabili e il miglioramento dello smaltimento dei rifiuti (riciclaggio) nelle aziende agricole UaB.
DI risultati della prima ondata di indagine mostrano le differenze di sostenibilità descritte tra le aziende agricole con e senza servizi per gli ospiti. Questi risultati trasversali dovranno essere confermati dalle analisi longitudinali previste per i prossimi anni, non appena saranno effettuate altre indagini.
Grillini G., Sacchi G., Streifeneder T., Fischer C. (2023) Differenze nei risultati della sostenibilità traaziende agrituristiche e non agrituristiche sulla base di una robusta evidenza empirica della regione montana del Tirolo/Trentino. Journal of Rural Studies, Vol. 104, 103152. https:// doi.org/10.1016/j.jrurstud.2023.103152

A. Polo, T. A. Z. Alabiden, O. Nikoloudaki, R. Di Cagno, M. Gobbetti
Facoltà di scienze e agrarie, ambientali e alimentari, Gruppo di lavoro: Microbiologia degli Alimenti
Un “super” alimento che racchiude i benefici della dieta Mediterranea
La Dieta Mediterranea (MD) ha un impattotangibile sulla salute umana, ma l’accesso a questa abitudine alimentare considerata virtuosa è difficile per una parte considerevole della popolazione. Lasfida è quindi quella di estendere quanto piú possibile l´accesso ai benefici di tale dieta,anche alle persone che non possono adottarla. In rispostaa questo obiettivo, e nell´ambito
del progetto di rilevanza nazionale “Microbiome-tailored food products based on typical Mediterranean Diet components” (PRIN), abbiamo selezionato ingredienti (melograno, noci, broccoli e moringa)adalto contenuto di componenti bioattivi tipici della dieta mediterranea e abbiamo progettato e realizzato un (“super-“)alimento in grado di racchiuderli al suo interno. Il suo effetto sul microbiota dell’intestino umano, sulla sua funzionalitá e sulla sua risposta metabolica (aspetti, questi, essenziali per la nostra salute intestinale)è stato esplorato rispetto al placebo, somministrando il super-alimento al simulatore Twin M-SHIME, un modello che riproduce in scala di laboratorio l´intero tratto gastro intestinale umano (Figura 1).
I risultati sono stati promettenti! Abbiamo osservato che la somministrazione del super-alimento ha aumentato l’abbondanza di numerosi gruppi microbici, quasi tutti potenzialmente in grado di esercitare attività benefiche nell´ecosistema intestinale. Per contro, sebbene alcuni gruppi microbici potenzialmente dannosi abbiano aumentato laloro abbondanza con la somministrazione del placebo, essi sono rimasti sotto controllo con l´assunzione del super-alimento. Il rimodel-
lamento del microbiota intestinale si è riflesso anche in una evoluzione della sua potenziale funzionalitá. Abbiamo osservato una maggiore abbondanza di geni responsabili della biosintesi di acido colanico, un metabolita microbico implicato nellalongevità e in un sano invecchiamento. L’abbondanza di geni coinvolti nel metabolismo di L-valina è diminuita, mentre l’assunzione del super-alimento ha aumentato l’abbondanza di geni responsabili del metabolismodei carboidrati e della degradazione delle fibre alimentari. Inoltre, il super-alimento ha temporaneamente aumentato la sintesi di acidi grassi a corta catena (SCFA), utili per il benessere dell´intestino Infine, l´assunzione ha anche modulato la sintesi di composti organici volatili (VOC) nell´intestino, in particolare gli esteri derivati da acidi grassi a catena media e lunga e gli acidi grassi polinsaturi.
Pertanto, il super-alimento che simula una dieta mediterranea ha orchestrato, in scala di laboratorio, cambiamenti positivi nell´ecosistema intestinale, rendendo potenzialmente possibile l’opportunità di accedere ai suoi benefici anche alle persone che non vi aderiscono direttamente.

Ti regalo un fiore? Meglio se di melo! Attraverso la fermentazione diventano una fonte sostenibile di peptidi bioattivi
La fermentazione è uno strumento sempre più strategico per lo sviluppo di nuovi alimenti che promuovonola
salute a partire da substrati vegetali, compresiscarti o sottoprodotti agricoli In quest´ottica, i fiori di melo rappresentano un substrato di enorme potenziale per Alto Adige. Essisono, infatti, ricchi di zuccheri, composti fenolici, glicoproteine, peptidi, amminoacidi e antiossidanti potenzialmen-
te sfruttabili. Per giunta, solo il 7% dei fiori di melo sono preservati per dare frutto, il resto é generalmente rimosso e scartato, connotevole spreco
Gli attuali metodi di smaltimento comportano conseguenti problematiche ecologiche, rendendo fondamentale
2.6.5
trovare usiinnovativi perriciclare i fioriin applicazioni industriali. Nel progetto BIOSUSFOOD (Finanziato dalla Libera Universitá di Bolzano), batteri lattici e lieviti sono stati utilizzati come starter per fermentare i fiori rendendodisponibili (e trasformando) i composti funzionali in essi contenuti (Figura 2)
Gli screening iniziali attraverso analisi microbiologiche e fisico-chimiche hanno mostrato performance superiori quando la fermentazioneè svolta con starter selezionati rispetto a una fermentazione spontanea (cioè senza starter) L'idrolisi enzimatica delle proteine, guidata principalmente dagli starter microbici, ha orchestrato la generazione di nuovi peptidi a basso peso molecolare. Gli starter hanno anche indotto modifiche nel profilo fenolico, generando una vasta gamma diderivati metabolici bioattivi, come floretina, quercetina e kaempferolo.
Questi cambiamenti metabolici e in particolare il rilascio di peptidi potenzialmente bioattivi, sono stati associati ad un’elevata efficaciaantifungina contro tre specie di muffe comuni, e ad una significativa attività antiossidante.
I risultati del progetto enfatizzano il potenziale della fermentazione opportunamente guidata con starter microbici selezionati per valorizzare i fiori di melo scartati durante la coltura della pianta, convertendoliin una
2.6.6
Effetti della combinazione della macerazione fermentativa, del congelamento delle uve e della fermentazione malolattica su vini da Schiava

risorsa preziosa: una nuova opportunità per l´industriaalimentare e/o farmaceutica.
E. Longo 1), A. Darnal 1), A.T. Ceci 1), S. Poggesi 1) 2), T. Mimmo 1) 3), E. Boselli 1) 4)
1) Facoltà di Scienze Agrarie, Ambientali ed Alimentari unibz, 2) Food Experience and Sensory Testing Lab, Massey University, New Zealand, 3) Centro di Competenza sulla Salute delle Piante unibz, 4) Centro di Competenza Internazionale sulle Fermentazioni degli Alimenti unibz
Sono stati studiati gli effetti del congelamento delle uve alla vendemmia (-20 °C, per 2 settimane dalla vendemmia) e della fermentazione malolattica (batteri malolattici - Oenococcus oeni - aggiunti in co-inoculo con il lievito -
Saccharomyces cerevisiae) sui profili chimici e cromatici di vini rossi ottenuti da uva Schiava, i cui pigmenti sono caratterizzati da una prevalenza di peonidina-3-glucoside inveceche di malvidina-3-glucoside [1]. I campioni (ottenuti tramite microvinificazioni) sono stati confrontati anche con vini ottenuti mediante un protocollo di vinificazione in bianco. L'obiettivo è stato quello di identificare condizioni specifiche che potessero migliorare la stabilità complessiva del vino, soprattutto in relazione al colore
Il profilo fenolico del vino all'imbottigliamento ha mostrato una differenziazione molto chiara di tutte le tipologie di vini prodotti (Figura 1). Il set didati
comprendeva 111 composti, tutti significativamente influenzati dal congelamentodell'uva, dalla fermentazione malolattica o dallaloro interazione. È interessante notare che l’astilbina (taxifolina-3-ramnoside) risulta fortemente correlata conla macerazione fermentativa, al contrario l'acido trans-glutationilcaftarico (GRP) ne è inversamente correlato. L’acido trans-caftarico è invece anti-correlato alla fermentazione malolattica (co-inoculo). Riguardo al profilo dei composti volatili, gli effetti più evidenti sono stati osservati sui campioni vinificati in bianco: all’imbottigliamento, quando prodotti senza co-inoculo (ovvero solo con fermentazione alcolica), i vini bianchi mostrano una differenza molto marcata nel profilo degli aromi tra quelli ottenuti da uve non congelate rispetto a quelli ottenuti da uve congelate, che non si è osservata invece nénei campioni ottenuti per vinificazione in rosso né nei vini bianchi prodotti con co-inoculo (fermentazione alcolica + malolattica). Le procianidine oligomeriche cicliche nonhanno mostrato differenze significative di concentrazionenel mosto e nel vino dovute a fattori specifici applicati, né differenze significative dovute al trattamento conla bentonite, dimostrando ancora una volta laloro applicabilità comemarcatori varietali [2].
Il congelamento pre-fermentativo delle uve ha favorito una maggiore estrazione dell'antocianina principale peonidina-3-glucoside nel mosto (Figura 2), tuttavia la quantità di antociani totali (tranne la peonidina-3-glucosidee la malvidina-3-glucoside), è risultata infe-
riore nei vini da uve congelate rispetto ai vini di controllo. Inoltre, i vini ottenuti con il co-inoculo di lieviti e batteri lattici hanno mostrato un contenuto di antociani più elevatorispetto ai vini ottenuti senza fermentazione malolattica.
Petunidina-3-(6''-p-coumaroil)-glucoside, peonidina-3-(6''-cis-p-cumaroil)-glucoside e malvidina-3-(6''-trans-p-cumaroil)-glucoside erano fortemente influenzate dall'interazione di congelamento e coinoculo. La peonidina-3-(6"-caffeoil)-glucoside è aumentata nel corso della fermentazione in tutti i campioni, sebbene abbia mostrato un calo tra la fine della fermentazione e l'imbottigliamento del vino La malvidina-3-glucoside ha mostrato una dipendenza completamente diversa dal tempo e dal tipo di vinificazione rispetto alla peonidina-3-glucoside: non ha mostrato differenze per i vini da uve congelate o non congelate,e ha mostrato una diminuzione molto più lenta nel corso della fermentazione rispetto alla peonidina-3-glucoside, o addirittura un aumento relativo
Complessivamente, i vini da uve congelate che hanno subito la fermentazione malolattica accanto alla fermentazione alcolica sono stati quelli con il più alto contenuto peonidina-3-glucoside e malvidina-3-glucoside. Inoltre, per quanto riguarda i parametri colorimetrici, la tinta misurata per via colorimetrica (CIELab, H*) è risultata fortemente correlata con la peonidina-3-glucoside, e la tinta misurata per via spettrofotometrica (N) con l’altro pigmento principale, la malvidina-3-glucoside (Figura 3).
La tinta (N) nei vini rossi ha mostrato una correlazione molto positiva con l'applicazione della fermentazione malolattica, in accordo conl’evoluzione dei pigmenti che avviene durante la maturazione del vino Alcuni pigmenti minori hanno mostratotendenze opposte. Per quanto riguarda i parametri cromatici del vino, a* (rosso/verde), b* (giallo/blu), ΔE* (differenze di colore), C* (croma), ΔH* (differenze di tono) sono risultati correlati al congelamento delle uvee inversamente correlati alla fermentazione malolattica. L* (luminosità) ha invece mostrato valori più elevati nei vini da uve non congelate e con fermentazione malolattica
In sintesi, questo studio offre un esempio di comemicro-vinificazioni condotte in regime controllato possano essere utili per ottenere informazioni preziosesugli effetti di fattori specifici sulla qualità del vino. Questo studio è stato applicato ad un vino dalla bassa intensità cromatica, che beneficerebbe di condizioni di vinificazione in grado di preservarne il colore nel tempo. In generale, il congelamento dell'uva ha portato a una maggiore estrazione di pigmenti, anche se ha causato un tasso più rapidodi perdita di colore durante e dopo la fermentazione.

2.6.6

Figura 2. Contenuto di antocianiin mosti e vini rossi, per tipologia di campione (espressi come concentrazioni medie in mgMvCl.mL-1 - equiv. di malvidina cloruro) Grafico in alto: mosti (barre in rosso) vs vini (barre in viola); grafico in basso: vini da uve congelate (barre in viola) vs vini da uve non congelate (barre in verde). Dp, delfinidina; Cn, cianidina; Pt, petunidina; Pn, peonidina; Mv, malvidina; Glc, glucoside; Ac, acetil; Cum, cumarilato in 2 diversiisomeri.

Figura 3. Biplot PCA (variabili auto-scalate) per i vini rossi all'imbottigliamento, costruito su antociani e parametri colorimetrici. R, vini sottoposti a macerazione fermentativa; NF, vini da uve non congelate; F, vini da uve congelate; Af, vini sottoposti a sola fermentazione alcolica; AMf, vini sottoposti a fermentazione alcolica e malolattica.
Riferimenti
[1] Darnal, A., Poggesi, S., Ceci, A. T., Mimmo, T., Boselli, E., & Longo, E. (2023) Effetto interattivo del congelamento pre-fermentativo delle uve e della fermentazione malolattica sul profilo degli antociani in vini rossi soggetti a instabilità del colore. EFRT, 249(8), 2045-2065
[2] Darnal, A., Poggesi, S., Ceci, A. T., Mimmo, T., Boselli, E., & Longo, E. (2023) Effetti delle pratiche pre-e post-fermentative sui tannini condensati oligomerici ciclici e non ciclici nel vino da uve Schiava. Current Research in Food Science, 6, 100513


2.6.7 Cooperazione transfrontaliera per la valorizzazione di piante alpine fonte di composti bioattivi
G. Ferrentino, M. C. Tenuta, L. Angeli, K. Morozova, M. Scampicchio
Facoltà di Scienze Agrarie, Ambientali e Alimentari
Libera Università di Bolzano
Gli antiossidanti e gli agenti antinfiammatori sono sostanze che, anche a basse concentrazioni, possono ritardare i processi di ossidazionee ridurre gli statiinfiammatori
Gli estratti di piante, utilizzati da secoli per prevenire lo stress ossidativo e mitigare l'infiammazione, rappresentano un complesso di biomolecole il cui profilo fitochimico dipende dal solvente e dalla tecnica estrattiva utilizzata
Il progetto NETTLE, frutto della collaborazione tra la Libera Università di Bolzano, l'Università di Udinee la Fachhochschule Salzburg GmbH, si propone di: (1) raccogliere campioni rappresentativi di oltre 30 piante in diverse aree della regione transfrontaliera; (2) ottenere estratti mediante diversi solventi e tecniche estrattive, sia convenzionali che innovative,

ecocompatibili e sostenibili; (3) determinare il profilo fitochimico degli estratti; e (4) valutare le loro proprietà antiossidanti, antimicrobiche, antinfiammatoriee cicatrizzanti.
L'obiettivo finale è la creazione di un database contenentetutte queste informazioni, fornendo un'impronta digitale delle piante alpine della regione transfrontaliera Questo approccio sperimentale, garantito dalla collaborazione transfrontaliera, dei partner si basasu una sinergia di competenze diversee complementari.
Il progetto è stato finanziato dal Programma Interreg IT-AU 2021-2027, codice progetto ITAT-11-007CUP 153C23001790007.


A. Candotti, E. Tomelleri
Facoltà di scienze e agrarie, ambientali e alimentari, gruppo di lavoro: Selvicoltura, Pianificazione ed Ecologia Forestale.
Negli ultimi decenni si è registrato un aumento significativo della frequenza e della gravità dei disturbi forestali causati da insetti. Questi disturbi, determinati dal cambiamento climatico, hanno portato a una diffusa mortalità degli alberi suscala da locale a globale
Comprendere i meccanismi didifesa e risposta delle specie arboreeè fondamentale per gestire le epidemie di alcuni di questi insetti. Nello specifico, differenziare accuratamente le

risposte della chioma dell’abete rosso agli attacchi di bostrico da altri fattori di stress, come la siccità, èessenziale per identificare da remoto i popolamenti attaccati e definire strategie gestionali di precisione (tagli fitosanitari).
Questo studio - in cooperazione con l’agenzia per i demani provinciali e la ripartizione foreste - si concentra su un esperimento di manipolazione condotto nella foresta del Latemar. L'obiettivo dell'esperimento è quello di individuare gliindicatori iniziali dello stress da siccità e degli attacchi di bostrico a livello di singolo albero
A tal fine, abbiamo impiegato tecniche di monitoraggio continuo, combinando misure fisiologiche e spettroscopia, per osservare la risposta degli abeti alla siccità e all'infestazione da bostrico. L’esperimento include due tipologie di trattamento: l'induzione dello stress da siccità e la simulazione di un attacco iniziale da bostrico Inoltre, sono stati monitorati con gli
stessi metodi alberirealmente attaccati da bostrico.
Il nostro approccio al monitoraggio prevede l'uso di un dispositivo Internet of Things (IoT) in grado di registrare vari parametri ambientali quali la temperatura dell'aria e l'umidità relativa, oltre a parametri ecofisiologici tra cui la crescita radiale, il flusso di linfa e l’assorbimento di luce (Figura 1). Inoltre, abbiamo monitorato regolarmente il contenuto di umidità del suolo. In aggiunta, è stata monitorata la composizione chimica fogliare e le relative proprietà spettrali attraverso un campionamento in chioma con drone (Figura 2)
Analizzando i primi dati raccolti, siamo stati in grado di seguire i cambiamenti nei meccanismi di risposta degli alberi durante la stagione di crescita e didistinguere tra gli effetti delle infestazioni di bostrico e lo stress da siccità In particolare, abbiamo potuto evidenziare una diversa risposta di regolazione traspirativa degli alberi trattati rispetto agli alberi di control-
lo. Oltre a questo, il comportamentotemporale contrastantetra i due gruppi di trattamento e controllonella chimica fogliare e nelle proprietà spettrali ha fornito informazioni preziose per distinguere le dinamiche legate alle due tipologie di stress.
In previsione di un aumento della frequenza dei disturbi abiotici e biotici dovuti al cambiamento climatico, i nostririsultati contribuiscono a una più profonda comprensione delle complesse interazioni tra gli alberi, gliinsetti e il loro ambiente. In ultima analisi, queste conoscenze favoriranno il riconoscimento precoce dei danni da remoto e potranno supportare future strategie di gestione atte a mitigare gliimpatti dei cambiamenti climatici sugli ecosistemi forestali.


Le scuole professionali offrono percorsi di formazione professionale nel settore agricolo e forestale, dell’economia domestica, della frutti-, viti-, orti- e floricoltura e nel settore della trasformazione alimentare e tecnologia agroalimentare.
Ulterioriinformazioni alla pagina web http://www.provincia.bz.it/formazione-lingue/formazione-professionale/
Scuole professionali agricole www.fachschule-fuerstenburg.it www.fachschule-laimburg.it www.fachschule-salern.it www.fachschule-dietenheim.it
Scuola professionale per la frutti-viticoltura e il giardinaggio in lingua italiana www.agraria.fpbz.it

Scuole professionali di economia domestica e agroalimentare www.fachschule-tisens.it www.fachschule-kortsch.it www.fachschule-haslach.it www.fachschule-neumarkt.it www.fachschule-dietenheim.it

2.7.1 Scuola professionale Laimburg
Tecnico della trasformazione agroalimentare, il figlio minore della Scuola professionale provinciale Laimburg, ha raggiunto l‘età maggiore
Quest’autunno inizierà l’ottavo corso per tecnico della trasformazione agroalimentare presso la FS Laimburg, motivo per presentare questo corso collaudato e rivolto a un vasto pubblico.
Il programma di formazione quadriennale a tempo pieno per tecnici della trasformazione agroalimentare è stato pianificato in collaborazione con l’industriaalimentare altoatesina. Il concetto di formazione e i programmi di studio sono stati adattati alle esigenze, con l’obiettivo di avere alla fine delloro percorso formativo diplomati con una buona base tecnica e pratica, che riceveranno poi gli ultimi stimoli nelle aziendee cresceranno così come preziosi dipendenti. Nel frattempo, alcuni diplomati hanno già completato


il programma di formazione quadriennale, compresa la Maturità, e lavorano già da qualche anno. Spesso hanno giàassunto posizioni dirigenzialinelle aziende in determinati settori oppure stanno viaggiando in tutta Europaper corsi di formazione e perfezionamento per portare nuovo know-how alle aziende.
Questo percorso formativo può essere iniziato dopo aver terminato la scuola secondaria di primo grado. Il prerequisito fondamentale per partecipare a questo corso quadriennale è l’interesse per la produzione alimentare in tutti i settori, un segmento in rapida crescita in Alto Adige, oppure l’intenzione di riorganizzare la propria aziendaagricola in futuro in mododa passare da produttore di frutta di alta qualitàa produttore e trasformatore di prodotti, sempredi alta qualità, e migliorare così le prospettive di suc-
cesso della propriaattività professionale.
Fin dall’inizio, oltre a una solida formazione generale, il programma di studi comprende materie tecniche e scientifiche di base come microbiologia, chimica, fisica e scienza dell’alimentazione, nonché coltivazione e produzione agricola Oltre ai contenuti teorici, è prevista una sessione pratica di un’intera giornata a settimana, che si concentra sulla produzione di alimenti o approfondisce le pratiche di coltivazione agricola nella frutticoltura e nella viticoltura. Fin dall’inizio, nelle giornate di lavorazione pratica si producono alimenti che vengono consumati nella mensa scolastica o nella vita scolastica di tuttii giorni E poiché la formazione tecnica linguistica nella seconda lingua straniera è anche una base fondamentale per le aziende, utilizziamo la seconda lingua anche nella
pratica di trasformazione nel corso di tutti gli anni. Un’ora viene dedicata alla discussione di tutto ciò che deve essere discusso durante la pratica in inglese,e un’altra ora viene svolta la stessa attività initaliano Gliinsegnanti della materia specifica sono affiancati dagliinsegnanti di lingue Durante le giornate pratiche di agricoltura si apprendono i lavori più importanti dell’anno, ma non solo, anche la saldatura dell’acciaio inossidabile è una parte importante della formazione pratica, perché questa abilità è particolarmente richiesta dalle aziende. Dopo i primi due anni di formazione di base, il percorso formativo entra nel vivo Il terzo e il quarto anno di formazionehanno inizio con un tirocinio di 4 o 8 settimane in un’azienda di trasformazione alimentare in Italia o all’estero, per esempio in Germania e gli studenti sono liberi di scegliere la direzione da seguire. Che si tratti di un’azienda vinicola o di una distilleria, di un birrificio o di un produttore di spumanti, di un trasformatore di frutta o di latte, di un produttore di prodotti pronti per la ristorazione o di un produttore di cioccolato in Piemonte, gli studenti hanno già scelto molti settori per svolgere il loro tirocinio e ogni anno si aggiungono nuoviinteressi e aziende in cui gli studenti si fanno una prima idea del mondo dellavoro L’unica regola nella scelta delle aziendeè che non possono riguardare due volte lo stessosettore Quando tornano a scuola, gli ultimi due anni del programma sono molto tecnici. Materie come economia aziendale, ingegneria di

processo, tecnologia alimentare, marketing e garanzia della qualità, nonché psicologiaindustriale, costituiscono la base per la qualifica tecnica dopo quattro anni, ma anche la pratica della lavorazioneè al centro dell’attenzione Le esercitazioni pratiche di un’intera giornata o le unità pratiche di una giornata e mezza costituiscono la pietra miliare della settimana scolastica e consentono agli studenti di seguire le complesse fasi di produzione dall’inizio alla fine, sperimentandole non solo dal punto di vista teorico, ma soprattutto pratico. Tutte le aree tecniche che non possono essere apprese per mancanza di strutture, come la produzione di concentrati, la produzione di frutta vaporizzata e congelata, le tecniche speciali di distillazione, vengono insegnate nelle aziende dai tecnici delle rispettive aziende in teoria e, naturalmente, nella pratica interna. Al termine dei quattro anni, gli studenti sostengonol’esame per ottenere il diploma di tecnico della trasformazione agroalimentare. Questo consiste in una parte scritta, un esame oralee un esame pratico. L’esame si basasulla realizzazionee presentazione un prodotto che gli studenti realizzano durante l’ultimo anno scolastico insieme all’azienda di formazione pratica o a un insegnante supervisore, compreso

un compito scritto. È importante che il prodotto realizzato non esista ancora sul mercato in questa forma. Ciò richiede spirito di innovazionee competenza tecnica nella realizzazione;

la cosa forse più bella è che i ragazzi stanno pian piano crescendo e che il loro percorso di formazione degli ultimi anni dà poii suoi frutti.
2.7.1

2.7.2
Scuola professionale per l‘economia domestica e agroalimentare Corcese per l‘agricoltura e le foreste Fürstenburg (con sede a Burgusio)
„Il mondo ha sete perché abbiamo
fame“
Scuola Professionale Corces Ogni anno, il 16 ottobre, si celebra in tutto il mondo la Giornata Mondiale dell’Alimentazione. Questa giornata serve a sensibilizzare sull’importanza di un’alimentazione equilibrata e sulla lotta contro la fame nel mondo. Lo scorso anno, nel 2023, la seconda classe della Scuola Professionale per l’Economia Domestica e Agroalimentare Corces ha lavorato su temi interessanti legati alla preziosa risorsa “acqua” e al suo impatto sull’alimentazione, portando così la Giornata Mondiale dell’Alimentazione al centro dellelezioni di scienza dell’alimentazione, sotto il motto “Il mondo ha sete perché abbiamo fame”.
Durante la giornata del progetto sono stati trattati vari aspetti dell’acqua e del suo ruolo nell’alimentazione. Le studentessesisono impegnate a fondo nello studio delle funzioni dell’acqua nel corpo umano. Hanno appreso che l’acqua è indispensabile per numerose funzioni vitali, come la regolazione della temperatura corporea, il trasporto dei nutrienti e l’eliminazione dei prodotti di scarto del metabolismo.
Un altro argomento interessante e importante è stato il concetto di “acqua virtuale”. Si tratta della quantità di acqua necessaria per la produzione di alimenti. Le studentesse hanno appreso che la produzione di molti alimenti consuma enormi quantità di acqua. Ciò sottolinea l’importanza di un’alimentazione sostenibile. Come esempio, hanno presentato diverse varietà di frutta e verdura, confrontandone il consumo d’acqua durante la presentazione finale, per stimolare la riflessione di tutta la comunità scolastica su questotema.
Un gruppo di studentesse ha sottolineato l’importanza dell’acqua potabile pulita Hanno appreso che molte persone nel mondo nonhanno accesso all’acqua pulita, il che può causare problemi di salute. Le studentesse sono state incoraggiate a impegnarsi per trovare soluzioni per fornire acqua potabile sicura nei paesiin via di sviluppo.
Sono stati discussi anche i vantaggi dell’acqua del rubinetto Le studentesse hanno spiegato che l’acqua del rubinetto non è solo più ecologica rispetto all’acqua in bottiglia, ma anche più economica e altrettanto sicura da bere. Questa conoscenza dovrebbe contribuire a ridurre il consumo di bottiglie di plastica monouso.
Come momento culminante del progetto, un gruppo di studentesse ha preparato un buffet nel corso di ge-

stione della cucina. Sono stati serviti piatti a base di alimenti con un basso consumo d’acqua come tartare di pomodori, crema di pastinaca, hummus e carote saltate. Inoltre,è stato allestito un bar dell’acqua, dove l’acqua è stata offerta in diverse forme aromatizzate, ad esempio con mela

“Casaro/Casara di alpeggio”
e cannella, limone e zenzero, nonché con varieerbe.
Partecipando alla Giornata Mondiale dell’Alimentazione e affrontando i temi dell’acqua e dell’alimentazione, le studentesse hanno acquisito preziose conoscenze sui legami tra alimentazione, risorse idrichee salute

Ora sono meglioinformatee sensibilizzate sulle sfide dell’alimentazione mondiale e possono contribuire a trovare soluzioni per combattere la fame nel mondo, preservando allo stesso tempo le risorse idriche. 2.7.2
Scuola Professionale
Fürstenburg
AIl 14 marzo 2023, la Giunta Provinciale ha approvato la nuova qualifica professionale di Casaro/Casara di alpeggio. Questa qualifica può essere ottenuta tramite il superamento di un esame di certificazione. Possono partecipare all’esame per diventare “Casaro/Casaradi alpeggio” i diplomati del corso “Corso per casari di alpeggio” presso la Scuola Professionale per l’Agricoltura e la Silvicoltura Fürstenburg. In caso di esito positivo, i partecipanti ricevono un certificato valido in tutta Italia e comparabile a livello internazionale.
Il corso impartisce le competenze e le conoscenze definite per questa qualifica professionale. Al centro del corso per casari di alpeggio vi sono l’ottenimento dellatte, la sua conservazionee la trasformazione in prodotti di alta qualità, tipici della regione e della stagione. A ciò si aggiungono conoscenze sulle normative igieniche vigenti, sull’alimentazione ottimale e il mantenimento della salute degli animali, nonchéle basi perrafforzare la capacità di lavorare in team e la gestione del tempo. Queste conoscenze
non sono solo trasmesse teoricamente, ma anche approfondite attraverso esercitazioni pratiche Tre gruppi si formano per lavorare a rotazione su tre stazioni La ripetizione frequente della produzione dei prodotti, in particolare del formaggio di malga, consolida l’apprendimento.
Questi aspetti vengono trattati nelle 110 ore del corso da relatori dell’Associazione dei Casari dell’Alto Adige, dall’autorità forestale, dall’Ufficio per l’economia montana, da veteri-





nari e insegnanti specializzati della Fürstenburg. Tutti i 13 partecipanti al corso per casari di alpeggio hanno partecipato alla prima prova di certificazione “Casaro/Casara di alpeggio”. L’esame scritto e pratico, eseguito davanti a una commissione, attesta le competenze acquisite durante il corso. Nell’ambito dell’esame pratico, ai partecipanti viene assegnato un compito e la maggior parte delle fasi di lavoro deve essere eseguita praticamente. Alcune fasi vengono simulate o descritte oralmente dai partecipanti, spiegando come procederebbero nella pratica. Ad esempio, devono produrre burro da una quantità prestabilita di panna o una cultura da una determinata quantità di latte Vengono valutati il processo e il metodo utilizzati, il rispetto dellenorme igienichee di sicurezza sullavoro e le conoscenze tecniche.
Dodici partecipanti sono riusciti a superare l’esame con successo e a ricevere il certificato di “Casaro/Casara di alpeggio” durante la conferenza annuale dell’apertura dell’alpeggio alla Fürstenburg. Christian Tecini, della Coordinazione per la formazione professionale continua, ha dichiarato di essererimasto particolarmente sorpreso dall’elevata motivazione di tutti i partecipanti, aggiungendo che con questa nuova qualifica, la qualità del corso per casari, esistente da anni, è stata ulteriormente migliorata. Anche Annemarie Kaser, direttrice dell’Associazione dei Casaridell’Alto Adige, si è detta convinta di questa nuova opportunità formativa. “Con la qualifica professionale, viene sottolineata l’importanza dellavoro dei casari e delle casare di alpeggio e laloro responsabilità Inoltre, il corso per casari di alpeggio alla Fürstenburg ha acquisito maggiore valore come corso di certificazione per la qualifica professionale.”
2.7.3
Scuola
professionale per l‘economia
domestica e agroalimentare
Teodone
agricolo
La quarta classe dell’Istituto Professionale Agrario di Dietenheim/Teodoneha approfondito il tema dell’agroecologia nell’ambito di un progetto.
Nell‘ambito di un progetto di quattro giorni, gli alunni dell’Istituto Professionale per l‘agricoltura, l‘economia domestica e l‘alimentazione hanno approfondito il tema dell‘agroecologia. Il progetto è stato suddiviso in varie unità nelle quali i giovani hanno potuto acquisire sia conoscenze teoriche che esperienzepratiche.
Il primo giorno del progetto è stato dedicato all‘introduzione dei concetti di base dell‘agroecologia, lo studio delle interrelazioni tra gli organismi viventi nel paesaggio agricolo. Gli studenti e le studentesse hanno appreso i concetti più importanti e sisono occupati intensamente dei servizi ecosistemici in agricoltura. I punti focali sono stati, ad esempio, l‘influenza dell‘agricoltura sulla sicurezza alimentare, sulla qualità dell‘acqua, sulle funzioni del suolo, sulla diversità genetica o sulla riduzione del rischio di erosione e valanghe. Gli studenti e le studentesse hanno compreso come le pratiche agricole influenzino l‘ambiente e quale ruolo svolga l‘ecologia nella progettazione sostenibile dei sistemi agricoli.
Conferenza del professor Erich Tasser
Il secondo giorno, il professor Erich Tasser dell‘Università di Innsbruck e dell‘EURAC è entrato in classe In qualità di esperto di ecologia del paesaggio, con particolare focus all‘agricoltura di montagna, ha parlato dello sviluppo del paesaggio e del contesto dei cambiamenti nell‘agricoltura. Gli sviluppi dell‘agricoltura e le sfide fu-
ture sono stati discussi in un vivace dibattito Il professor Tasser ha sottolineato lanecessità di promuovere pratiche sostenibili per far fronte a crescenti sfide come il cambiamento climatico e la scarsità di risorse.
Cambiamenti nell’agricoltura in un contesto storico
Gli ultimi due giorni del progetto sono stati dedicati al confronto tra le pratiche agricole del passato e quelle di oggi, con particolare focussull‘Alto Adige. Gli studenti e le studentesse hanno esaminato i cambiamenti avvenuti a partire dal 1850 circa e hanno analizzato il ruolo del turismo e dell‘agricoltura, nonché della produzione agricola e dell‘uso del suolo. Questa unità del progetto ha permesso agli studenti e alle studentesse di tracciare lo sviluppo storico dell’agricoltura e del turismo e di comprendere meglio le tendenze e le sfide attuali.
A metà del XIX secolo, più della metà della popolazione altoatesina lavorava nel settore agricolo e forestale. Oggi le persone che lavorano nell‘agricoltura sono molte meno. In passato, la maggior parte delle aziende agricole eraautosufficiente e produceva quasi tutto il necessario per sopravvivere. Oggi le aziende agricole sisono specializzate in alcuni settori e la diversità dei terreni è diminuita in modo significativo Le ragioni di questo fenomeno sono da ricercare nell‘emergere di nuovi metodi di coltivazione, che hanno portato a un aumento della produzione. Grandi cambiamenti sono stati apportati anche dall‘espansione del sistema dei trasporti, che ha reso possibile l‘importazione e l‘esportazione di prodotti su larga scala. Lameccanizzazionee il miglioramento dei metodi di coltivazione hanno portato a raccolti più abbondanti, ma l‘eccesso di offerta di prodotti ha portato anche a una riduzione del prezzo dei prodotti agricoli. Oggi, la maggior parte delle aziende agricole si dedica all‘agricoltura come attività secondaria. Le aziende agricole a tempo pieno, che traggono il lororeddito principale dall‘agricoltura, sono in netto calo I masi stanno „morendo“, soprattutto nelle zone di montagna, perchénon riescono a tenere il passo con le aziende agricole in posizioni più favorevoli.
Le conoscenze acquisite sono state presentate dagli studenti e dalle
2.7.3


studentessesotto forma di poster scientifici, ponendo particolareenfasi sulla presentazione dei cambiamenti nell‘agricoltura e dei conseguenti effetti sull‘ambientee sulla società. I poster riflettono il lavoro indipendente degli studenti e delle studentesse e dimostrano la loro capacità di presentare argomenti complessi in modo chiaro e comprensibile.
Panoramica dei risultati
I risultati del progetto evidenziano che l‘agricoltura in Alto Adigee non solo è soggetta a continui cambiamenti Gli studenti e le studentesse hanno riconosciuto che le pratiche agricole sostenibili sono essenziali per affrontare le sfide del futuro. L‘analisi storica ha evidenziato che le innovazioni tecnologiche e i cambiamenti sociali hanno plasmato e continueranno a plasmare l‘agricoltura.
Un risultato chiave del progetto è la consapevolezza che l‘integrazione di turismo e agricoltura in Alto Adige porta con sésia opportunità che sfide L‘utilizzo sostenibile dei terreni agricoli richiede approcci innovativi e una stretta collaborazione tra i diversi soggetti interessati.
Il progetto di agroecologia presso l’Istituto Professionale non solo ha permesso agli studenti di approfondire la comprensione delle complesse interrelazioniin agricoltura, ma li ha anche incoraggiati a pensare in modo critico e a sviluppare soluzioni in modo indipendente. Affrontare i temi della sostenibilità e dell‘ecologia èessenziale per la formazione dei futuri agricoltori e contribuisce a superare le sfide dell‘agricoltura.
2.7.4

2.7.4 Scuola professionale per l‘agricoltura edeconomia domestica Salern
La scuola agraria Salern è stata selezionata come scuola pilota per il progetto della Direzione Istruzione e formazione tedesca „Percorsi verso l‘istruzione 2030 - un buon insegnamento nelle scuole inclusive“. La comunità scolastica attribuisce grande importanza a un atteggiamento positivo e apprezzabile nei confronti dei diversi talenti, per questo motivo si intende promuoverli ancora di più entro il 2030.
Martin Unterer, direttore della scuola agraria Salern , illustra in un‘intervista le singole tappe come scuola pilota.
Perché l´Istituto agrario Salern si è candidato al progetto?
Martin Unterer: I giovani sono sempre stati sostenuti nelle loro capacità,
forze e inclinazioni a trovare e seguire la propria strada La scuola Salern cerca di preparare gli studenti al mondo dellavoro nel miglior modo possibile, offrendo un’ampia gamma di attività teoriche e pratiche, progetti, libertà di scelta, relatori esterni specializzati, visite a conferenze, escursioni, stage, insegnamento di sostegno e supporto individuale. Il collegio docenti vede la partecipazione al progetto come un’opportunità unica per avviare un processo di sviluppo della scuola con un supporto professionale.
Dove la comunità scolastica vede le maggiori sfide quando si tratta di raggiungere l’obiettivo di un “buon insegnamento in una scuola inclusiva”?
Martin Unterer: I giovani studenti non sono sempre disposti adassumersi la responsabilità di riflettere sul proprio processo di apprendimento. Le ragioni sono molteplici, ma è proprio per questo motivo che sononecessari nuovi modi per “accompagnare” questi studenti per nuove strade La progettazione dellelezioni deve essere adattata all’ambiente di apprendimento e alle sfide, in modo che i giovani siano chiamati a cooperare da un lato, ma anche a lavorare in modo indipendente nelle fasi delloro sviluppo.
Quali progetti e priorità di sviluppo sono già stati definiti?
Martin Unterer: Negli ultimi anni, l’istituto agrario di Salern ha giàaffrontato il tema della sostenibilità. Nell’ambito di un progetto del FSE è stato installato un pedagogo sociale della scuola Indispensabili sono anche le giornate di progetto, durante le quali gli studenti possono scegliere tra un’ampia gamma di attività, così come le settimane pradi stagee la stretta collaborazione con diversi partner (SBB, OEW, centro tutela consumatori, Forum Prevenzione, associazioni di allevatori, veterinari), che promuovono l’insegnamento in vari modi attraverso lezioni di esperti.
Come si approccia la comunità scolasticaal progetto?
Martin Unterer: Losviluppo del progetto è supervisionato da due esperte di processo dell’Intendenza scolastica tedesca. Il personale docente si riunisce a intervalli regolari in gruppi di apprendimento professionale, se
necessario anche con gli esperti, per lavorare sui vari obiettivi e argomenti. Gli argomenti che i gruppi di apprendimento trattano sono promuovere l’auto-organizzazione degli alunni, l’apprezzamento, l’ottimizzazione dellelezioni pratiche interdisciplinari e la promozione dei talenti. Allo stesso tempo, si è svolto uno scambio con altre scuole pilota, che ha avuto un effetto positivo sullo sviluppo del progetto.
Cosasi aspetta il corpo docenti dal progetto?
Martin Unterer: Un obiettivo fondamentaleè il rafforzamento del corpo docente. L’obiettivo è raggiungere una comprensione standardizzata del buon insegnamento in termini di inclusione. Gli studenti dovrebbero essere supportatiin base alle loro capacità e abilità attraverso un insegnamento orientato alle competenze L’obiettivo è creare una comunità di apprendimento in cui si definiscano e si realizzino progetti comuni e orientati all’azione L’attenzione è rivolta
all’apprendimento piuttosto che all’insegnamento.
In sintesi, si può affermare che le fasi di lavoro intenso sono necessarie per essere una scuola redditizia, innovativa e versatile.

2.7.5
Scuola professionale per l‘economia domestica e agroalimentare Tesimo
La Scuola professionale per l‘economia domestica e agroalimentare Tesimo ha sempre fatto affidamento su un‘efficace alternanza tra “gamba portante e gamba libera” per il suo ulteriore sviluppo. Come nel movimento umano, anche l‘istruzione richiede un‘alternanza equilibrata tra la gamba portante, con una presa salda sul terreno e un senso della realtà per ciò che è fattibile, e la gamba libera nell‘aria, che è desiderosa di sperimentare possibili innovazioni e cambiamenti e rende l‘istruzione dei giovani più sostenibile.
Esempi di buone pratiche Nella vetrina sono presentitreesempi di progetti realizzati con successo, che hanno tutti utilizzato il principio collaudato dello stand-and-play. La scuola e i suoi partner offrono ai giovani la continuità necessaria con condizioni generali affidabili per il pilastro, in modo che i giovani d’altra parte possano esprimere la loro forza produttiva e laloro creatività.
Cooperativa studentesca sulla strada del successo
DLa cooperativa studentesca “hondgmocht & hausgmocht”, fondata nel novembre 2019, ha tenuto duro anche durante il difficile periodo della pandemia per tutti e si è rimessa in moto.Questo è facilmente visibile nelle attività attuali della cooperativa studentesca: biscotti natalizi per le celebrazioni dell’Avvento dell’Associazione Raiffeisen, vari eventi di catering per istituzioni e privati, laboratori di tela cerata e la produzione del Mountain Muesli in collaborazione con l’ex presidente della cooperativa studentesca Marion Unterholzner e il panificio biologico Ultner Brot, che rappresenta un punto di forzaassoluto con molto slancio. Il Muesli di montagna, sviluppato in concomitanza conla fondazione della cooperativa studentesca presso l’istituto professionale di Tesimo dalla prima classe nella materia scienze dellanutrizione, è molto popolare Non c’è da stupirsi, visto che fin dall’inizioil muesli si è concentrato sulla salute e sulla sostenibilità, ma anche il gusto non è stato trascurato. E non dimentichiamo che dal ricavato del Mountain Muesli ne trae vantaggio la cooperativa degli alunni e l’associazione Kinderherz per l’educazione e la salute: gustare cibo sano e fare del bene sono fattori di successo imbattibili

2.7.5

Incontri transfrontalieri con Erasmus+ e scambi di studenti
Da oltre due annile classi della Scuola professionale di economia domestica e agroalimentare di Tesimo partecipano al progetto Erasmus+ “Home - Regional Identity in Europe”.
Questo ha portato a un vivace scambio tra le scuole partner in Germania e in Belgio: le visite reciproche di gruppi di studenti, insegnanti e dirigenti scolastici a Düsseldorf/Mettmann, Eupen/ Belgio orientalee Tesimo/Alto Adige con un programma di lavoro e sociale hanno promosso la comprensione reciproca in tutti i settori
L’Istituto professionale di Tesimo e la Scuola professionale comunale “Alice Bendix” di Monaco di Baviera partecipano da molti anni a un programma di scambio di studenti.
Questo programma ha effetti positivi sia per le scuole che per gli studenti partner perché consolida sottotutti i punti di vista, professionalee personale.
Pollici in su per gli scambi tra giovani didiversi paesi, che lavorano insieme e trascorrono insieme il tempo libero. Alla fine dei progetti, tutti i partecipanti hanno ammesso che non c’è niente di meglio che incontrarsi sul posto. Soprattutto nella nostra epoca dominata dalla tecnologia digitale, le esperienze personali sono particolarmente importanti per gli adolescenti per trovare il proprio atteggiamento nella vita. Senza il correttivo dell’incontro

reale con le personee il mondo, la realtà mediata digitalmente assume un peso eccessivo. Questo ostacola una percezione equilibrata di sé stessi, degli altri e del mondo.
Affrontare la concorrenza: Premio di Economia Domestica del Tirolo intero
Ogni due anni, il Premio di Economia Domestica del Tirolo intero sisvolge in altre sedi scolastiche del nord, dell’est e dell’Alto Adige. Nel 2023 è stata la volta dell’Istituto professionale di economia domestica e nutrizione di Tesimo I 27 partecipanti al concorso, che frequentano tutti la seconda classe di una scuola professionale specializzata in economia domestica, hanno dovuto affrontare compiti complessi in un team transfrontaliero. Secondo la giuria, i partecipanti hanno affrontato la sfida di formare una squadra con giovani precedentemente sconosciuti e hanno superato a pieni voti compiti difficili Tra questi, la stesura di un piano di lavoro con una distribuzione equilibrata dei compiti, la preparazione di un menu di tre portate con ingredienti regionali e stagionali dal carrello della spesa per gli ospiti invitati, oltre a carte del menu e decorazioni per la tavola, l’accoglienza degli ospiti e la presentazione del cibo e delle bevande in

tedesco con partiinitaliano o inglese, nonché un servizio professionale. Una giuria di esperti esterni e interni ha giudicato l’evento dall’inizio alla fine. Il momento clou della giornata è stata la cerimonia di premiazione delle squadre. Oltre a cesti regalo con prodotti regionali, i vincitori hanno ricevuto un tagliere in legno di melo oliato con incisione, disegnato dagli studenti di quarta elementare e realizzato dagli studenti di falegnameria della scuola professionale Luis Zuegg - Merano.
Infine, uno sguardo al 2024: la Scuola professionale di economia domestica e nutrizione di Tesimo guarda con gratitudine agli ultimi decenni di sviluppo della scuola, in cui l’equilibrio tra “la gamba portante e quellalibera” ha sempre giocato un ruolo fondamentale.
La gioia è grande, 1974 - 2024: un brindisi a 50 anni di storia della scuola con tanti auguri per un futuroricco di sviluppipositivi.


Scuola professionale per l‘economia domestica e agroalimentare Egna
In un momento in cui sempre più studenti sono alle prese con problemi accademici, sociali ed emotivi, la scuola professionale per l’economia domestica e agroalimentare die Egnaha trovato una risposta. Per poter offrire unmigliore supporto agli studenti, è stato assunto un’educatrice professionale socio- pedagogica.
e temi specifici. I temi trattati nell’ anno scolastico 2023/2024 sono stati: la motivazione personale, prevenzione alla violenza, prevenzione della dipendenza. Un esempio di collaborazione con il “Forum Prävention”, è stato il workshop sul tema “Consumo e comportamenti a rischio”, offerto a tutti gli studenti. Il focus di questo workshop era sviluppare la fiducia in sestessi e le proprie abilità sociali. Attraverso il dialogo e lo scambio sono state scoperte e rafforzate le risorse personali, soprattutto per quanto riguarda i comportamenti di dipendenza e l’uso di sostanze.
Per coinvolgere attivamente gli studenti sono state utilizzate modalità interattive per attivare le loro risorse individuali. Queste misure mirano a promuovere la resilienza e il benessere e quindi a prevenire i rischi di comportamenti non salutari e di dipendenza.

„Fidarsi cecamente.“
Il compito principale dell’educatriceè di sviluppare vari progetti perrafforzare le competenze sociali e personali degli studenti. Lavora a stretto contatto con espertiinterni edesterni per realizzare progetti di prevenzione orientati a gruppi target
Realizzando questi progetti di prevenzione, non solo si promuove l’apprendimento scolastico, ma si mette al centro anche lo sviluppopersonale e il benessere degli studenti.

“Insieme siamo forti”
D’ora in poi lanostra scuola punterà sempre più sulla formazione sociale al fine di migliorare le competenze sociali degli alunni.
Gli studenti nella durata di tutto l’anno scolastico, prenderanno parte a moduli con tematiche diverse, quali “Cooperazione e lavoro di squadra”, “Autogestione”e “Idoneitàal conflitto”, che gli aiuteranno a rispondere alle esigenze della vita professionalee personale. La formazione sociale aiuta i giovani adadattarsi con successo al mondo lavorativo ed alle esigenze della società. Questa iniziativavuole contribuire alla
formazione di persone con maggiori abilità sociali, con competenze che consentono di interagire in modo positivo conle personee diventare cittadini responsabili e favorendo la coesione sociale in un momento di crescenteeterogeneità sociale e culturale

2.7.7 Scuola professionale di economia domestica e agroalimentare
Aslago
La Scuola professionale per l’economia domestica e agroalimentare Aslago ha festeggiato i 40 anni. In wun commovente gesto di solidarietà e impegno, la scuola professionale per l’economia domestica e agroalimentare Aslago ha organizzato nel dicembre 2023 una splendida serata di beneficenza,anziché una festa di compleanno con torta e coriandoli. Con il motto “Colori. Sapori. Texture”. La scuola professionale ha aperto le sue porte per festeggiare, divertirsi, meravigliarsi e aiutare insieme a 40 invitati Oltre alle delizie culinarie, la serata di beneficenza ha offerto agli ospiti anche l’opportunità di dare qualcosa in cambio.
Grazie alle generose donazioni e al sostegno durante la serata, è stata raccolta la considerevole somma di oltre 5.920 euro, cheè stata devoluta
a “Südtirol hilft” e contribuisce adaiutare le persone che attualmente non vivono il periodo migliore dellaloro vita La serata è iniziata con un caloroso benvenuto da parte della direttrice Gudrun Ladurner e un aperitivo già insolito in una confezione festosa. Le bevande servite in baubles natalizi non solo hanno creato l’atmosfera per il periodo contemplativo prenatalizio, ma hanno anche stupito gli ospiti per la prima volta.
È seguito un menu di 9 portate, che ha rivelato una nuova sfaccettatura di sapore a ogni boccone e ha trasformato la serata in una festa per i sensi. Gli antipasti composti da una varietà di delicate prelibatezze hanno suscitato l’attesa per ciò che sarebbe stato servito. Sono seguite creazioni di pesce, tre tipi di mais, piatti di pastaartistica e prelibatezze vegetariane. Il sorbetto ai fiori di sambuco e limone, avvolto in una bolla di limone, era davvero un’esplosione di sapore e un’attrazione per gli occhi.
Il percorso gastronomico è proseguito con un salmerino all’olio d’oliva e tè verdee la tenerissima sella di cervo. Come pre-dessert sono state servite delle tartelette all’arancia, mela e timo. Il dessert principale ha riunito

la classicacombinazione tra la dolce freschezza dei lamponi e la cremosa seduzione di una tartelletta di mousse al cioccolato, completando perfettamente la serata. Ogni portata, abbinata a vini squisiti e succhi di mela di montagna, è stata curata nei minimi dettagli e ha raccontato una storia. Tra una portata e l’altra, gli ospiti sono stati accompagnati dai suoni delicati del sassofono e della chitarra Le talentuose musiciste Maria e Lydia hanno creato un’atmosfera che ha riempito la sala di eleganza e relax. Evi Keiflha recitatotesti contemplativi e divertenti sul Natale, che hanno fatto riflettere e sorridere.
Il team della scuola professionale Aslago e alcuni volontari hanno trascorso molte ore in piedi nella preparazione dell’evento e hanno lavorato duramente per creare una serata di beneficenza indimenticabile. Con grande passione, impegno e creatività, sono riusciti a incantare i palati, a toccare i cuori e a sostenere una causa meritevole.
La serata di beneficenza organizzata dalla Scuola professionale per l’economia domestica e agroalimentare Aslago è stata senza dubbio un successo a tutti i livelli. Ha riunito un’ampia varietà di persone che condividono la passione per le arti culinariee l’istruzione, rendendo allo stesso tempo possibile un cambiamento positivo attraverso la generosità e l’impegno sociale. Non poteva esserci modo migliore per festeggiare il proprio compleanno!



2.7.8
Scuola professionale provinciale per la fruttiviticoltura e il giardinaggio in lingua italiana –


Partecipazione ad eventi fieristici e visite di istruzione Formative e interessanti le visite ad eventi fieristici di settore come Interpomaa BZ dedicata alla mela e al “Flomart” la fiera internazionale del Florovivaismo, verdee paesaggio, nonché quelle di aziende specializzate del territorio come la “VOG products” per conoscere le lavorazioni secondarie delle mele, e all’aziendaagricola “Vintlerhof” di Bressanone, che integra le attività agricole con aspetti sociali. Non sono mancatii viaggi di istruzione al “Parco natura Viva” di Affi per gli alunni e alunne della I, a Milano per gli alunni e alunne della II e in Toscana per gli alunni e alunne della III.
Come di prassi le settimane di stage sono una preziosa occasione per calarsi appieno nella realtà lavorativa aziendale mettere in pratica le conoscenze acquisitee sviluppare ulteriormente le competenze tecnico applicative. Per quest’anno formativo le tre settimane di Stage per gli alunni e alunne della classe terza si sono svolte interamente in area germanica presso le aziende locali operanti nel comparto agricolo. Gli alunni di seconda invece sono stati accolti da aziende locali di settore e i futuri tecnici del verde, allievi ed allieve della quarta classe, sono stati impegnati per ben otto settimane di stage: 320 ore di pratica in aziende
specializzate situate sia nella Provincia di Bolzano sia in quelle limitrofe.
Interventi sul verde
Gli alunni hanno ripristinato il vivaio della scuola a Laives con circa 650 piante ornamentali, creato un piccolo “orto dei semplici” con essenze aromaticheed officinali, un impianto di piccoli frutti nell’area posteriore della scuola edeffettuato numerosi interventi sul verde che hanno coinvolto gli alunni e alunne, di tutte le classi. Continuano le collaborazioni con il Comune di Vadena e il Comando delle truppe alpine di Bolzano presso i quali gli alunni e le alunnehanno svolte varie attività dalla gestione e manutenzione delle aiuole, all’arieggiatura del prato e pulizia dalle infestanti, alla potatura di siepi, rose e alberature, e gestione del verde urbano. Da quest’anno inoltre, la scuola ha il suo apiario: tre nuovi alveari sono stati posizionanti in prossimità delle aromatiche così che tutti possano seguire le attività di questi infaticabili e indispensabili impollinatori.
Collaborazioni con il demanio Anche quest’anno gli alunni e le alunne della nostra scuola, grazie all’accordo stipulato fra la scuola e l’Agenzia del Demanio Provinciale, sono statiimpegnatiin svariate attività nelle vigne e nei meleti del Demanio così come nella grande e attrezzata serra di Laimburg

In campo sisono cimentatiin potature di meli e viti, campionamento di insetti dannosi, nella vendemmia e raccolta mele connastro e carro raccoglifrutta. Nell’apposito campo hanno simulato e progettato la realizzazione di un impianto di mele mentre nel vigneto presso la scuolahanno posizionato i cavi di contenimento delle viti Gli alunnihanno anche svolto numerose attività presso le ormai consolidate aziende private con le quali collaboriamo. In serra hanno riprodotto piante per taleee semina, trasferite ed utilizzate poi nel vivaio della scuola. Sono iniziate inoltre attività in collaborazione con gli alunni della scuola agraria in lingua tedesca come la produzione di sciroppo di lamponee mirtillo.
Attenzione alla salute e prevenzione
La scuola come ambiente di stimolo per lo sviluppo complessivo della persona, da spazio a svariate iniziative, workshop e incontri a tema divenuti ormai parte integrante del percorso scolastico: il laboratorio esperienziale “Suoni e rumori” finalizzato alla prevenzione didanni all’udito, lo “Sportello all’ascolto” seguito da un counsellor familiare per favorire la comunicazione nel contesto scuola famiglia, gliinterventi supportati da esperti del servizio di Medicina di Base sulla “Educazione all’affettività”, e il seminario sulla “Filiera dell’illegalità e effetti delle sostanze psicotrope illecite e cyberbullismo” tenuto da esperti delle forze dell’ordine. Nell’ambito delle scienze motorie gli alunnihanno inoltre partecipato al progetto di “meditazionee yoga”.


Attenzione all’ambiente
Fra le molte le attività di sensibilizzazione, informazione e formazione attuate nel corso dell’anno formativo: “La vita nell’acqua” esperienza di monitoraggio delle qualità delle acqua realizzata in collaborazione con il Laboratorio Biologico Provinciale, il workshop “La bussola del consumo” e “RedUse” per imparare ad orientarsi come consumatori consapevoliin un’ottica di sostenibilità e i whorkshop “Cambiamento climatico comprendere e agire” e “Prossima uscita: futuro” per meglio comprendere le dinamiche e le opportunità di conciliare la crescita economica con la tutela dell’ambiente.
Formazione continua
Semprericca la proposta della Formazione Continua sul Lavoro, che quest’annoha visto il riproporsi dei consolidati corsi di “Coltivazione, riconoscimento e utilizzo piante aromatichee officinali”, di “Apicoltura e di “Manutentore del verde”. A questi e agli altri corsi professionalizzanti erogati, come il corso motosega, tree climbing, PLE e i corsi propedeutici per sostenere l’esame di “Abilitazione per utilizzatori professionali di prodotti fitosanitari”, anche le relative ore di aggiornamento previste per legge. Molto apprezzati anche i corsi di base, dalla birrificazione di base alla produzione del formaggio.
La produzione alimentare moderna si trovaadaffrontare sfide sempre crescenti. La produzione di prodotti agricoli sostenibili e certificati richiede conoscenze complete e il rispetto di normative dettagliate La legislazione alimentareregola aspetti quali l’igiene degli alimenti, di additivi, i residui, la
tracciabilità, l’etichettatura e la commercializzazione. Queste norme garantisconola sicurezza e la salute dei prodotti, ma pongono il settore agricolo di fronte a compiti complessi e a costi di produzione crescenti.
Nell’ Istituto Tecnico Agrario di Ora, la materia “Trasformazione dei prodotti” insegnaagli studenti la produzione e la trasformazione di vari prodotti del settore agricolo. Questo contenuto viene insegnato in tuttee tre le possibili indirizzi (“Viticoltura ed Enologia” / “Produzionee Trasformazione” / “Gestione Ambiente e Territorio”), che possono essere scelti a partire dal 3° anno

Alunni che vendemmiano le uve per il passito “Aurum”
Oltre a vari tipi di vino, la cantina della scuola produce anche un passito Si tratta di un vino ottenuto da uve Chardonnay, Petit Manseng e Moscato bianco Le uve vengono prima messe in cassette per l’appassimento e lasciate essiccare in un luogo arieggiato per diversi mesi Solo dopo 4 mesi di appassimento gli acini, simili a uva passa, vengono pressati sofficemente e fatti fermentare in vino.
Applicazioni pratiche
Nellelezioni pratiche, gli studenti apprendono l’estrazione delle materie prime e l’analisi della stessa. Si affrontano vari metodi di lavorazionee tecniche di conservazione. Vengono combinati processi biochimici, possibilitàtecnologichee metodi per garantire la qualità.
I prodotti agricoli dell’Happacherhof, cheé l’azienda agricola di proprietà della scuola, svolgono un ruolo centrale. I diversi tipi di frutta vengono trasformati in succhi, marmellate e aceto, l’uva viene trasformata in vino nella cantina e il latte di fieno della stalla a stabulazione libera viene trasformato in yogurt, formaggio e burro. La scuola ampliainoltre la propria gamma di prodotti essiccando e trasformando erbe e vari tipi di verdure.
Teoria e pratica in sintonia
Le unità didattiche pratiche sull’estrazione delle materie prime e sull’analisi degli alimenti combinano i principi teorici con la necessaria conoscenza dei processi biochimici, delle attuali tecnologie di trasformazione e dei vari metodidi controllo qualitativo . Gli studenti non solo apprendono le tecniche di lavorazione, ma familiarizzano anche con gli attuali processi di produzione attraverso lavori di laboratorio e di tipo sperimentale.
Concetto educativo interdisciplinare
Il tema della trasformazione alimentare va oltre gli aspetti puramente tecnici. Incorpora questioniinterdisciplinari come l’ecologizzazione, l’efficienza economica, i principi legali e i requisiti burocratici. Questo concetto educativo prepara gli studenti adaffrontare i complessi compiti dell’industria alimentare.
Stagee cooperazioni
Il tirocinio inserito nel programma scolastico del quarto anno offre agli alunnil’opportunità di familiarizzare con il mondo dellavoro e la realtà del settore alimentare Inoltre, vari progetti e cooperazioni offrono una visione della produzione agricola orientataal futuro Un vivace scambio e trasferimentodi conoscenze con scuole partner sia italiane che straniere amplia gli orizzonti degli studenti.
Apprendimento interconesso a livello europeo
Nel 2023, l’ Istituto Tecnico Agrario ha fatto parte del progettotriennale Erasmus Plus “So is(s)t Europa”, che ha permesso a molti dei nostri studenti di fare viaggi emozionantiin diversi angoli d’Europa I Paesi partecipanti, Austria, Croazia, Repubblica Ceca, Alto Adige (Italia) e Germania, hanno presentato, durante il programma di mobilità di una settimana, piattitradizionali, attrazioni e altre specialità legate al cibo nei loro Paesi d’origine. Non solo hanno impa-
rato a conoscere le caratteristiche culturali degli altri Paesi, ma hanno anche stretto amicizie al di là delle frontiere. L’obiettivo didare ai giovani europei un senso del “noi” è stato quindi più che raggiunto.
Nel complesso, la materia della trasformazione alimentare fornisce non solo ai maturandiinformazioni e fatti sulle materie prime lavorate, ma promuove anche l’applicazione pratica e la comprensione dell’intera filiera di produzione e del suo valore.

Esercizi nell’appezzamento varietale Il centro di formazione dispone di un bellissimo appezzamento per mele e pere Qui crescono oltre 80 varietà e molti cloni diversi. Ci sono varietà antichee varietà attuali. Cerchiamo di mantenere aggiornato frutteto aggiungendo continuamente nuove varietà. Agli alunni vengono così offerte molte opportunità di esercitazione, dallo studio della varietà, test qualitativi e di maturazione. 2.7.9




Test di maturazione su diverse varietà di mele
Gli studenti utilizzano diversi metodi per analizzare il grado di maturazione delle mele. In primo luogo, si utilizza il penetrometro per determinare la consistenza della polpa. Il secondo test vieneeffettuato con un rifrattometro per determinare il contenuto zuccherino delle mele La valutazione del contenuto d’ amido avviene dato che questo si colora di viola. Infine si confronta l’intensità della colorazione con una scala.
Produzione di bevande gassate
Erano disponibili diversiingredienti come arance, mandarini, limoni, zenzero, sciroppo di lampone e sambuco, oltre a erbecomementa e melissa Gli alunni hanno potuto dare libero sfogo alla loro creatività e ideare le proprie ricette mescolando e assaggiando. Ai succhi è stato aggiunto il lievito. La fermentazione alcolica così innescata dona al prodotto grazie alla produzione d’ anidride carbonica una piacevole vivacità
Come si trasforma il latte? Come si produce il formaggio?
Nell’ambito di una giornata progetto sul tema della trasformazione dellatte, gli alunnihanno imparato a conoscere le singole fasi della produzione del formaggio, sia dal punto di vista teorico che pratico, utilizzando un producendo un formaggio a pasta dura La classe ha anche preparato la mozzarella Per questi raffinati prodotti caseari è stato utilizzato il latte fresco delle mucche della azienda Happacherhof.
Progetto trasformazione carne
Il progetto si è svolto presso la scuola professionale regionale per la ristorazione e l’industriaalimentare “Emma Hellenstainer” di Bressanone. Gli studenti hanno imparato a conoscere il processo di macellazionee i processi di stagionatura della carne. Hanno potuto seguire la macellazione professionale di una mezzena di suino edè stato spiegato loro l’uso dei vari tagli della carne.
Nel pomeriggio, gli alunni hanno potuto cimentarsi nella preparazione di due diversi tipi di salsicce.

Due studenti eseguono analisi per determinare il contenuto di zuccheri e acidi del succo di mela OFL.

L’autocritica è d’obbligo
Tavola rotonda di alto livello sul benessere degli animali alla OfL.
Il 18 aprile 2023, il docente universitario Matthias Gauly (veterinario, agronomo, insegna scienze zootecniche presso la Libera Università di Bolzano), Martin M. Lintner (professore di teologia morale e spirituale a Bressanone, membro del Comitato etico provinciale), consigliera Brigitte Foppa, il macellaio biologico Alexander Holzner e l’agronoma Verena Angerer, che si occupa di allevamento di animali da ingrasso a Pfitsch, hanno discusso con gli studenti sul tema del benessere animale. Prima dell’inizio della discussione, nel foyer dell’Aula Magna è stato servito uno spuntino vegano, preparato dagli studenti della Scuola professionale per l’economia domestica e agroalimentare Egna.

sulla
L’obiettivo delle giornatetecniche è quello di mostrare agli alunni le più recenti tecnologie di raccolta e di esercitare in modo intenso eesaustivo la parte pratica – manuale della raccolta delle mele

Microvinificazione
Nell’ambito della microvinificazione, diverse varietà di uva vengono vinificate in piccole partite, il che consente agli studenti di effettuare una serie di esperimenti. L’istitutotecnico dispone di attrezzature moderne con piccoli serbatoi di fermentazione, precisi sistemi di controllo della temperatura e strumenti analitici per monitorare il processo di fermentazionee la qualità del vino. Ciò consente agli studenti di produrre i propri vini in piccoli gruppi in modo molto professionale.

Controllo della qualità delle mele
Durante la valutazione della qualità, gli alunni hanno esaminato vari aspetti delle mele, come la pezzatura, il colore, la consistenza, il sapore e le alterazioni. Hanno imparato a valutare il grado di maturazionee a fare attenzione alla qualità. Grazie a questo attento esame, gli alunni sono stati in grado dideterminare quali mele soddisfacevano gli standard di qualità più elevati. Un’altra parte importante del progetto è stata la quantificazione del danno da grandine Gli scolari hanno così imparato a riconosceree classificare i danni causati dalla grandine, dalle piccole ammaccature ai danni più gravi.




In questaterza parte sono fornite approfondite informazioni sui report delle ripartizioni e degli uffici elencati nella seconda parte, supportati da cifre, dati e fatti. Un quadro delle informazioni contenute si ottiene dall‘indice delle tabellee delle figure.

Indice
Tab. 1Patrimonio zootecnico in Alto Adige 2023
Tab. 2Animali da cacello e vitelli da ingrasso – prezzi medi 2022 e 2023
Tab. 3Interventi di fecondazione artificiale 2021 – 2023
Tab. 4Stazioni di mona 2023
Tab. 5Razze ovinee caprine in Alto Adige 2023
Tab. 6Aste ovini e caprini 2023
Tab. 7Vaccinazioni contro la Blue Tongue
Tab. 8Piano Nazionale Residui
Tab. 9Ripartizione del raccolto mele 2022 e 2023 in Alto Adige (in tonnellate)202
Tab. 10 Prezzi medi al produttore per il raccolto di varietà da tavola 2022 e 2023
Tab. 11 Situazione dello schedario viticolo 2023 in ettari e %
Tab. 12 Superficie coltivata e produzione orticola nell’anno 2023
Tab. 13 Export di mele verso Paesi terzi 2019 – 2023 (in tonnellate)207
Tab. 14 Comuni con casi accertati di Colpo di fuoco batterico 2023
Tab. 15 Il parco macchine dell’Alto Adige208
Tab. 16 Trattrici nuove 2023
Tab. 17 Utilizzarzioni legnose per ispettorati forestali 2023
Tab. 18 Specie arboree assegnate al taglio nell’anno 2023
Tab. 19 Progetti realizzati in economia 2023: per tipologie di lavorirealizzate e per ispettorati
Tab. 20 Panoramica del pano di gestione forestale
Tab. 21 Vendita prodotti secondari 2023
Tab. 22 Listino prezzi 2023 Seheria Latemar
Tab. 23 Diplomati/e per settore – 2022/2023
Tab. 24 Totale allieve/e – 2022/2023
Indice
Fig. 1Commercializzazione del bestimae – prezzi alle aste
Fig. 2Numero di aziende bovinenelle quali vengono prelevati campioni sullatte di massa 199
Fig. 3Vitelli con campione di cartilagine auricolare 199
Fig. 4Bovini esaminati per Blue Tongue 200
Fig. 5Numero aziende sottoposte a controllo per lentivirus durante le campange di profilassi 200
Fig. 6Numero di caprini esaminati per lentivirus nel corso delle campagne di profilassi 201
Fig. 7Percentuale delle aziende con positività al lentivirus durante le campagne di profilassi 201
Fig. 8Percentuale dei caprini con positività al lentivirus nelle campagne di profilassi 201
Fig. 9 Produzione di vinonegli anni 2000 – 2023 (etto litri)
Fig. 10 Media CV delle trattrici nuove
Fig. 11 Produzione di legname 2022/2023
Fig. 12 Segheria Latemar: Prezzi del I e IV assortimento abete rosso Latemar
Fig. 13 Corsi di lavoro boschivo dal 2016 al 2023
Fig. 14 Scuola forestale Latemar – numero e percentuale corsi218
Fig. 15 Scuola forestale Latemar – numero e percentuale giornate corsi
Fig. 16 Scuola forestale Latemar – numero e percentuale partecipanti
Fig. 17 Scuola forestale Latemar – numero e percentuale di giornate di partecipazione ai corsi
Fig. 18 Scuola forestale Latemar – percentuale pasti
Fig. 19 Scuola forestale Latemar – percentuale pernottamenti
Fig. 20
dal 2012/2013 al 2023/2024

Tab. 1: Patrimonio zootecnico in Alto Adige 2023
I dati fra il censimento agricolo 2010 e quelli censiti nel 2023 differiscono per il motivo che tante aziende agricole con attività secondarie non sono state rilevate nell’ambito del censimento agricolo.
Fig. 1: Commercializzazione del bestiame – prezzi alle
Il seguente grafico rappresenta i prezzi medi realizzati alle aste zootecniche dall’anno 2020 al 2023 per le razze Bruna, Pezzata Rossa, Holstein e Grigio Alpina.
Tab. 2: Animali da macello e vitelli da ingrasso – prezzi medi 2022 e 2023
Kategorie
* SQF-animali: sistema qualità carne
I prezzi medi per bovini durante l’anno 2023 erano
attraverso l’asta di bestiame.
Tab. 3: Interventi di fecondazione artificiale 2021 – 2023
Tab. 4: Stazioni di mona 2023

Per le razze ovine “Pecora Tirolese bruno-nera”,“Pecora tipo Lamon”, “Pecora della Val Senales” e “Pecora della roccia” viene concesso il premio agli allevatori per la conservazione dell’agro biodiversità ai sensi del Regolamento UE n. 2021/2115

Prevenzione a malattie infettive I campioni sullatte di massa delle aziende bovine conferenti il latte rappresentano un metododi analisi molto economico.
2: Numero di aziende bovinenelle quali vengono prelevati campioni sullatte di massa
Diarrea Virale Bovina Mucosal/Disease
I vitelli neonati vengono controllati relativamente alla Diarrea Virale Bovina (BVD) mediante il prelievo di un campione di cartilagine auricolare delle dimensioni di 3 mm. I marcatori prelevano i campioni dai vitelli al momento dell’apposizione della marcaauricolare, entro le prime tre settimane di vita degli animali. I bovini positivi per il virus BVD vengono di regola immediatamente condotti alla macellazione.
3: Vitelli con campione di cartilagine auricolare
Malattia della lingua blu (Blue Tongue)
Il Regolamento di Esecuzione (UE) 2021/620 della Commissione del 15 aprile 2021 recante modalità di applicazione del regolamento (UE) 2016/429 del Parlamento europeo e del Consiglio per quanto riguarda l’approvazione dello status di indenne da malattia e dello status di zona di non vaccinazione di alcuni Stati membri o di loro zone o compartimentiin relazione adalcune malattieelencate e all’approvazione dei programmi di eradicazione per tali malattie elencate considera l‘Alto Adige una zona indenne dalla malattia dellalingua blu(Blue Tongue).
Fig. 4: Bovini esaminati per Blue Tongue
Tab. 7: Vaccinazioni contro la Blue Tongue
Artrite-encefalite dei caprini
Durante la campagna di profilassi, eseguita dall’anno 2021 da gennaio a novembre e prima da novembre a marzo, tutte le aziende caprine vengono sottoposte a controllo relativamente alla Artrite-encefalite dei caprini (CAEV), causato da diversi tipi di lentivirus.
Fig. 5: Numero aziende sottoposte a controllo per lentivirus durante le campagne di profilassi
* dal 2021 i dati si riferiscono all’anno solare, i dati
Fig. 6: Numero di caprini esaminati per lentivirus nel corso delle campagne di profilassi
* dal 2021 i dati si riferiscono all’anno solare, i dati precedenti all’arco tra novembre e marzo
Fig. 7: Percentuale delle aziende con positività al lentivirus durante le campagne di profilassi
* dal 2021 i dati si riferiscono all’anno solare, i dati precedenti all’arco tra novembre e marzo
Fig. 8: Percentuale dei caprini con positività al lentivirus nelle campagne di profilassi
* dal 2021 i dati si riferiscono all’anno solare, i dati precedenti all’arco tra novembre e marzo
Nel piano di eradicazione della CAEV rientrano solo i caprini che reagiscono positivamente al Tipo B1 dellentivirus.
Tab. 8: Piano Nazionale Residui
In base al Piano Nazionale Residui (PNR) sono stati prelevati dal Servizio Veterinario dell’Azienda Sanitaria dell’Alto Adige presso macelli ed allevamenti zootecnici, da animali vivi e da prodotti carnei, prodotti lattiero-caseari, prodotti ittici e miele, i seguenti campioni:

Tab. 9: Ripartizione del raccolto mele 2022 e 2023 in Alto Adige (in tonnellate)
Tab. 10: Prezzi medi al produttore per il raccolto di varietà da tavola 2022 e 2023


Fig. 9: Produzione di vinonegli anni 2000 – 2023 (ettolitri)


Tab. 12: Superficie coltivata e produzione orticola nell’anno 2023, che viene commercializzata dalle più importanti cooperative della Provincia coltura
4,21.617 romanesco, cavolo a punta, cavolo rosso, pak choi 5,21.285 zucca 1,6229 altre verdure/insalate (sedano, finocchio, cipolla, Eisberg, e. a.)
2,9390
289,393.710 * 106 ettari patate da seme (produzione Cooperativa Sementi della Val Pusteria)



Tab. 16: Trattrici nuove 2023

Tante marche di trattori, commercializzatiin Alto Adige, appartengono a concerni mondiali (ad esempio: AGCO, ARGO TRAKTORS, CNH, JOHN DEERE, KUBOTA, SDF).
10: Media CV delle trattrici nuove
Osservando la media dei CV si nota un crescendo di potenza verso i 54 CV dal 1951 fino agli anni ottanta, con un leggero ribasso verso il 1985.
La media dei CV è salita continuamente a raggiungere il massimo nel 2022 di 98,07 CV. L’estrapolazione dei dati sia per le marche, come anche per la media dei CV è stata effettuata esclusivamente dalle pratiche di immatricolazione
l’Ufficio

* dati aggiornati al 31 dicembre 2023 ** incl Agenzia Demanio provinciale
Tab. 18: Specie arboree assegnate al taglio nell‘anno 2023 Massa complessiva assegnata nell‘anno 2023*: 1.713.514 mcl
Pino silvestre1,6
*dati aggiornati al 31 dicembre 2023



Costruzione di trepiedi fermaneveManutenzione chiudendeManutenzionerete sentieristica



3.2.2
Tab. 19: Progetti realizzati in economia 2023: per tipologie di lavori realizzate e per ispettorati tipologie di lavorirealizzati
Sistemazione a scopo prottettivo del suolo (stabilizzazione pendii & protezione dalle valanghe)
Costruzione di murata (di controripa-, di pietrame con malta cementizia,- a secco)
7342 Costruzione di terre armate (Geotex) 793 m³ 83
Protezione per caduta massi con rete a maglia 0 m³
Sistemazione pendii (vari sistemi)
Rinverdimento pendii & piantagione pendii (semina, idrosemia, talee, ...)
Costruzione di rastrelliere paravalanghe in legname 2,220 lfm672 60 1.088400
Costruzione di pontili paravalanghe (in legname, in metallo)
Costruzione reti paravalanghe 0 lfm
Costruzione di trepiedi fermaneveNr. 3419 50
Manutenzione di rastrelliere paravalanghe 132 lfm24108
Risanamento bosco protettivo
Sfollamento/Diradamento22 ha 82 93 Cura e formazione collettivi & recinti2 ha 2
Realizzazione collettivi recintati abbinati con rimboschimento
Taglio trasversale con/senza esbosco legname7 ha 34
Scortecciamento di ceppaie tagliate in alto (> 30 cm) 0
Protezione rinnovazione - Protezione singola per piantine 1 ha1
Trattamento con repellente antiselvaggina 24 ha
Rimboschimento & cure selvicolturali
Rimboschimento piantine (numero piantine messe a dimora)
Curerimboschimenti (taglio erbe infestanti, irrigazione piantine, concimazione piantine, trattamento rep. antiselvaggina) 34 ha
Diradamento20 ha 10
Rivitalizzazione ceduo14 ha 14
Apertura del cotico a piazzole
Chiudende & Regolamentazione pascolo nei boschi
chiudende di protezione antiselvaggina
Costr. aree di protezione antiselvaggina recintate (< 1 ha) Nr
Riparazionee manutenzione chiudende (chiudende
Costruzione trogoli di legno114 lfm41252
Misure a tutela del bosco
Cure selvicolturali per motivi fitosanitari 6 ha 33
Aumento resilienza/trasformazione in popolamenti misti - Introduzione di latifoglie 0 ha Trasformaz. popolamenti - impianto nuclei di latifoglie 0 ha
strade
strade forestali (strade camionabili & strade trattorabili)
Misure di miglioramento paesaggistico Manutenzione
Messa in opera di infrastrutture sentieristiche Nr 221 31 1113
Redazione piani di gestione
Elaborazione/stesura piano di gestione Nr 11
Infrastrutture antincendio & condutture dell‘acqua
Costr. di condotte d‘acqua/canali di irrigazone 1.330 lfm255
Costr. di bacini di raccolta/antincendioNr. 54 1
Manutenzione condotte d‘acqua/canali di irrigazione 20.332 lfm100 54
Risanamento/Manutenzione bacini di raccolta/ antincendio Nr 114 96 117
Demolizione di vecchie condotte 0 lfm
Misure protettive delle greggi
Costruzione chiudende a difesa del bestiame 500 lfm500
Risanamento e ripristino di elementi culturali del paesaggio
Messa in opera muri in petrame a secco 1.652 m³
Manutenzione muri in peitrame a secco 750 m³
selciato
Miglioramento paesaggistico & miglioramento di habitat Cure di
Misure di contenimento
Altri lavori
Messa in opera combinazione tavolo-panchinaNr. 124377 10 2327 218
Messa in opera panchine in legnameNr. 11315 13 34 8376
Ceduo a capitozza (p.e. pioppi, salici,...) Nr 47 39 8
3.2.2

Tab. 21: Vendita prodotti secondari 2023

Abete rosso Latemar IV
Fig. 12: Segheria demaniale Latemar: Prezzi del I e IV assortimento abete rosso Latemar Fig. 13: Corsi di lavoro boschivo dal 2016 al 2023
Abete rosso LatemarI

Settore venatorio (tedesco)
Settore venatorio (italiano)
Settorerip. foreste
Settore ed ambientale
Settore utilizzo del legno
Corsi lavori boschivi
Altre manifestazioni
Settore venatorio (tedesco)
Settore venatorio (italiano)
Settorerip. foreste
Settore ed ambientale
Settore utilizzo del legno
Corsi lavori boschivi
Altre manifestazioni G.C.
Settore venatorio (tedesco)
Settore venatorio (italiano)
Settorerip. foreste
Settore ed ambientale
Settore utilizzo del legno
Corsi lavori boschivi
Altre manifestazioni
17: Scuola forestale Latemar – numero e percentuale di giornate di partecipazione ai corsi
Settore venatorio (tedesco)
Settore venatorio (italiano)
Settorerip. foreste
Settore ed ambientale
Settore utilizzo del legno
Corsi lavori boschivi
Altre manifestazioni
18: Scuola forestale Latemar – percentuale pasti
Settore venatorio (tedesco)
Settore venatorio (italiano)
Settorerip. foreste
Settore ed ambientale
Settore utilizzo del legno
Corsi lavori boschivi
Altre manifestazioni
19: Scuola forestale Latemar – percentuale pernottamenti
Settore venatorio (tedesco)
Settore venatorio (italiano)
Settorerip. foreste
Settore ed. ambientale
Settore utilizzo del legno
Corsi lavori boschivi
Altre manifestazioni
3.3
Fig. 20: Evoluzione numerica alunni dal 2013/2014 al 2022/2023
–
23:



Provincia Autonoma di Bolzano – Alto Adige Dipartimento Agricoltura, Forestee Turismo Palazzo 6, Via Brennero 6, 39100 Bolzano, Tel. +39 0471 415 000
Ripartizione Agricoltura www.provincia.bz.it/agricoltura
Ripartizione Foreste www.provincia.bz.it/foreste
Centro di Sperimentazione Laimburg www.laimburg.it
Direzione provinciale
Formazione professionale in lingua tedesca http://www.provinz.bz.it/formazione-professionale
Agenzia Demanio provinciale https://demanio.provincia.bz.it
Libera Università di Bolzano www.unibz.it
Redazione
Angelika Aichner Kössler, Johanna Höller, Angelika Blasbichler, Heike Platter, Matthias Gauly
Se non indicato esplicitamente, le immagini utilizzate sono state messe a disposizione dalle singole ripartizioni, agenzie provinciali e istituzioni di ricerca, dall’Agenzia immagine www.shutterstock.com, www.pixabay.com, www.freepik.com - singole foto dalla Consulenza per l’agricoltura montana, Fürstenburg srl, Centro di Consulenza per la fruttiviticoltura dell’Alto Adige, Associazione delle Donne Coltivatrici Sudtirolesi, Associazione Giardinieri Alto Adige, Consorzio Vini Alto Adige, I Giardini di Castel Trauttmansdorff/Marion Lafogler (p 129)/Matteo Olivo (p 129)/Alexander Schechinger (p 130)/ Karlheinz Sollbauer (p 128), Philipp Unterholzner (p 129), VOG - Consorzio delle Cooperative Ortofrutticole dell’Alto Adige, Francesco Grazioli, Marion Lafogler, Agenzia di stampa e comunicazione/Maja Clara, Josef Telfser, Philipp Santifaller e www.flickr.com/photos/tambako/, Focusnatura, Andreas Platzer, Gallo Rosso/Frieder Blickle, Federazione Latterie Alto Adige, Manuel Kottersteger, Maschinenring Südtirol, Othmar Seehauser, Oskar Da Ritz, Südtiroler Landwirt, IDM Alto Adige/Frieder Blickle, Florian Andergassen, Alexander Schechinger, Matteo Olivo, Marion Lafogler, Federazione Energia Alto Adige, VIP/Julia, Lesina Debiasi, IDM Südtirol-Alto Adige/Helmut Rier/Frieder Blickle/Manuel Ferrigato, IDM Südtirol-Alto Adige/ Dietmar Denge/Tobias Kaser/Frieder Blickl, Eurac Research/Martina Jaider, Raiffeisenverband Südtirol, Südtiroler Bauernbund, Verein der Absolventen Landwirtschaftlicher Schulen, Bioland Südtirol, VOG Products, Laimburg Research Centre/Laimburg Research Centre/Ivo Corrà (p. 3, 5, 6, 8, 9, 14, 17, 20, 21, 23)/A. Seppi (p. 2)/Alex Rehbichler (p. 20)/andreas tauber, LPA/Tiberio Sorvillo, LPA/Trenkwalder, Agentur für Bevölkerungsschutz, Bioland Südtirol, Uli Mayer-Johanssen GmbH, IDM/Andreas Miersa, LPA/G.News, Noi Techpark/Daniele Fiorentino (p 17), Condifesa Bolzano/Fabian Dalpiaz, Oliver Oppitz, Ortsgruppe Feldthurns, VI.P Gen.landw. Gesellschaft, Joachim Schmuhl, SBR - Eugen Tumler, Joos Armin, Wellenzohn Paul, berghof-martelltal.com, Consiglio della Provincia autonoma di Bolzano.
Layout
Ferrari-Auer Druck
Via Cappuccini 7/9, 39100 Bolzano
T +39 0471 081800, www.athesiadruck.com
Athesia Druck Srl, Via dei Vigneti 7, 39100 Bolzano
PEFC/18-31-166

